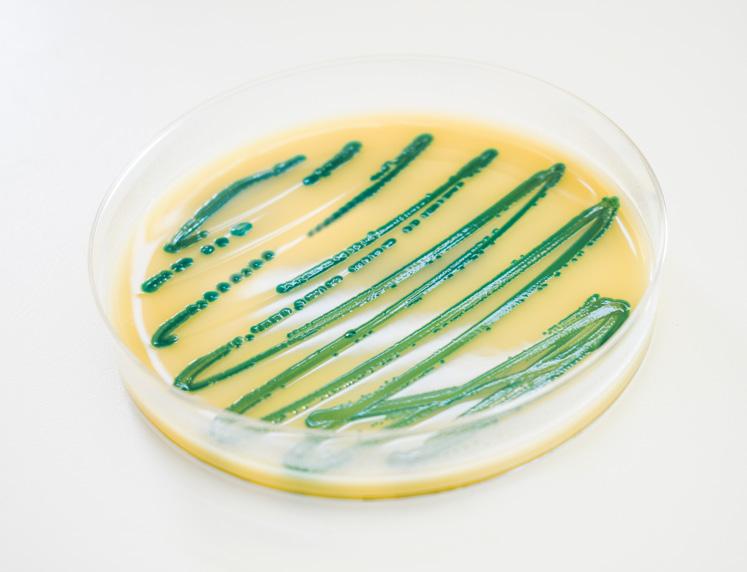

Let’s talk about Let’s talk about
SEGURIDAD SAFETY
Higiene en el Food & Beverage
Hygiene in Food & Beverage
TECNOLOGÍA TECHNOLOGY
Digitalización en hostelería
Digital tools in hospitality
PANORAMA OUTLOOK
Limpieza en el 2024
2024 trends in cleaning industry
Monthly magazine for industrial sanitization and environmental hygien e S U P P L E M E N T T O D IME N S IO N E P U L ITO N O 2 - 2 0 2 4 Mont h l y m a g azine fo r in du strial saniti z ation an d envi r onmental h y gien e
dimensionepulito.it
Follow US
english spanish text
















MADE IN ITALY www.rubinochem.it *Mechanical removal of germs and bacteria is not a biocide, it is a sanitizing detergent. Available in 24 inimitable fragrances unique, unmistakable... the original! unique, unmistakable... the original!

Sustainable cleaning goals - Fimap’s journey

FOver the past year, Fimap has reached a number of new milestones in its quest for sustainability, with both the company and the products achieving recognition.

rom ISO 14064-1:2018 certification to the EcoVadis Gold Medal and the ReMade in Italy recycled plastic certification, Fimap has demonstrated clear intentions with regard to how the company will pursue the directives set out in the 2030 Agenda.
These achievements, along with the previous goals and certifications attained, cannot be improvised: rather, they are results that are reached over time, through the adoption of a method that starts upstream, taking all possible consequences for the environment into consideration.
SUSTAINABILITY BEGINS WITH AN IDEA
The impact of the products manufactured is largely dependent on decisions made at the design stage. This is where we establish how to make a durable product that is easy to maintain and repair. This is where the materials are chosen, where any recycled parts are integrated, and where disposal is facilitated. And it is also the moment at which we look at not only how to make a product easy to use, but above all, how to make it easy to use in an efficient manner, whilst saving resources.
All of these assessments are essential, because peak improvement can only be achieved if the entire life cycle of the machine is taken into account; as such, it is a process that involves all parties, from the suppliers to the end users.
CERTIFIED RECYCLED PLASTICS
Fimap has worked with its suppliers to implement a project designed to recover plastic waste and turn
it into a valuable resource. This led to the creation of our recycled plastics, which have subsequently received ReMade in Italy certification.
Meanwhile, in order to involve the end users of the machine, it is necessary to focus on the activity phases, which include both use and maintenance.
The support of technology which is both accessible and dynamic enables users to draw maximum benefit, taking advantage of the machine’s features and changing their behaviours, and as a result, their cleaning style.
Accordingly, users are drawn to make more responsible choices, facilitated by Fimap.
All it takes is the push of a button to reduce the use of resources, recycle these and activate complete work programmes that prevent waste.
Proper maintenance is all it takes to keep the machine in optimal condition and extend its working life. In order to avoid mistakes, the user can also access on-board video tutorials.
Having analysed the life cycle and identified the areas for improvement, Fimap has succeeded in designing an environmentally-friendly product and developing upstream solutions that ensure that it continues to be sustainable during use once in the hands of the customer.
NEW TECHNOLOGIES FOR SAVING RESOURCES
It is therefore clear that buying a Fimap product also signifies accepting a new way of working, rendered more efficient by technology, which anyone can put into practice, precisely because it is so simple: the touch of a button is all that is required.
Throughout its history, Fimap has always sought to go above and beyond, offering technological
solutions designed to protect the environment and resources. This year, the company’s innovations are focused on water, with AQUÆ® technology, and air, with Safe Air technology.
FOR DETERGENT-FREE CLEANING
AQUÆ® aims to eliminate the use of detergents. A cleaning and sanitising solution with a longlasting effect is obtained simply by activating the chlorine in softened tap water. This prevents all of the pollution generated by the use of detergents, from the plastic used to contain it to its transportation and the surfactants released in waste water.
The sheer breadth of application makes this technology even more extraordinary: it is perfect for the daily and maintenance cleaning of buildings, which constitutes around 90% of operations in the professional cleaning sector.
BETTER QUALITY OF THE AIR RETURNED TO THE ENVIRONMENT
Meanwhile, the Safe Air technology is designed for sweeping machines, with a view to improving the quality of the air in the spaces being cleaned, so that they are safer for the people who spend time in these environments.
Once sucked into the system, the air passes through several types of filter, which retain increasingly small dust particles, right down to 0.3 µm: these are captured by the Hepa filter, which has a filtration efficiency of 99.9%.
world A NEW GENERATION MACHINES COMMITTED TO ZERO EMISSIONS
ENVIRONMENT


FFM - FIMAP FLEET MANAGEMENT ENVIRONMENTAL IMPACT CONTROL
One element that Fimap has never underestimated is control. Since its introduction, the FFM - Fimap Fleet Management system has provided customers with the ability to remotely monitor cleaning operations, enabling them to see how these are being performed without needing to be present. It is the most accurate tool for obtaining detailed information on the machines, from the way they are used to their consumption of resources and the CO2 produced by each operation. These data constitute an essential foundation for creating strategies for improvement, and in the specific case of CO2, to implement steps to compensate and neutralise this.
Today, the system is even more advanced, with two new functions: INDOOR TRACKING and MISSION CONTROL PART PROGRAM. The first function tracks the movements of the machine within buildings, so that supervisors can see which spaces have already been cleaned and which are still to be completed, as well as staying up-to-date on the progress of the cleaning plan. Meanwhile, the Mission Control Part Program enables a
weekly cleaning schedule to be set and sent to the machine. Any operator tasked with carrying out the cleaning operation simply needs to press the button that lights up on the display in order to start the machine with the set parameters. It prevents incorrect settings as well as the misuse and waste of resources. It also avoids the need for training, with the associated time and costs.
CERTIFYING THE LIFE CYCLE OF THE PRODUCT
Carbon Footprint of the Product, CFP 14067:2018 Systematic Approach
In the life cycle analysis, the use phase has always been the most difficult to ascertain, due to the wide range of variables. The synergy between environmental technologies and the FFM system has made it possible to recover this piece of the puzzle, completing the analysis with scientific, verifiable data. This has led to the achievement of CFP - Carbon Footprint of Product Systematic Approach certification for scrubbing machines, used to calculate the amount of CO2 produced by the individual machine per hour of work, obtaining a certified figure in line with ISO 14067:2018.


CERTIFYING THE ENVIRONMENTAL PROCESSES
Carbon Footprint of the Organisation, 14064-1:2018
Certifications enable internal progress to be communicated externally using a shared language. Customers are increasingly focused on the environmental value of a given product and company, and seek certifications as tangible evidence. These certifications link the efforts of bodies, companies, suppliers and end users, as they work together to achieve the goals of the 2030 Agenda.
Fimap’s unwavering focus on these issues over the years has led to the company being awarded the EcoVadis Gold Medal, which recognises the excellent performance across the company, as well as the CFO - Carbon Footprint of Organisation evaluation, which certifies greenhouse gas reporting in accordance with ISO 14064-1:2018.
SUSTAINABILITY REPORT
Each individual certification, from those pertaining to products to those regarding the company, represents a specific point of view on sustainability. As such, Fimap has decided to offer an overview of everything it has attained, voluntarily compiling its first Sustainability Report, which describes the company’s achievements and maps out the goals that await it in the near future, declaring its commitment to continue to improve by following the objectives of the 2030 Agenda.

world
www.fimap.com ENVIRONMENT ENVIRONMENTAL IMPACT MONITORING TO CLEAN WITHOUT DETERGENT IMPROVED AIR QUALITY CERTIFIED RECYCLED PLASTIC EFFICIENT ENERGY USE Watch the video AQUÆ® ISO 14064-1:2018
ISO 14067:2018
CARBON FOOTPRINT OF ORGANIZATION
Read the Sustainability Report Visit us at INTERCLEAN Amsterdam Netherlands - RAI Amsterdam 14/17 May 2024 Hall 1 Booth 01.421B
CARBON FOOTPRINT SYSTEMATIC APPROACH








Editor-In-Chief Giorgio Albonetti
Editorial director Ornella Zanetti | ornella.zanetti@quine.it
Technical director Maurizio Pedrini
Editorial coordination
Chiara Scelsi - c.scelsi@lswr.it | Ph. +39 349 0099322
Editors Loredana Vitulano - l.vitulano@lswr.it
Ph. +39 342 6618995
Cristina Cardinali - c.cardinali@lswr.it Ph.+39 347 4238879
Simone Ciapparelli - s.ciapparelli@lswr.it Ph. +39 344 0571950
Technical
Dassi - Graziano Dassi
Circulations and subscription service
Ornella Foletti - o.foletti@lswr.it | Ph. +39 342 7968897


Advertising and development dircom@quine.it Filippo Viola - f.viola@lswr.it Guido Rossi - g.rossi@lswr.it



EN LA TAPA/COVER
Industrie Celtex es una empresa multinacional que opera en Italia y Europa, especializada en la producción de productos de papel tisú y sistemas de dispensación para el sector Away from Home, con nueve plantas de producción europeas y más de 500 empleados. Una multinacional que persigue la calidad, la innovación y la sostenibilidad.
Industrie Celtex is a multinational company operating in Italy and Europe, specialized in production of tissue paper products and dispensing systems for Away from Home Sector, with nine European production plants and over 500 employees. A multinational company that pursues quality, innovation and sustainability.



Edoardo Rossi - e.rossi@lswr.it


Elena Brusadelli - e.brusadelli@lswr.it



Graphic design
Paolo Marchetti
Production manager

Antonio Iovene - a.iovene@lswr.it | Ph. +39 349 1811231

Let’s talk about CLEANING Supplement to Dimensione Pulito No 2 March 2024 www.dimensionepulito.it




Printing Tipolitografia Pagani – Passirano (BS)
Prices and subscriptions
• Annual subscription: 49 euro
• Subscription outside Italy: 160 euro
• Back copies: 17 euro
• Cost of a copy: 1.30 euro abbonamenti.quine@lswr.it | Ph. +39 02 864105 www.quine.it


Dimensione
10
COLLABORADORES/COLLABORATORS
Cristina Cardinali, Simone Ciapparelli, Francesca De Vecchi, Massimo Artorige Giubilesi, Marco Monti, Maurizio Pedrini, Francesco Pirovano, Michele Ruzza, Giacomo Torrenzi, Loredana Vitulano
SEGURIDAD ALIMENTARIA FOOD SAFETY

www.dimensionepulito.it
Responsibility



18



28


Higienización ambiental y alimentaria segura, eficaz, validada Environmental and food sanitation: safe, effective, validated Massimo Artorige Giubilesi
Método de “Seek and Destroy” contra L. monocytogenes
“Seek and Destroy” method against L. monocytogenes



Francesca De Vecchi

HIGIENE EN LA COCINA KITCHEN HYGIENE
La limpieza vista por los cocineros Cleanliness as seen by chefs Maurizio Pedrini
HACCP
Gestión de plagas en Ho.Re.Ca. Pest management in Ho.Re.Ca Michele Ruzza


Índice/Contents
Monthly magazine pubished by Quine Srl Via
Spadolini,
+39
G.
7 - 20141 Milano www.quine.it | info@quine.it | Ph.
02 864105
section Environmental hygiene Chiara
scientific consultants for the
Authorization
registered
Register of Communication
The publication
reprint of articles
images must be authorized in
by the publisher.
articles published
responsibility
the authors.
manuscripts
drawings will
be returned.
Pulito is a Monthly Recorded Periodic:
of the Court of Milan No. 598 of 9.11.92 Quine is
in the Operators
n. 12191 of 29/10/2005.
or
and
writing
The
on Dimensione Pulito are under the
of
Published
and
not
INFORMATION PURSUANT TO GDPR 2016/679
of Personal
readers
processed
will
used
publications
information
promotional material. The methods of treatment will comply with the provisions of art. 5-6-7 of the GDPR. Data may be disclosed to subjects with whom Quine Srl maintains contractual relationships necessary for sending copies of the magazine. The data controller is Quine Srl, Via G. Spadolini 7 - 20141 Milan, to which the reader can turn to request the update, integration, cancellation e any other operation referred to in articles 15-21 of the GDPR. © Quine srl - Milan Testata Associata Distribution Quine srl Via G. Spadolini, 7 20141 Milano - Italia Tel. +39 02 864105 Fax. +39 02 70057190 LA GUIDA DA PORTARE SEMPRE CON SÉ PER CONOSCERE TUTTI TRUCCHI DEL MESTIERE LA DISTRIBUZIONE NEGLI IMPIANTI DI RISCALDAMENTO GUIDE dell’Installatore Professionale 7 YOUR INFORMATION PARTNER QUINE COLLABORA CON: www.quine.it Organo ufficiale AiCARR LA RIVISTA PER PROFESSIONISTI DELL’HVAC&R LA RIVISTA PER PROFESSIONISTI DEGLI IMPIANTI HVAC&R Organo Ufficiale AiCARR NORMATIVA Panoramica di inizio anno TAVOLA ROTONDA Conto Termico TEE. che punto siamo? DALLA TEORICA ALLA PRATICA EPB, LE NOVITÀ DELLE NUOVE NORME IMPIANTI AD ARIA PRIMARIA VS VAV FOCUS COMMISSIONING Analisi del processo case study FILTRAZIONE E QUALITÀ DELL’ARIA SOTTORAFFREDDAMENTO ADIABATICO PER LA #42 COMMISSIONING RISPARMIO ENERGETICO NEL TERZIARIO Organo ufficiale ANGAISA LA VOCE PIÙ AUTOREVOLE DEL SETTORE IDROTERMOSANITARIO #251 Bosch riparte CLASSIFICHE 2015 Produttori e distributori: ce la si può fare! FALANGA Quando la differenza TREND bagno che calza pennello www.bluerosso.it LA VOCE AUTOREVOLE DEL CANALE IDROTERMOSANITARIO PIÙ DINAMICA LA PIATTAFORMA ITALIANA DELLA PRODUZIONE MUSICALE E DELL’AUDIO PROFESSIONALE www.audiofader.com WEBSITE AGGIORNATO MAGAZINE MENSILE DIGITALE IVO GRASSO e MASSIVE ARTS Lo studio di modernoregistrazione SALVATORE ADDEO L’amore per l’SSL ALTERNATIVI principi programmazione AVID PRO TOOLS DOCK soluzione per tutti IL PUNTO DI RIFERIMENTO PER CHI OPERA NEL CAMPO DELLA PULIZIA INDUSTRIALE, SANIFICAZIONE E FACILITY MANAGEMENT www.pulizia-industriale.it DA 50 ANNI LA VOCE AUTOREVOLE DEL CLEANING www.casaeclima.com L’INFORMAZIONE EFFICIENTE, COMPLETA E IN TEMPO REALE OLTRE 200.000 UTENTI MESE Organo ufficiale FINCO LA RIVISTA CHE HA PORTATO LA PROGETTAZIONE SOSTENIBILE IN ITALIA MEDAGLIE D’ORO STORIA ITER PROGETTUALE DA NON SOTTOVALUTARE Passo obbligato grande opportunità A SCUOLA DI EFFICIENZA N. 64 Anno dicembre 2016 www.commercioelettrico.com Organo ufficiale FME IL BUSINESS MAGAZINE DEI DISTRIBUTORI E GROSSISTI DI MATERIALE ELETTRICO DAL 1952 IL PERIODICO D’INFORMAZIONE PER INGEGNERI E ARCHITETTI NEWSLETTER – L’AGGIORNAMENTO PROFESSIONALE VIA MAIL Ogni 15 giorni raggiunge oltre 42.000 iscritti R FOCUS SPECIALE Innovazione e cambiamento Un CNI eletto per dare risposte O miliardo per città In USA volano le infrastrutture Eucentre per ricostruire la sicurezza Ancora trattative consultazioni? I pareri degli Ordini dopo l’esito del referendum del dicembre Newsletter QUOTA RINNOVABILI EDIFICI obblighi e proroghe SCIA, operativo il modello unico Tutti rinvii SPECIALE MILLEPROROGHE Top 7 infrastrutturemegadel 2016 LA RIVISTA PER PROGETTARE LA SMART INDUSTRY Organo ufficiale Confapi INFORMAZIONE TECNICO SCIENTIFICA PER LE PMI www.rivistainnovare.it SUBFORNITURA E –------ma d u o---www.ammonitore.com MENSILE DI FORMAZIONE E AGGIORNAMENTO PER IL MECCATRONICO www.MTEDocs.it INFORMAZIONE TECNICHE PER L’AUTORIPARAZIONE MECCANICA&AUTOMAZIONE PERIODICO BUSINESS TO BUSINESS NEL MONDO DELL’INDUSTRIA MECCANICA E DELLE MACCHINE UTENSILI #4maggio 2016 STORIA DI COPERTINA CAD/CAM unico per settore Lamiera IN QUESTO NUMERO INTERVISTA da quarant’anni Generative design, come Sempre più centro www.meccanica-automazione.com IL PORTALE CHE TI GUIDA VERSO LA SMART INDUSTRY TUTTI VOLTI E LE AZIENDE www.terminidellameccanica.com IL TRADUTTORE MULTILINGUE DELLA MECCATRONICA URBAN & PARTNER MILANO (I) WRODAW (PL) GALLARATE (I) PIACENZA (I) TIRANA (AL) SARAGOZZA (ES) MILANO (I) Quine srl Via G. Spadolini, 7 20141 Milano - Italia Tel. +39 02 864105 Fax. +39 02 70057190 YOUR INFORMATION PARTNER QUINE COLLABORA CON: www.quine.it DELL’HVAC&R 42 Organo ufficiale ANGAISA LA VOCE PIÙ AUTOREVOLE DEL SETTORE IDROTERMOSANITARIO Poste italiane Target Magazine LO/CONV/020/2010 Omologazione DCOCI0168 #251 da… Bosch CLASSIFICHE 2015 Produttori e distributori: ce la si può fare! ANTONIO FALANGA Una passione sempre viva DISTRIBUZIONE Quando differenza TREND bagno che ti calza pennello FOCUS Un anno di logistica www.bluerosso.it LA VOCE AUTOREVOLE DEL CANALE IDROTERMOSANITARIO PIÙ DINAMICA LA PIATTAFORMA ITALIANA DELLA PRODUZIONE MUSICALE E DELL’AUDIO PROFESSIONALE www.audiofader.com WEBSITE AGGIORNATO QUOTIDIANAMENTE MAGAZINE MENSILE DIGITALE IVO GRASSO e MASSIVE ARTS Lo studio di modernoregistrazione SALVATORE ADDEO L’amore per l’SSL principi programmazione AVID PRO TOOLS DOCK la soluzione per tutti IL PUNTO DI RIFERIMENTO PER CHI OPERA NEL CAMPO DELLA PULIZIA INDUSTRIALE, SANIFICAZIONE E FACILITY MANAGEMENT www.pulizia-industriale.it DA 50 ANNI LA VOCE AUTOREVOLE DEL CLEANING www.casaeclima.com L’INFORMAZIONE EFFICIENTE, COMPLETA E IN TEMPO REALE OLTRE 200.000 UTENTI MESE Organo ufficiale FINCO LA RIVISTA CHE HA PORTATO LA PROGETTAZIONE SOSTENIBILE IN ITALIA SAIE INNOVATION 2016 FOTOVOLTAICO INTEGRATO UNA SCELTA Passo obbligato grande opportunità A SCUOLA DI EFFICIENZA 64 Anno dicembre 2016 www.commercioelettrico.com Organo ufficiale FME IL BUSINESS MAGAZINE DEI DISTRIBUTORI E GROSSISTI DI MATERIALE ELETTRICO IL PERIODICO D’INFORMAZIONE INGEGNERI E ARCHITETTI L’AGGIORNAMENTO PROFESSIONALE VIA MAIL raggiunge oltre 42.000 iscritti FOCUS politico barcolla, alta l’attenzione sul governo degli ingegneri eletto per dare risposte In USA volano le infrastrutture Eucentre per ricostruire la sicurezza Ancora trattative e consultazioni? Newsletter Programma Corsi di Aggiornamento Professionale RINNOVABILI EDIFICI obblighi e proroghe → pag.37 → pag.3 modellooperativo unico Tutti rinvii SPECIALE MILLEPROROGHE Top infrastrutturemegadel 2016 LA RIVISTA PER PROGETTARE LA SMART INDUSTRY Organo ufficiale Confapi INFORMAZIONE TECNICO SCIENTIFICA PER LE PMI www.rivistainnovare.it MENSILE PER LA SUBFORNITURA E LA PRODUZIONE INDUSTRIALE –-----------–------c n e p m d t---www.ammonitore.com MENSILE DI FORMAZIONE E AGGIORNAMENTO PER IL MECCATRONICO www.MTEDocs.it INFORMAZIONE TECNICHE PER L’AUTORIPARAZIONE MECCANICA&AUTOMAZIONE PERIODICO BUSINESS TO BUSINESS NEL MONDO DELL’INDUSTRIA MECCANICA E DELLE MACCHINE UTENSILI #4maggio 2016 STORIA DI COPERTINA CAD/CAM unico per settore Lamiera IN QUESTO da quarant’anni Generative design, come cambierà mondo SPECIALE Sempre più centro dello sviluppo Macchine misura www.meccanica-automazione.com IL PORTALE CHE TI GUIDA VERSO LA SMART INDUSTRY TUTTI I VOLTI E LE AZIENDE DELLA MECCATRONICA URBAN & PARTNER MILANO (I) WRODAW (PL) GALLARATE (I) PIACENZA (I) TIRANA (AL) 1. Dealers 2. Service companies 3. Food industry 4. Healthcare 5. Public bodies 6. Public businesses 7. Hotellerie 8. Professional laundries 9. Pest management and environmental services 10. Large distribution
Pursuant to art. 13 European Regulation for the Protection
Data 679/2016 below GDPR, the data of all
will be
both manually and with IT tools and
be
for sending this and other
and
and
10 24 28

Solutions for professional cleaning COMAC S.p.A. Via Maestri del Lavoro, 13 - 37059 Santa Maria di Zevio - Verona - ITALY Tel. 045 8774222 - www.comac.it - com@comac.it Comac S.p.A. org. cert. ISO 9001:2015, ISO 14001:2015, ISO 45001:2018, SA 8000:2014 Download the catalogue

TURISMO TOURISM
Hostelería y desarrollo tecnológico Hospitality and technological development
Giacomo Torrenzi
Robots de servicio
Cristina Cardinali
Limpieza e higiene profesional, las tendencias para 2024 Professional
of 2024
Simone Ciapparelli
El
Mejorar la contratación pública en la UE
Improving public procurement
Maurizio Pedrini
HOY EN EL MERCADO ON THE MARKET
Los nuevos productos del mundo de la limpieza
The new products in the world of cleaning
Loredana Vitulano

ESTUDIO DE MERCADO MARKET SURVEY
Service robots
TECNOLOGÍA Y TENDENCIAS TECHNOLOGY & TRENDS
cleaning and hygiene trends
OBSERVATORIO EUROPEO EU OBSERVATORY
rol
EFCI en
políticas europeas
policies
Pedrini ÍNDICE/CONTENTS 36 42 50 58 ÍNDICE DE ANUNCIANTES/INDEX OF ADVERTISERS 4CleanPro 3, 68 Adiatek 48, 49 Comac 8, 68 Falpi Inside back cover, 68 Fimap 4, 5, 68 Igeax 16, 17 Industrie Celtex Front cover, 39 Interclean 61 MP-HT 45 Orma 34, 35 Paperdi 6, 68 Paredes Back cover, 68 RCM 56, 57 Rubino Chem Inside cover, 68
de
las
EFCI’s role in European
Maurizio
TODAY
MARKETING Clientes maleducados: ¿qué
Rude customers: what to do? Fabrizio Pirovano and Marco Monti 64 68 72 58
hacer?
Environmental and food sanitation safe, effective, validated
We need to redevelop, redesign, relaunch, starting to give importance and attention to health and safety as an individual and collective good. What will the rules of business be? What new tools do we need? How can we guarantee healthy and safe environments?
Massimo Artorige Giubilesi CEO Giubilesi & Associati srl Food technologist Food Safety & Environmental Health Advisor Manager for health of the environment
The guarantee of hygiene, health and safety in indoor environments has acquired more and more importance following the unexpected problems related to the health emergency, which we are all still dealing with and which have shifted our attention to new priorities and needs of social value for the individual and the community.
It becomes essential to evolve conventional chemical-oriented protocols towards validated integrated chemical-physical models for the prevention and control of contamination of biolog-
ical, chemical and physical origin.
We must provide concrete tools to virtuous public and private organizations to differentiate themselves, bringing out the global value of environmental health in a tangible way.
We must apply a new sustainable work program that puts people at the centre, qualifies skills and makes the best use of the chemical-physical technologies available on the market.
What is environmental sanitation
It is a set of procedures and treatments
of a physical, mechanical and chemical nature capable of making the environments in which people live, work and transit healthy, through the prevention and control of biological, chemical and physical contaminants and the improvement of the conditions of the microclimate.
Sanitization includes 6 levels of intervention for surfaces, equipment, furnishings, air: cleaning, detergency, disinfection, disinfestation, rodent control, microclimate control (temperature, humidity, ventilation, lighting, noise).
10 MARCH 2024
FOOD SAFETY

 CEO Giubilesi & Associati
CEO Giubilesi & Associati
Decalogue of environmental sanitization
1. We must give dignity and value to the cleaning sector in every target in which it operates.
2. There is no perfect system, but a set of effective techniques/technologies.
3. It is advisable to carry out a preliminary hygiene-safety check up (structure, air, water, surfaces).
4. Biological/chemical/physical risk analysis is the foundation of every sanitization plan.
5. Compatibility with electrical/electronic circuits and materials must be verified.
6. Sanitization must be sustainable, effective and tracked.
7. Chemical disinfection must be integrated with physical disinfection (steam, dioxidants, ozone).
8. Companies must educate, train and qualify their staff.
9. Companies must apply validated protocols.
10. Companies must carry out periodic monitoring of environmental hygiene (audit, tests, analyses).
Governing invisible entities
As a consequence of superficial and inadequate sanitisation, many families of microorganisms can anchor themselves to surfaces giving rise to the organic structure called “glycocalyx” which enlarges to form the microbial biofilm, which also becomes an attractive matrix for viruses which are intracellular parasites.
From these cellular aggregates, individual organisms are released which disperse and multiply rapidly, colonizing other surfaces and contaminating the surrounding environment.
11 MARCH 2024
Massimo Artorige Giubilesi,
srl
1. Adhesion of bacteria to the surface
2. Formation of the glycocalyx
3. Formation of bacterial biofilm
4. Detachment of single cells from the biofilm
5. Colonization of other sites
Traditional chemical sanitization Context
Action on organic and biological substances, medium-high effectiveness of the process, high labor costs, low product costs, training for staff, application of HACCP procedures, validation of the effectiveness of treatments, periodic checks (rapid tests, laboratory analyzes).
Cleansing
Eliminates organic dirt (alkaline pH 10-11). Eliminates inorganic dirt (acid pH 3-4). Reduces the total microbial load (saprophytic, ubiquitous, altering).
Disinfection (biocides)
Eliminates the total residual microbial load. Eliminates pathogenic microorganisms (bacteria, mold, yeasts, viruses).
Operational phases
of traditional sanitization
• Sanitization of contact surfaces and confined air.
• Removal of visible residues (paper, brush, vacuum cleaner).
Quick cleansing and rinsing (sponge).
• Disinfection and rinsing (microfibre or viscose cloth).
• Drying (microfibre or viscose cloth, compressed air).
• Protection of exposed parts of equipment (polyethylene sheets).
• Treatment of confined environments (physical and chemical systems).
Before disinfecting, organic and inorganic dirt must be eliminated. All phases are necessary for the final effectiveness of the treatments. There is no optimal system, but a set of techniques/technologies to achieve healthiness: respect doses, methods and times of use, correct use of PPE (gloves, masks, glasses, footwear).

You can also use leave-in products but they must be certified
Sustainable physical sanitization
Stand-alone RCI-FEO technology for indoor air treatment
Air-Tek stand-alone systems - Portable and autonomous systems with validated virucidal effects against SARS-CoV-2 equal to 99.99%.
The systems use combined technologies to ensure continuous sanitization in the presence of humans and pets, in particular booster technologies and RCI-FEO technology (Catalytic Ionizing Radiation + Heterogeneous Oxidizing Photocatalysis).
The UV light irradiates a honeycomb surface covered with an alloy in which nanostructured titanium dioxide prevails and generates a photocatalytic effect: the water vapor present in the air, in contact with the surface, is transformed into highly oxidizing plasma whose main components are hydrogen peroxide and hydroxyl radicals, with a small residue of ozone.
RCI-FEO technology for indoor air and surface treatment
In-Tek Systems - Intelligent systems for the natural treatment of air that can be
installed on aeraulic ducts or “plenums” (connections between the supply and return air from the AHU).
Ideal for buildings where an HVAC (Heating, Ventilation, Air Conditioning) system is already present, they significantly reduce odors, fumes of all kinds and microbial populations in the air and on surfaces, using RCI-FEO technology. The minimum maintenance required makes In-Tek an effective product for sanitizing hotel, bar and restaurant environments, capable of reducing costs compared to traditional times thanks to significant energy savings and the ability to carry out continuous sanitization 24 hours a day.
LIS technology for indoor air and surface treatment
LIS (Light Intelligence Sanification) systems - Integrated LED lighting + UV-C disinfection systems that combine light with sanitization of surfaces and air. Without producing ozone and residual chemicals, these systems have a disinfection rate of 99.9% and are equipped with a military-grade radar sensor with a range of up to 10 m, capable of activating the light in the presence of people and to start sanitization as soon as people leave the premises.
12 MARCH 2024
FOOD SAFETY
ASB technology for indoor air and surface treatment
ASB (Air Sanitizing Bar) Systems - A UV-C disinfection solution designed to be integrated into HVAC systems or to be installed directly on the wall thanks to the elegant design.
Ideal for inhabited and crowded public and private buildings (gyms, tertiary complexes, schools, hospitals, residences for the elderly) in which an HVAC system is already present, significantly reducing odors, potential chemical contaminants and microbial populations in the air and on surfaces.
They guarantee the continuous sanitization of environments even in the presence of people, in a safe manner with eco-friendly methods because they do not produce ozone and do not release chemical substances into the environment, acting effectively against bacteria, mold, fungi and viruses.
Testing and validation of systems
RadicalTek 4.0 physical sanitization technological systems are tested and validated by accredited universities and laboratories:
University of Padua: in vitro verification test for the killing of Sars-CoV-2 and var-
DIFFERENT TYPES OF DIRT
VISIBLE DIRT: food residues, dust, foreign bodies.
INVISIBLE DIRT: bacteria, spores, mold, viruses.
ORGANIC DIRT: fats, proteins, carbohydrates.
INORGANIC DIRT: mineral salts left by the water.
iants according to UNI EN 17272:2020 and UNI EN 14476:2019) with virucidal efficacy equal to 99.99%; Politecnico di Milano: active and passive filtration verification tests for the evaluation of cooking emissions in a restaurant according to UNI EN 13725:2004 and UNI EN ISO 16911-1:2013;
IST.I.B. Italian Institute of Bromatology: in vivo verification tests for the reduction and containment of microbial loads present as potential agents of infectious and parasitic diseases in dairy cattle stables.
New management models
We live in a complex world that sees rules and habits changing very quickly, forcing organizations and companies to seek new management models capable of containing uncertainty, combating crises and guaranteeing “business continuity” even during states of crisis or emergency.
Furthermore, in the global context of economic performance which sees consumers increasingly informed, attentive and demanding on the quality and safety of the products and services offered, also towards sustainability, is paramount to govern the internal processes that guarantee compliance of high standards of hygiene, safety and well-being.
New tools and professionalism
The need for a new paradigm linked to the safety and healthiness of environments becomes subordinated to the need to find new methods and approaches towards these problems starting from the basics, but going beyond the concept of sanitisation (cleaning, detergency, disinfection, disinfestation) and leading to the development of a “new culture” and methodology that goes beyond the usual concepts of prevention and hygienic-health safety in environments.
All this requires the creation of new tools, new services and new professional skills capable of managing the complexity of factors that must be taken into consideration in management processes.
Healthy working environments open to the public
The concept of healthiness of confined environments also becomes a legal value which translates into recognition of the rights of the individual or community that lives and/or uses the spaces. The time is ripe to transform the healthiness of closed environments into an essential quality of buildings like its energy efficiency, which in the form of certification constitutes an essential element for public health.
In fact, today, thanks to the painful push of the pandemic, we are witnessing an evolution in terms of standards that must be the basis of an integrated service for the prevention of contamination of biological, chemical and physical origin aimed at the healthiness of working and open environments to the public - Kiwa Italia ST SAL-AMB Certification Service which defines for the first time scientific, behavioral and management requirements (Integrated Prevention Service) - defining the expected results (scientific and behavioral result objectives) and the related requirements the type and frequency of internal controls.
Manager for healthy environments
A new method with an approach based on result performance, which goes beyond the current concepts of environmental sanitation and which requires the involvement of the “Environmental Healthiness Manager”, a new certified professional figure who has the responsibility of guaranteeing the achievement and maintenance over time the healthiness of the environments in compliance with the requirements of the ST-SAL_ AMB Standard.
This key figure is not limited, as in the case of the Covid Manager, to managing a single threat, but is able to satisfy the demand of companies that see the integration between safety, health, environment and contamination prevention as the most effective way to pursue legislative compliance, corporate strategies and the needs of workers and users.
13 MARCH 2024
HIGIENIZACIÓN AMBIENTAL Y ALIMENTARIA SEGURA, EFICAZ,VALIDADA
Es necesario volver a desarrollar, rediseñar, relanzar, empezando por dar importancia y atención a la salud y la seguridad como un bien individual y colectivo. ¿Cuáles serán las reglas del juego? ¿Qué nuevas herramientas necesitamos? ¿Cómo podemos garantizar entornos sanos y seguros?
Garantizar la salud y la seguridad en los ambientes interiores ha cobrado cada vez más importancia como consecuencia de los imprevistos relacionados con las emergencias sanitarias, de los que todos seguimos ocupándonos y que han desplazado nuestra atención hacia nuevas prioridades y exigencias de valor social para el individuo y la comunidad. Se hace imprescindible evolucionar los protocolos convencionales de orientación química hacia modelos químico-físicos integrados y validados de prevención y control de la contaminación de origen biológico, químico y físico. Debemos dotar a las organizaciones públicas y privadas virtuosas de herramientas concretas para diferenciarse, haciendo tangible el valor global de los Entornos Saludables. Debemos aplicar un nuevo programa de trabajo sostenible que ponga a las personas en el centro, cualifique las competencias y aproveche al máximo las tecnologías químico-físicas disponibles en el mercado.
Qué es el saneamiento ambiental
Es un conjunto de procedimientos y tratamientos de naturaleza física, mecánica y química capaces de hacer saludables los ambientes en los que viven, trabajan y transitan las personas, mediante la prevención y el control de los contaminantes biológicos, químicos y físicos y la mejora de las condiciones microclimáticas. La higienización comprende 6 niveles de intervención para superficies, equipos, mobiliario, aire: limpieza, detergencia, desinfección, control de plagas, desratización, control del microclima (temperatura, humedad, ventilación, iluminación, ruido).
Decálogo de saneamiento ambiental
1. El sector de la limpieza debe ser dignificado y valorado en todos los objetivos en los que opera.
2. No existe un sistema perfecto, sino un conjunto de técnicas/tecnologías eficaces.
3. Debe realizarse un chequeo previo de higiene/seguridad (estructura, aire, agua, superficies).
4. Un análisis de riesgos biológicos/químicos/ físicos es la base de cualquier plan de higienización.
5. Debe comprobarse la compatibilidad con los circuitos y materiales eléctricos/ electrónicos.
6. La desinfección debe ser sostenible, eficaz y trazable.
7. La desinfección química debe complementarse con la desinfección física (vapor, dioxidantes, ozono).
8. Las empresas deben formar, educar y cualificar al personal. 9. Las empresas deben aplicar protocolos validados.
10. Las empresas deben realizar un seguimiento periódico de la higiene ambiental (auditorías, pruebas, análisis).
Problemas invisibles que hay que gobernar Como consecuencia de una higienización superficial e inadecuada, muchas familias de microorganismos pueden anclarse a las superficies, dando lugar a la estructura orgánica denominada "glicocálix", que se agranda para formar la biopelícula microbiana, que también se convierte en una matriz atractiva para los virus que son parásitos intracelulares. A partir de estos agregados celulares, se liberan organismos individuales que se dispersan y multiplican rápidamente, colonizando otras superficies y contaminando el entorno circundante.
1. Adhesión de las bacterias a la superficie
2. Formación del glicocálix
3. Formación de la biopelícula bacteriana
4. Desprendimiento de células individuales de la biopelícula
5. Colonización de otros lugares
Higienización química tradicional Contexto acción sobre sustancias orgánicas y biológicas, eficacia media a alta del proceso, coste de mano de obra elevado, coste del producto bajo, formación - educación del personal, aplicación de procedimientos HACCP, validación de la eficacia del tratamiento, controles periódicos (pruebas rápidas, análisis de laboratorio.
Limpieza
Elimina la suciedad orgánica (pH alcalino 1011). Elimina la suciedad inorgánica (ácidos pH 3-4).Reduce la carga microbiana total (saprófitos, ubicuos, alteradores).
Desinfección (biocidas)
Elimina la carga microbiana residual total. Elimina los microorganismos patógenos (bac-
terias, mohos, levaduras, virus).
Fases operativas de la higienización tradicional
- Higienización de las superficies de contacto y del aire confinado Eliminación de residuos visibles (papel, cepillo, aspirador).
- Limpieza rápida y aclarado (esponja).
- Desinfección y aclarado (bayeta de microfibra o viscosa). Secado (bayeta de microfibra o viscosa, aire comprimido).
- Protección de las partes expuestas del equipo (paños de polietileno). Tratamiento de ambientes confinados (sistemas físicos y químicos).
La suciedad orgánica e inorgánica debe eliminarse antes de desinfectar. Todos los pasos son necesarios para la eficacia final de los tratamientos. No existe un sistema óptimo, sino un conjunto de técnicas/tecnologías para lograr la salubridad: respetar las dosis, los métodos y los tiempos de utilización, utilizar los EPI adecuados (guantes, mascarillas, gafas, calzado). También se pueden utilizar productos sin aclarado, pero deben estar certificados.
Higienización física sostenible
Tecnología autónoma RCI-FEO para el tratamiento del aire interior
Sistemas autónomos Air-Tek - Sistemas portátiles y autónomos con efectos virucidas validados contra el SARS-CoV-2 del 99.99%. Los sistemas utilizan tecnologías combinadas para garantizar una higienización continua en presencia de personas y animales domésticos, en particular la tecnología booster y la tecnología RCI-FEO (Radiación Catalítica Ionizante + Fotocatálisis Oxidante Heterogénea). La luz ultravioleta irradia una superficie alveolar recubierta de una aleación en la que predomina el dióxido de titanio nanoestructurado y genera un efecto fotocatalítico: el vapor de agua del aire, en contacto con la superficie, se transforma en un plasma fuertemente oxidante cuyos componentes principales son el peróxido de hidrógeno y los radicales hidroxilo, con un pequeño residuo de ozono.
Tecnología RCI-FEO para el tratamiento del aire interior y de superficies
Sistemas In-Tek - Sistemas inteligentes para el tratamiento natural del aire que pueden insta-
14 MARCH 2024
SEGURIDAD ALIMENTARIA
larse en conductos de aire o "plenums" (conexiones entre el suministro de aire y el retorno de la UTA).
Ideales para edificios en los que ya existe un sistema de calefacción, ventilación y aire acondicionado (HVAC), reducen sistemáticamente los olores, los humos de todo tipo y las poblaciones microbianas en el aire y las superficies mediante la tecnología RCI-FEO. El mantenimiento mínimo requerido convierte a In-Tek en un producto eficaz para la higienización de entornos de hoteles, bares y restaurantes, capaz de reducir costes en comparación con los sistemas tradicionales gracias al ahorroconstante de energía y a la capacidad de realizar una higienización continua las 24 horas del día.
Tecnología LIS para el tratamiento del aire y las superficies interiores
Sistemas LIS (Light Intelligence Sanification)Sistemas integrados de iluminación LED + desinfección UV-C que combinan la luz con la higienización de superficies y del aire. Estos sistemas, que no producen ozono ni productos químicos residuales, tienen un índice de desinfección del UU,U% y están equipados con un sensor de radar de grado militar con un alcance de hasta 10 m, capaz de activar la luz en presencia de personas e iniciar la higienización en cuanto las personas abandonan las instalaciones.
Tecnología ASB para el tratamiento del aire interior y las superficies Sistemas ASB (Air Sanitising Bar) - Una solución de desinfección UV-C diseñada para integrarse en sistemas HVAC o para instalarse directamente en la pared gracias a su elegante diseño. Ideales para edificios públicos y privados habitados y concurridos (gimnasios, complejos terciarios, escuelas, hospitales, residencias de ancianos) en los que ya existe un sistema HVAC, reducen sustancialmente los olores, los posibles contaminantes químicos y las poblaciones microbianas en el aire y en las superficies. Garantizan la higienización continua de los ambientes incluso en presencia de personas, de forma segura y ecológica porque no producen ozono y no liberan productos químicos en el ambiente, actuando eficazmente contra bacterias, mohos, hongos y virus.
Nuevos modelos de gestión
Vivimos en un mundo complejo en el que las normas y los hábitos cambian con gran rapidez, lo que obliga a organizaciones y empresas a buscar nuevos modelos de gestión capaces de contener la incertidumbre, contrarrestar las crisis y garantizar la "continuidad del negocio" incluso durante estados de crisis o emergencia. Además, en el contexto global de las tendencias económicas que ven a los consumidores cada vez más informados, atentos y exigentes sobre la calidad yseguridad de los productos y servicios, incluyendo la sostenibilidad, la necesidad

de gobernar los procesos internos que garanticen el cumplimiento de altos estándares de higiene, seguridad y bienestar se convierte en una prioridad.
Nuevas herramientas y profesionalidad
La necesidad de un nuevo paradigma vinculado a la seguridad y salubridad de los ambientes se subordina a la necesidad de encontrar nuevos métodos y enfoques para estas cuestiones, partiendo de lo básico, pero yendo más allá del concepto de higienización (limpieza, detergencia, desinfección, desinfestación) y conduciendo al desarrollo de una "nueva cultura" y metodología que vaya más allá de los conceptos habituales de prevención y seguridad higiénica de los ambientes.
Todo ello requiere la creación de nuevas herramientas, nuevos servicios y nuevas competencias profesionales capaces de gestionar la complejidad de los factores que deben tenerse en cuenta en los procesos de gestión.
Nuevos servicios y competencias certificadas
La necesidad de higiene y seguridad requerida en estados de emergencia encuentra una respuesta concreta y eficaz en dos nuevas certificaciones de KIWA CERMET Italia:
Estándar ST-SAL-AMB - Servicio Integrado para la prevención de la contaminación de origen biológico, químico y físico dirigido a la Salubridad de los Ambientes.
Estándar ST MSA - Gestor para la Salud Ambiental.
Se destina a todas las realidades virtuosas que pretendan someter a certificación algunos o todos sus ambientes de trabajo y/o ambientes abiertos al público, con excepción de los ambientes estrictamente sanitarios y de las salas hospitalarias.
Salubridad de los ambientes de trabajo y de los ambientes abiertos al público El concepto de salubridad de los entornos con-
finados se convierte también en un valor jurídico, que se traduce en el reconocimiento de los derechos del individuo o de la comunidad que habita y/o utiliza los espacios. Ha llegado el momento de convertir la salubridad de los espacios confinados en una cualidad esencial de los edificios, al mismo nivel que su eficiencia energética, que en forma de certificación es un elemento esencial para la salud pública. De hecho, hoy en día, gracias al doloroso empuje de la pandemia, asistimos a una evolución en términos de normas que deben ser la base de un servicio integrado de prevención de la contaminación de origen biológico, químico y físico destinado a la salubridad de los lugares de trabajo y de los entornos abiertos al público - Servicio de Certificación SAL-AMB de Kiwa Italia ST que define por primera vez los requisitos científicos, de comportamiento y de gestión (Servicio Integrado de Prevención) - definiendo los resultados esperados (objetivos de resultados científicos y de comportamiento) y los requisitos relativos al tipo y la frecuencia de los controles internos.
Gestores para entornos saludables
Un nuevo método con un enfoque basado en el rendimiento de los resultados, que va más allá de los conceptos actuales de higienización de locales y que requiere la implicación del "Gestor de salubridad de locales", una nueva figura profesional certificada que se encarga de garantizar que la salubridad de los locales se alcanza y se mantiene en el tiempo cumpliendo los requisitos de la Norma ST-SAL_AMB. Esta figura clave no se limita, como en el caso del Gestor Covid, a gestionar una única amenaza, sino que es capaz de satisfacer la demanda de las empresas que ven en la integración de la seguridad, la salud, el medio ambiente y la prevención de la contaminación la forma más eficaz de perseguir el cumplimiento legislativo, las estrategias corporativas y las necesidades de trabajadores y usuarios.
15 MARCH 2024
The Orange imperative
The Hygiene line has been enriched with a new colour to promote food hygiene and safety, while protecting consumer health: the orange range is an effective prevention tool in line with the HACCP management system that joins the wide range of colour-coded Igeax articles.
The new range includes a selection of best-selling products designed to meet the cleaning needs of all sectors of the food industry: hand brushes with and without handles, scrapers for dough cutting and spot cleaning, brooms for effective dirt collection and scrubbers for washing and removing encrustations.
Colour coding is a practical and effective system that can be applied in all environments and can also be applied to areas where food is produced, bringing considerable advantages: first of all, it allows us to match the appropriate equipment to a specific
environment and differentiate the equipment that comes into contact with allergens or chemical agents, identifying them immediately and managing them correctly. It also helps to detect and correct quickly any tools outside their area of responsibility at an early stage. Finally, colour-coding maximises the effectiveness of cleaning protocols, raises hygiene standards and significantly reduces the risk of cross-contamination

El imperativo naranja
La línea Higiene se ha enriquecido con un nuevo color para promover la higiene y la seguridad alimentaria, protegiendo al mismo tiempo la salud de los usuarios: la gama naranja es una eficaz herramienta de prevención en línea con el sistema de gestión APPCC que se une a la amplia gama de artículos Igeax codificados por colores.
La nueva gama incluye una selección de productos superventas diseñados para satisfacer las necesidades de limpieza de todos los sectores de la industria ali-
mentaria: cepillos manuales con y sin mango, rascadores para cortar masas y limpiar puntos, escobas para la recogida eficaz de la suciedad y cepillos barrendero para el fregado y la eliminación de incrustaciones.
El código de colores es un sistema práctico y eficaz que puede aplicarse en todos los entornos y también puede extenderse a las zonas donde se producen alimentos, aportando ventajas considerables: en primer lugar, permite adecuar el equipo adecuado a un entorno
específico y diferenciar los equipos destinados a entrar en contacto con alérgenos o agentes químicos, identificándolos inmediatamente y gestionándolos correctamente. Esto también permite detectar y corregir en una fase temprana cualquier herramienta que se encuentre fuera del área correspondiente. Por último, el código de colores maximiza la eficacia de los protocolos de limpieza, eleva los niveles de higiene y reduce significativamente el riesgo de contaminación cruzada
igeax.com
sponsored content





































DISCOVER THE RANGE Contact us: info@igeax.com | www.igeax.com improve hygiene standards make cleaning protocols more effective manage your equipment correctly reduce the risk of cross-contamination Improving hygiene and safety in the food industry with the orange range THE ORANGE IMPERATIVE Rely on COLOUR CODE to:
The “Seek and Destroy” method
Prevention and elimination of Listeria monocytogenes in food processing companies. Listeriosis continues to be the foodborne infection of greatest concern, with death rates (along with Salmonella) among the highest reported over the past 10 years in Europe
Francesca De Vecchi Food technologist
Listeria monocytogenes continues to be a big problem for food manufacturers and an ongoing challenge for those involved in sanitation processes. Adaptable, opportunistic, able to survive in some of the most common storage conditions and persistent in the environment even for years and under adverse conditions.
It is the bacterium responsible for listeriosis, a foodborne disease that has continued to grow in a statistically significant way in the European Union between 2009 and 2018, according to official data. Still in 2022, listeriosis was the foodborne infection of greatest concern, with death rates (along with Salmonella) among the highest reported over the past 10 years in Europe.
Which food products are commonly associated with listeriosis and most often involved in contamination cases? Due to its characteristics (see box) L. monocytogenes poses a danger to ready-to-eat (RTE) products and products with a
long shelf-life maintained at refrigeration temperatures, because it can grow in contaminated food to concentrations that can cause infection in humans. Thus, the foods primarily associated with listeriosis are generally those rich in protein, with moderate water activity and low background microflora. Thus, smoked fish (e.g., salmon), meat products (meat pâté, hot dogs, cold meats typical of delicatessens), soft cheeses, blue cheeses, lightly aged cheeses; prepackaged vegetables, and unpasteurized milk. Data indicate that the presence of L. monocytogenes in food products varies with a range from 0.09% for “hard cheeses made from pasteurized milk” to 3% for RTE beef. The contamination is of concern precisely for all those products that do not undergo further processing or remedial heat treatment before being consumed.
How then to deal with the problem of L. monocytogenes contamination? Is there a valid method for complete eradication?
In the European Union, ensuring food compliance with respect to the maximum possible levels of L. monocytogenes contamination is an obligation of the food business operator (FBO) through food production and distribution process hygiene based on good manufacturing practices and the application of HACCP. Over the years, the regulatory landscape regarding limits and controls has been enriched: EC Regulation 2073/2005 and subsequent amendments provides for L. monocytogenes safety criteria applicable to RTEs, both in production and marketing. 2021/1373 updated the list of foods at risk for Listeria monocytogenes to include raw milk products, raw meat, raw fish, and raw vegetables; but national (Ministry of Health) and European (EFSA) guidelines have also been gradually issued to guide the work of those responsible for ensuring and controlling food safety because L. monocytogenes is in all respects a supply chain contaminant. Thus, it can be understood how proper
18 MARCH 2024
FOOD SAFETY
management of production processes and environments (temperatures, hygiene, good manufacturing practices), proper food handling and the need to apply specific and monitored prevention plans are the cornerstones of a strategy to protect health. In fact, according to the data collected, the presence of L. monocytogenes in food is believed to occur through environmental contamination in post-processing rather than as a result of survival during heat treatments (Gurtler & Kornacki, 2007). Not only that, the persistence of L. monocytogenes can extend for years, as it is a bacterium that can remain viable on plant surfaces when particular conditions (e.g., organic residues, biofilms) that protect it from cleaning operations and encourage its development persist. Managing the risk of food contamination by this bacterium should always be part of self-control plans with targeted analysis and sanitization procedures that take into account the bacterium’s survival characteristics, types of food production, environment, equipment and facilities.
“Seek and Destroy”
The proliferation points, for Listeria (as for other pathogens), are a kind of shelter and are commonly referred to as niches. The concept of a protective niche as a sheltered place is the basis of an operational method known as “Seek&Destroy” (S&D) that is useful for identifying and managing these growth zones in equipment or facilities, eradicating them, and creating conditions so that they do not form (or reform), providing effective protection from Listeria growth in production environments. The method, initially developed in the United States, focuses attention not only on food production environments, but also on sanitation processes and their adequacy for preventing the danger of formation of growth niches for the pathogen. In niches, which are often difficult sites to reach and clean with normal sanitation procedures, Listeria finds suitable growth conditions to also colonize by forming biofilms which are resistant to disinfection on the surfaces of food production equipment and facilities.
“The Seek&Destroy method is an innovative approach to eradicating the Listeria hazard”, explains Giuseppe De Lucia, food technologist and sanitization consultant speaking at the Digital Foods Plus conference. “The niche - the expert continued - is the place that promotes microbial growth and is protected from contact with sanitizing agents. It is in fact characterized by having a high microbial count still after cleaning and disinfection”.
The presence of organic niches and residues, interfering with the cleaning and then sanitizing activity, protects Listeria; finding them at the end of the process indicates the fact that the sanitization procedure performed was not effective. The predominant factors influencing niche formation, in fact, point back to operational errors:
- incorrect application or wrong execution of sanitization procedures;
- incorrectly designed procedures (because, for example, they do not take into account the complex or incorrect hygienic design of the plant);

19 MARCH 2024

- incorrect frequency of application of the procedure;
- handling of personnel and equipment (e.g., trolleys being taken from dirty areas to “clean” areas without having sanitized the wheels. By airborne route, Listeria can reach surfaces in direct contact with food).
S&D is an investigative technique that includes an aggressive and systematic approach to identify sites of refuge and locate niches where microbes (not only Listeria monocytogenes but also other species of Listeria spp) survive (or persist) despite cleaning and disinfection measures put in place as part of the implementation of self-control plans. This is an innovative approach that subverts more commonly used methods that, however, do not guarantee food safety goals, comments De Lucia. “You usually look for the pathogen on the surfaces, in the production environment and in the product. And in case of absence, the protocol is evaluated as compliant.
The S&D approach, on the other hand, relies on a thorough preliminary study to highlight all potential niches and then remove them. Not only remove them, but more importantly understand why they formed and then implement corrective actions against the root causes to prevent them from reoccurring. It is an activity aimed at creating an effective prevention system because all conditions that facilitate the formation of potential bacterial nesting and proliferation sites are removed.
Areas of application
When can an S&D plan be applied? Such a process tends to be applied when food processors are required to:
- respond to a positive test for Listeria monocytogenes or its indicator organisms (Listeria spp or Listeria-like organisms);
- qualify a piece of equipment or process (e.g., as part of an evaluation of a new piece of equipment and thus not necessarily in the presence of a niche).
- perform validation of a process: this is normally a verification process that takes about 90 days (with one sampling per month).
Simplifying, De Lucia continues, there are mainly two types of application of this method, depending on whether one wants to verify whether a system is protected (“Not for cause”) or when the presence of the pathogen is established (“For cause”).
In the “Not for cause” hypothesis, one wants to check for the presence of pathogen growth niches on equipment. The procedure involves a series of gradually more thorough checks: it starts with checking the daily sanitization procedure (products used, concentration, method of use); it continues with an inspection by rapid analytical tests to see if there are niches (protein residues, bioluminometric tests, video inspections). It then provides for the disassembly of the equipment as per standard procedure to check for refuge sites and then, for the same purpose, advances with the complete disassembly of the machine (an operation that is usually scheduled, but at longer intervals). The presence or absence of recesses at locations not reached by daily cleaning operations gives a measure of the correctness of the routine sanitization procedure and thus the need to apply corrective actions (including the development of a new sanitization procedure).
In the case of “For cause” application, on the other hand, the way of contamination in case of positivity is evaluated: the aim of the research in this case is not only to identify the niches but more importantly to find the way of transfer of the pathogen at the origin of the contamination from the sites of origin to the point where it was found. The investigation must be developed by conducting multiple analyses with S&D technique or by identifying the transfer points that could have brought the microorganism to the site where the positive sample was found.
Thus, the cornerstone of this system is the identification and prevention of niches. This involves implementing corrective actions and then reinforcing the sanitation protocol to prevent niches from forming again. Given the resistance char-
20 MARCH 2024
FOOD SAFETY
Listeria monocytogenes isolated on agar
LISTERIOSIS IN FIGURES
Listeriosis, the infection generated by the bacterium Listeria monocytogenes, generally results from ingestion of contaminated food. It is a public health problem in Western countries because, although it occurs less frequently than salmonellosis and campylobacteriosis, it can result in serious illness, especially
in frail individuals such as the elderly, pregnant women, infants and immunocompromised adults, leading to hospitalization with high mortality rates. Listeria monocytogenes is a Gram-positive, non-spore-forming, mobile pathogenic bacterium. It is widely distributed in the environment,
soil, water and vegetation. It grows and reproduces at widely varying temperatures (from refrigeration temperatures up to 45°C), tolerates salty environments and acidic pH. It is therefore very resistant, particularly to the conditions that characterize food production and processing.
acteristics of the microorganism, it is important to assess persistence, track contamination, and characterize the strain of the microorganism (possibly with appropriate Whole Genome Sequencing techniques), thereby adjusting the sampling plan and supplementing with persistence assessments of Listeria monocytogenes strains. It means possibly providing for maintenance interventions, restoration of a hygienic design of part of the production facilities, handling according to
hygienic principles of equipment and personnel to generate a safe contamination prevention protocol.
Bibliography
E. Evans et al. Exploring Listeria monocytogenes perceptions in small and medium sized food manufacturers: Technical leaders’ perceptions of risk, control and responsibility. Food Control 2021
G. De Lucia. Nuovo metodo “Seek and Destroy” per la prevenzione ed eliminazione di Listeria monocytogenes e ruolo della sanificazione. Case History in un’industria alimentare. Alimenti più, 28 settembre 2023
Epicento.it
Malley TJ et al. Seek and destroy process: Listeria monocytogenes process controls in the ready-to-eat meat and poultry industry. J Food Prot. 2015

21 MARCH 2024
EL MÉTODO "SEEK AND DESTROY”
Prevención y eliminación de Listeria monocytogenes en establecimientos alimentarios. La listeriosis sigue siendo la infección de origen alimentario más preocupante, con tasas de mortalidad (junto con la salmonelosis) entre las más altas registradas en Europa en los últimos 10 años
La Listeria monocytogenes sigue siendo la pesadilla de los fabricantes de alimentos y un reto permanente para quienes intervienen en los procesos de desinfección. Adaptable, oportunista, capaz de sobrevivir en algunas de las condiciones de almacenamiento más comunes y de persistir en el medio ambiente incluso durante años en condiciones adversas. Esta es la bacteria responsable de la listeriosis, una enfermedad de transmisión alimentaria que, según datos oficiales, siguió creciendo de forma estadísticamente significativa en la Unión Europea entre 2009 y 2018. Todavía en 2022, la listeriosis fue la infección de origen alimentario más preocupante, con tasas de mortalidad (junto con la Salmonella) entre las más altas registradas en los últimos 10 años en Europa. Italia notificó tres brotes especialmente graves en el mismo año en términos de hospitalizaciones y muertes. Dos de ellos, de pollo y cerdo, fueron causados por Listeria monocytogenes y provocaron un total de 140 casos y hospitalizaciones y 6 muertes.
¿Qué alimentos se asocian habitualmente a la listeriosis y se ven implicados con más frecuencia en casos de contaminación? Debido a sus características (véase el recuadro), L. monocytogenes representa un peligro para los productos listos para el consumo (RTE) y los productos con una larga vida útil que se conservan a temperaturas de refrigeración, ya que puede crecer en los alimentos contaminados hasta concentraciones que pueden causar infección en los seres humanos. Por lo tanto, los alimentos asociados principalmente a la listeriosis suelen ser los ricos en proteínas, con una actividad acuosa moderada y una microflora de fondo baja. Así, el pescado ahumado (por ejemplo, el salmón), los productos cárnicos (paté de carne, salchichas, embutidos típicos de charcutería), los quesos blandos, los quesos azules, los quesos poco madurados; las verduras preenvasadas y la leche no pasteurizada. Los datos indican que la presencia de L. monocytogenes en los productos alimenticios oscila entre el 0,09% de los "quesos duros elaborados con leche pasteurizada" y el 3% de la carne de vacuno de consumo inmediato. La contaminación es preocupante precisamente en aquellos productos que no se someten a una transformación posterior o a un tratamiento térmico reparador antes de ser consumidos. Entonces, ¿cómo puede abordarse el problema de la contaminación por L. monocytogenes? ¿Existe algún método que tenga
como objetivo la erradicacióncompleta? En la Unión Europea, garantizar que los productos alimenticios cumplen los niveles máximos posibles de contaminación por L. monocytogenes es una obligación que incumbe al explotador de la empresa alimentaria (OEA) mediante la higiene del proceso de producción y distribución de alimentos basada en las buenas prácticas de fabricación y la aplicación del sistema HACCP. Con el paso de los años, el panorama normativo en materia de límites y controles se ha enriquecido: el Reglamento CE 2073/2005 modificado establece para L. monocytogenes, criterios de seguridad aplicables a los alimentos listos para el consumo, tanto en la fase de producción como en la de comercialización, y el 2021/1373, que actualizó la lista de alimentos de riesgo de Listeria monocytogenes para incluir los productos lácteos crudos, la carne cruda, el pescado crudo y las hortalizas crudas; pero también se han ido publicando directrices nacionales (Ministerio de Sanidad) y europeas (EFSA) para orientar el trabajo de los responsables de garantizar y controlar la seguridad alimentaria porque L. monocytogenes es a todos los efectos un contaminante de la cadena de suministro. Así pues, es comprensible que la gestión adecuada de los procesos y entornos de producción (temperatura, higiene, buenas prácticas de fabricación), la correcta manipulación de los alimentos y la necesidad de aplicar planes de prevención específicos y controlados constituyan las piedras angulares de una estrategia de protección de la salud. De hecho, según los datos recopilados, se cree que la presencia de L. monocytogenes en los alimentos se produce por contaminación ambiental en la fase posterior al procesado y no por supervivencia durante los tratamientos térmicos (Gurtler & Kornacki, 2007). Y no sólo eso: la persistencia de L. monocytogenes puede prolongarse durante años, ya que es una bacteria que puede permanecer -viable- en superficies vegetales cuando persisten condiciones particulares (por ejemplo, residuos orgánicos, biopelículas) que la protegen de las operaciones de limpieza y favorecen su crecimiento. La gestión del riesgo de contaminación de los productos alimenticios por esta bacteria debe formar parte siempre de los planes de autocontrol, con un análisis y unos procedimientos de higienización específicos que tengan en cuenta las características de supervivencia de la bacteria, los tipos de producción, el entorno, los equipos y las instalaciones.
El método "seek and destroy”
Los puntos de proliferación, para Listeria (como para otros patógenos), son una especie de refugio y se denominan comúnmente nichos. El concepto de nicho protector como lugar resguardado es la base de un método operativo conocido como "Seek and destroy" (S&D), útil para identificar y gestionar estas zonas de crecimiento en equipos o instalaciones, erradicarlas y crear las condiciones para que no se formen (o reformen), garantizando así una protección eficaz contra el crecimiento de Listeria en entornos de producción. El método, desarrollado inicialmente en Estados Unidos, centra la atención no sólo en los entornos de producción de alimentos, sino también en los procesos de higienización y su idoneidad para impedir la formación de nichos de crecimiento del patógeno. En los nichos, que suelen ser lugares difíciles dealcanzar y limpiar con los procedimientos normales de higienización, Listeria encuentra condiciones de crecimiento adecuadas para colonizar, incluso formando biopelículas, resistentes a la desinfección, en las superficies de los equipos e instalaciones de producción de alimentos.
“El método Seek&Destroy es un enfoque innovador para la erradicación de la amenaza de la Listeria”, explica Giuseppe De Lucia , tecnólogo alimentario y consultor en sanitización que intervino en la conferencia Alimentipiù.
“El nicho - prosigue el experto - es el lugar que favorece el crecimiento microbiano y está protegido del contacto con los agentes higienizantes. De hecho, se caracteriza por tener un elevado recuento microbiano incluso después de la limpieza y la desinfección”. La presencia de nichos y residuos orgánicos, al interferir con la actividad de limpieza y posterior higienización, protege a la Listeria; encontrarlos al final del proceso indica que el procedimiento de higienización realizado no fue eficaz. De hecho, los factores predominantes que influyen en la formación de nichos apuntan a errores operativos: - aplicación incorrecta o ejecución errónea de los procedimientos de higienización
- procedimientos incorrectamente diseñados (por ejemplo, porque no tienen en cuenta el complejo o incorrecto diseño higiénico de la planta)
- frecuencia de aplicación incorrecta del procedimiento
- manipulación de personal y equipos (por ejemplo, carros que se llevan de zonas sucias
22 MARCH 2024
HIGIENE ALIMENTARIA
a zonas "limpias" sin haber higienizado las ruedas. Por vía aérea, la Listeria puede llegar a las superficies en contacto directo con los alimentos). El S&D es una técnica de investigación que incorpora un enfoque agresivo y sistemático para identificar lugares de refugio y localizar nichos en los que los microbios (no sólo Listeria monocytogenes, sino también otras especies de Listeria spp.) sobreviven (o persisten) a pesar de las medidas de limpieza y desinfección establecidas como parte de la aplicación de planes de autocontrol.
Se trata de un enfoque innovador que subvierte los métodos más comúnmente utilizados que, sin embargo, no garantizan los objetivos de seguridad alimentaria, comenta De Lucia. “Normalmente buscamos el patógeno en las superficies, en el entorno de producción y en el producto. Y en caso de ausencia, el protocolo se evalúa como conforme. El enfoque S&D, en cambio, se basa en un minucioso estudio preliminar para poner de relieve todos los nichos potenciales y luego eliminarlos. No sólo eliminarlos, sino sobre todo entender por qué se formaron y luego aplicar medidas correctivas contra las causas que los generaron para evitar que vuelvan a producirse. Es un trabajo encaminado a crear un sistema eficaz de prevención porque se eliminan todas las condiciones que facilitan la formación de lugares de anidamiento potencial y proliferación bacteriana”.
¿Cuándo se puede aplicar un plan de S&D? Este tipo de proceso suele aplicarse cuando los procesadores de alimentos deben:
- responder a una prueba positiva de Listeria monocytogenes o sus organismos indicadores (Listeria spp u organismos similares a Listeria),
- cualificar un equipo o un proceso (por ejemplo, como parte de la evaluaciónde un nuevo equipo y, por tanto, no necesariamente en presencia de un nicho).
- realizar la validación de un proceso: normalmente se trata de un proceso de verificación
que dura unos 90 días (con un muestreo al mes).
Simplificando, prosigue De Lucia, existen principalmente dos tipos de aplicación de este método, según se quiera verificar si un sistema está protegido ("Sin causa") o cuando se confirma la presencia del agente patógeno ("Por causa").
En la hipótesis "No por causa", se quiere verificar la presencia de nichos de crecimiento de patógenos en el equipo. El procedimiento prevé una serie de controles progresivamente más profundos: se empieza por verificar el procedimiento diario de desinfección (productos utilizados, concentración, método de utilización); se continúa con una inspección mediante pruebas analíticas rápidas para ver si hay nichos (residuos de proteínas, pruebas bioluminométricas, inspecciones por vídeo). A continuación, prevé el desmontaje del equipo según el procedimiento habitual para comprobar la presencia de lugares de refugio y, con el mismo fin, procede al desmontaje completo de la máquina (operación que suele programarse, pero a intervalos más largos). La presencia o ausencia de huecos en lugares a los que no llegan las operaciones de limpieza diarias da una medida de la corrección del procedimiento ordinario de higienización y, por tanto, de la necesidad de aplicar medidas correctoras (incluido el desarrollo de un nuevo procedimiento de higienización). En cambio, en el caso de la aplicación "por causa", se evalúa el modo de contaminación en caso de positividad: el objetivo de la investigación en este caso no es sólo identificar los nichos, sino sobre todo encontrar el modo de transferencia del agente patógeno en el origen de la contaminación, es decir, desde los lugares de origen hasta el punto donde se ha encontrado. La investigación debe desarrollarse realizando varios análisis S&D o identificando los puntos de transferencia que podrían haber llevado el microorganismo al lugar donde se
LA LISTERIOSIS EN CIFRAS
La listeriosis, infección causada por la bacteria Listeria monocytogenes, se produce generalmente por la ingestión de alimentos contaminados. En los países occidentales es un problema de salud pública porque, aunque se da conmenos frecuencia que la salmonelosis y la campilobacteriosis, puede provocar enfermedades graves,
sobre todo en personas frágiles como ancianos, embarazadas, lactantes y adultos inmunodeprimidos, lo que conlleva hospitalizaciones con altas tasas de mortalidad Listeria monocytogenes es una bacteria patógena móvil, Gram positiva y no formadora de esporas. Está muy extendida en el medio ambiente, el
encontró la muestra positiva. La piedra angular de este sistema es, por tanto, la identificación y prevención de nichos. Se trata de aplicar medidas correctoras y, a continuación, reforzar el protocolo de higienización para evitar que vuelvan a formarse nichos. Dadas las características de resistencia del microorganismo, es importante evaluar la persistencia, rastrear la contaminación y caracterizar la cepa del microorganismo (posiblemente con técnicas adecuadas de secuenciación del genoma, como la secuenciación del genoma completo), adaptando así el plan de muestreo e integrándolo con las evaluaciones de la persistencia de las cepas de Listeria monocytogenes. Significa posiblemente prever el mantenimiento, el restablecimiento de un diseño higiénico de una parte de las instalaciones de producción, la manipulación higiénica de los equipos y del personal para generar un protocolo seguro de prevención de la contaminación.
Bibliografía consultada
E. Evans et al. Exploring Listeria monocytogenes perceptions in small and medium-sized food manufacturers: Technical leaders' perceptions of risk, control and responsibility. Food Control 2021
G. De Lucia. Nuevo método "Seek and Destroy" para la prevención y eliminación de Listeria monocytogenes y el papel del saneamiento. Caso práctico en una industria alimentaria. Alimentipiù, 28 de septiembre de 2023 Epicento.it
Malley TJ et al. Proceso “Seek and destroy”: controles del proceso de Listeria monocytogenes en la industria cárnica y avícola lista para el consumo. J Food Prot. 2015.
suelo, el agua y la vegetación. Crece y se reproduce a temperaturas muy variables (desde temperaturas de refrigeración hasta 45°C), tolera los medios salinos y el pH ácido. Por tanto, es muy resistente, en particular a las condiciones que caracterizan la producción y la transformación de alimentos.
23 MARCH 2024
Cleanliness as seen by chefs
The kitchen is the beating heart of every restaurant. A perfect kitchen is synonymous with hygiene, safety, and health. In this regard, we put a few questions to Sandro Bellucci, national secretary of the AIC (Italian Chefs Association)
Maurizio Pedrini

24 MARCH 2024
KITCHEN HYGIENE
What role are chefs called upon to play in the context of a kitchen?
"Chefs play a critical role in promoting hygiene, safety and health within a kitchen. Because the kitchen is the beating heart of a restaurant and the place where meals are prepared for customers, their efforts to maintain high standards of cleanliness and hygiene are essential. Here are some of the roles that chefs are called upon to fulfill in this sensitive setting.
Personal hygiene: chefs should adhere to strict standards of personal hygiene. This includes washing hands frequently, wearing clean work clothes and maintaining a groomed appearance. This helps prevent cross-contamination and ensure that food is handled safely.
Safe food handling : chefs should be trained in proper practices for handling, storing and cooking food. They should pay attention to cooking and storage temperatures and avoid cross-contamination between raw and cooked foods.
Cleaning and sanitation : chefs are responsible for keeping work areas clean and well organized. This includes regular cleaning of equipment, utensils and work surfaces to prevent the growth of harmful bacteria. Waste management: chefs must properly dispose of waste, including food waste, to prevent insect or rodent infestations. They must also comply with local regulations for waste disposal. Education and training : chefs should be properly trained in food hygiene and safety practices. This includes attending training courses and keeping abreast of new regulations and directives.
Collaboration and communication: chefs should work collaboratively with kitchen and dining room staff to ensure efficient workflow and to address any hygiene or safety issues that may arise. Hygiene monitoring : chefs should closely observe hygiene practices in
their work environment. If they notice situations that may compromise food safety, they should take immediate steps to correct them. Set an example for others: chefs play a leadership role in the kitchen environment. Maintaining high standards of hygiene and safety can positively influence the behavior and practices of other staff members. In summary, chefs play a crucial role in ensuring that a kitchen is a safe, hygienic and healthy environment. Their dedication to food hygiene and safety is critical to the success and reputation of the restaurant.
Can HACCP procedures vary depending on the type of restaurant and other factors?
"Certainly, not only based on the specific type of restaurant, but also on the menu offered and local regulations. It is essential to tailor the HACCP system to the specific needs of the restaurant and ensure compliance with current food safety regulations. After the worldwide spreading of Covid 19, procedures for sanitizing surfaces have changed regarding the use of specific sanitizing products such as, for example, sodium hypochlorite in 1% solution in the after-cleaning. For surfaces that may be damaged by such a product, a 75% ethyl alcohol solution is used.
What importance does your Association place on training cooks, issues related to hygiene knowledge related to cleaning, sanitation and pest control?
For AIC, the importance of training for chefs, especially in a food industry of excellence, is critical to ensuring food safety and consumer health. Proper hygiene practices play a crucial role in preventing the spread of foodborne diseases and ensuring that the meals served are safe and of high quality. Our association, in collaboration with ITCP, a culinary training school for the promotion of Italian cuisine of excellence, recognizes the impor-
tance of training in these issues. Food safety: hygiene training provides chefs with the knowledge needed to prevent food contamination and safely handle ingredients, minimizing the risk of foodborne illness. Professional reputation: well-trained chefs in food hygiene demonstrate commitment and professionalism, helping to enhance personal reputation and that of the entire culinary industry. Regulatory compliance: knowing and following local and national hygiene regulations is essential to avoid fines and penalties and to ensure that restaurant operations meet safety standards. Risk awareness: hygiene training helps chefs understand the potential risks associated with poor practices and take steps to prevent them. Pest prevention: pest control and cleanliness training helps prevent pest and insect infestation, which can damage the restaurant's reputation and food quality. Ethical responsibility: chefs have an ethical responsibility to provide safe and healthy meals to customers. Hygiene training is an integral part of this responsibility.
Do you think that your category, in general, is sensitized enough in relation to issues related to cleanliness in the hall and kitchen?
Awareness of hall and kitchen cleanliness issues may vary within the category of chefs. Many of them are well aware of the importance of hygiene and cleanliness in the kitchen and dining room, but there may be some variation in levels of awareness depending on training, experience, and individual approach. Chefs who have received formal culinary training or have worked in environments with strict attention to hygiene tend to be more sensitized to cleanliness and food safety practices. Chefs with more years of experience may have developed a greater awareness of hygiene practices through challenges and experiences during their careers.
25 MARCH 2024
In addition, increased focus on food safety and visibility of regulations may influence chefs' awareness of hygiene practices. The culture and environment in which a chef works can influence his or her awareness of cleanliness practices. For example, restaurants that place a strong emphasis on hygiene and food safety tend to have more knowledgeable chefs. Attending training courses, workshops, or seminars on food safety and hygiene can help keep cooks up-to-date and aware of new practices. However, it is important to note that there are always challenges in the food industry, including time pressures, high workloads, and stressful situations, which can affect the proper implementation of hygiene practices. Therefore, it is critical to continue to promote cleanliness and hygiene awareness and education among all members of the profession in order to ensure food safety and the quality of meals served.
In your experience, is the cleaning of surfaces and equipment best done by the kitchen staff themselves, properly trained, or by outside personnel from specialized firms?
The decision on who should carry out surface and equipment cleaning in a restaurant depends on several factors, including available resources, the specific needs of the restaurant, and local regulations. Both options have advantages to be considered. Cleaning by kitchen staff undoubtedly has some advantages: kitchen staff with appropriate training may be more familiar with the specific needs of the restaurant and food preparation practices. Regular cleaning can be incorporated into the daily work routine, ensuring that cleanliness is consistent. In addition, kitchen staff can respond immediately to urgent cleaning situations or potential hazards. I will add some of my own considerations in this regard: cleaning requires time and energy, which could be spent on other

activities in the kitchen. Kitchen staff may not have the specialized cleaning equipment or products needed to deal with more complex situations. Cleaning by specialized firms also has advantages: they can have the proper cleaning equipment and products to deal with complex situations and ensure thorough cleaning. Restaurant staff can concentrate on core culinary activities without having to spend too much time on cleaning. Specialized firms may have specific cleaning protocols and trained staff to deal with complex hygiene situations. More generally, hiring outside firms can result in additional costs for the restaurant. Communication and synchronization between restaurant staff and specialized firms may be necessary to ensure that cleaning needs are met. Many times, a combination of the two options might be adopted: kitchen staff might handle routine cleaning and daily maintenance, while specialized firms are brought in periodically for more thorough cleanings. Regardless of the approach chosen, it is critical to ensure that cleaning is done regularly, thoroughly, and in accordance with health regulations.
Regarding the choice of products and technologies for cleaning the kitchen and dining room, do you think chefs have - or wish to havean adequate say in the matter?
The choice of products and technologies for kitchen and restaurant cleaning is an important issue. It is likely that many cooks have a legitimate in-
terest in having a proper say in this process, as their choice of products can directly affect their ability to do their jobs effectively and safely. Chefs understand the specific needs of the kitchen and dining room better than anyone else. They know what surfaces need to be cleaned, what tools are used and what hazards may arise. The products and technologies used for cleaning can affect the chefs' work routines. For example, some products may require longer wait times for drying or may leave residues that could interfere with food preparation. In addition, chefs are directly involved in the use of cleaning products. They have an interest in ensuring that the products they select are safe to use and pose no risk to their health. Cooks understand the importance of complying with local and national food safety and cleanliness regulations. Product selection should comply with these regulations. Finally, cooks want to ensure that the products and technologies used for cleaning are effective in removing dirt, bacteria, and other contaminants so that high standards of hygiene are maintained. Although cooks may wish to have a voice in the process, it is important to remember that the final decision on product selection may also involve other stakeholders, such as restaurant owners, managers, and food safety experts. A collaborative approach that considers the needs of all parties involved can lead to more informed choices and a safer and more efficient work environment.
26 MARCH 2024 KITCHEN HYGIENE
LA LIMPIEZA VISTA POR LOS COCINEROS
La cocina es el corazón de todo restaurante. Una cocina perfecta es sinónimo de higiene, seguridad y salud. Sobre este tema, hemos planteado algunas preguntas a Sandro Bellucci, secretario nacional de la AIC, Asociación Italiana de Cocineros
¿Qué función están llamados a desempeñar los cocineros en este delicado contexto?
Los cocineros desempeñan un rol fundamental en la promoción de la higiene, la seguridad y la salud en una cocina. He aquí algunas de las funciones que los cocineros están llamados a desempeñar en este delicado contexto. Higiene personal: los cocineros deben cumplir estrictas normas de higiene personal. Esto incluye lavarse las manos con frecuencia, llevar ropa de trabajo limpia y mantener un aspecto cuidado. Esto ayuda a prevenir la contaminación cruzada y a garantizar que los alimentos se manipulan de forma segura. Manipulación segura de los alimentos: los cocineros deben ser instruidos en las prácticas correctas de manipulación, almacenamiento y cocción de los alimentos. Deben prestar atención a las temperaturas de cocción y almacenamiento, evitando la contaminación cruzada entre alimentos crudos y cocinados. Limpieza y desinfección: los cocineros son responsables de mantener las zonas de trabajo limpias y bien organizadas. Esto incluye la limpieza periódica del equipo, los utensilios y las superficies de trabajo para evitar la proliferación de bacterias nocivas. Gestión de residuos: los cocineros deben eliminar adecuadamente los residuos, incluidos los restos de comida, para evitar infestaciones de insectos o roedores. También deben cumplir la normativa local sobre eliminación de residuos. Educación y formación: los cocineros deben recibir una formación adecuada en prácticas de higiene y seguridad alimentaria. Esto incluye asistir a cursos de formación y mantenerse al día de las nuevas normativas y directivas. Control de la higiene: los cocineros deben observar cuidadosamente las prácticas de higiene en su entorno de trabajo. Si observan situaciones que puedan comprometer la seguridad alimentaria, deben tomar medidas inmediatas para corregirlas.
¿Qué importancia atribuye su Asociación a la formación de los cocineros, a las cuestiones relacionadas con los conocimientos de higiene en materia de limpieza, higienización y desinfección?
Para la AIC, la importancia de la formación de los cocineros, especialmente en una industria alimentaria de excelencia, es crucial para garantizar la seguridad alimentaria y la salud de los consumidores. Unas prácticas de higiene adecuadas desempeñan un papel crucial para prevenir la propagación de enfermedades de origen alimentario y garantizar que las comidas servidas sean seguras y de alta calidad. Seguri-
dad alimentaria: la formación higiénica proporciona a los chefs los conocimientos necesarios para prevenir la contaminación de los alimentos y manipular los ingredientes con seguridad, minimizando el riesgo de enfermedades transmitidas por los alimentos. Reputación profesional: los chefs bien formados en higiene alimentaria demuestran compromiso y profesionalidad, contribuyendo a mejorar su reputación personal y la de todo el sector culinario. Cumplimiento de la normativa: conocer y cumplir la normativa local y nacional en materia de higiene es esencial para evitar multas y sanciones y para garantizar que las operaciones de los restaurantes cumplen las normas de seguridad. Conciencia de los riesgos: la formación en higiene ayuda a los chefs a comprender los riesgos potenciales asociados a prácticas incorrectas y a tomar las medidas necesarias para evitarlos. Prevención de plagas: la formación sobre control de plagas y limpieza ayuda a prevenir la infestación de plagas e insectos, que pueden dañar la reputación del restaurante y la calidad de los alimentos. Responsabilidad ética: los chefs tienen la responsabilidad ética de ofrecer comidas seguras y saludables a los clientes.
Según su experiencia, ¿la limpieza de superficies y equipos debe ser realizada por el propio personal de cocina, adecuadamente formado, o por personal externo de empresas especializadas?
La decisión sobre quién debe realizar la limpieza de superficies y equipos en un restaurante depende de varios factores, como los recursos disponibles, las necesidades específicas del restaurante y la normativa local. Ambas opciones tienen ventajas que deben tenerse en cuenta. La limpieza por parte del personal de cocina tiene sin duda ciertas ventajas: el personal de cocina debidamente formado puede estar más familiarizado con las necesidades específicas del restaurante y las prácticas de preparación de alimentos. La limpieza regular puede incorporarse a la rutina diaria de trabajo, garantizando que la limpieza sea constante. Además, el personal de cocina puede responder inmediatamente a situaciones urgentes de limpieza o a peligros potenciales. Es posible que el personal de cocina no disponga del equipo o los productos de limpieza especializados necesarios para hacer frente a situaciones más complejas. La limpieza a cargo de empresas especializadas también tiene ventajas: pueden disponer del equipo y los productos de limpieza adecuados para hacer frente a situaciones complejas y garantizar una limpieza a fondo. El personal del restaurante puede concentrarse
en las actividades culinarias básicas sin tener que dedicar demasiado tiempo a la limpieza. Las empresas especializadas pueden tener protocolos de limpieza específicos y personal formado para hacer frente a situaciones higiénicas complejas. En general, la contratación de empresas externas puede suponer costes adicionales para el restaurante. La comunicación y sincronización entre el personal del restaurante y las empresas especializadas puede ser necesaria para garantizar que se satisfacen las necesidades de limpieza. Muchas veces, puede adoptarse una combinación de ambas opciones: el personal de cocina puede encargarse de la limpieza rutinaria y el mantenimiento diario, mientras que las empresas especializadas acuden periódicamente para una limpieza más exhaustiva.
En cuanto a la elección de productos y tecnologías para la limpieza de la cocina y el comedor, ¿cree que los cocineros tienen suficiente voz en este asunto?
La elección de productos y tecnologías para la limpieza de cocinas y comedores es un aspecto importante. Es probable que muchos cocineros tengan un interés legítimo en poder opinar adecuadamente en este proceso, ya que la elección de los productos puede influir directamente en su capacidad para realizar su trabajo de forma eficaz y segura. Los cocineros entienden mejor que nadie los requisitos específicos de la cocina y el comedor. Saben qué superficies hay que limpiar, qué utensilios se utilizan y qué peligros pueden surgir. Los productos y tecnologías utilizados para la limpieza pueden influir en las rutinas de trabajo de los cocineros. Además, los cocineros están directamente implicados en el uso de los productos de limpieza. Tienen interés en asegurarse de que los productos que seleccionan son seguros y no suponen un riesgo para su salud. Cumplimiento de la normativa en materia de higiene, los cocineros son conscientes de la importancia de cumplir la normativa local y nacional en materia de limpieza y seguridad alimentaria. La elección de los productos debe respetar estas normativas. Por último, los chefs quieren asegurarse de que los productos y tecnologías utilizados para la limpieza son eficaces para eliminar la suciedad, las bacterias y otros contaminantes, con el fin de mantener un alto nivel de higiene. Aunque es posible que los chefs deseen tener voz y voto, es importante recordar que la decisión final sobre la elección del producto también puede implicar a otras partes interesadas, como propietarios de restaurantes, gerentes y expertos en seguridad alimentaria.
27 MARCH 2024
HIGIENE EN LA COCINA
Pest management in Ho.Re.Ca.
The new guidelines for food safety based on the HACCP system
Michele Ruzza Consultant and Pest Management Advisor

28 MARCH 2024
HACCP
In 2016, the European Commission had issued a communication on the implementation of systems for proper food safety management based on prerequisite programs (PRPs) with procedures that were based on the HACCP system. Following updates and revision of regulations such as: Regulation (EU) 2021/382 (1) on food safety culture and allergen control and revision of international standards; ISO 22000 (2); Codex Alimentarius General principles of food hygiene (3); adoption of the Codex Alimentarius Code of Practice on Food Allergen Management for Food Business (4), EFSA (European Food Safety Authority) issued a number of relevant scientific opinions (5) which, together with other practical experiences, led to the revision of the 2016 document with a new document identified as “Communication from the European Commission on the implementation of food safety management systems covering good hygienic practices and procedures based on HACCP principles, including facilitation/flexibility for implementation in certain food businesses (2022/C 355/01) of September 16, 2022.”
The purpose of this new document, which we are going to analyze, is to harmonize the application of the EU requirements of Good Hygienic Practices (GHPs), procedures based on the principle of hazard analysis, and Critical Control Points (CCPs) within a Food Safety System (FSMS) by offering practical guidance, with the understanding that the document drafted by the committee is not legally binding unlike the legal requirements identified in section 4 of the document.
The Good Hygiene Practices (GHP)
These are the basic measures and conditions that, applied at any stage of the food chain, ensure that safe and adequate food is provided (6) and are developed with a GHP plan given by documents and records that justify the actions taken, surveillance, verification and corrective actions (if applicable), procedures that
are naturally integrated into the HACCP plan.
Thus, one has that the Food Business Operator (FBO) must follow procedures based on the HACCP system such as Article 5 of Regulation (EC) No. 852/2004, which provides that the general hygiene requirements in Annex I, applicable to primary production and associated operations, and Annex II, applicable to other stages of the food production chain, must be met. In essence, Article 5 requires FBOs to set up, implement and maintain one or more permanent procedures based on HACCP principles that are useful for controlling any inherent hazards in food.
Other obligations can then be identified in Regulation (EC) No.178/2002 (7) which establishes another set of mandatory principles and requirements as part of proper management of the food safety system such as: risk analysis, precautionary principle, transparency/communication, primary responsibility of FBOs, etc. There are also other guidelines given by the European Commission on specific directions.
(https://food.ec.europa.eu/horizontal-topics/general-food-law_en).
The Food Safety Management System (FSMS)
As a whole, therefore, the FSMS (8) turns out to be a system that must include Good Hygienic Practices (GHP) and procedures based on the HACCP system with a prerequisite program (PRP), supplemented by control measures at Critical Control Points (CCPs), which ensure that food is safe and suitable for its intended use.
Thus, we have that in a food safety management system (FSMS) in the Ho.Re. Ca. sector, the control of potential pests in an Integrated Pest Management (IPM) perspective is also fully included.
Training
A key point of the document is the training of FBOs, which is to be divided according to role. Thus, general hygiene
training (intended for all employees) and specific training directed at those who supervise/manage FMCs is identified. In March 2021, the importance of training was further reinforced with a mandatory food safety culture requirement in Regulation (EC) No.852/20024 (see Annex I, Section 4.14).
The management of pests
The Food Safety practitioner must therefore document proper hygiene practices to ensure food safety, taking into account the size of the food business, as well as identify the person(s) responsible for their implementation. Clearly, in proper hygiene practices, pest management is identified as a key point of GHPs. The concept of pest control, in the example given by the paper, is developed from an Integrated Pest Management (IPM) perspective, going to emphasize prevention activities over control activities.
In fact, from a prevention perspective, we have that in the first points of the document (9): exterior walls should be free of cracks or crevices; surrounding areas cared for and free of shelter sites to pest animals; access to domestic or wild animals should be prohibited/interdicted; windows should be provided with mosquito nets; doors should be kept closed; gaps between doors and floors should be sealed; equipment and premises should be kept clean. Subsequent to prevention works, the need for a monitoring program against pests is identified, including: opportunity for an adequate number of baits or traps with strategic placement (indoor and outdoor); monitoring of rodents, crawling and flying insects; disposal of any carcasses or dead insects to avoid the risk of contact with food. Finally, in case of recurring pest problems, the possibility of control by use of chemicals authorized by the Biocides Regulation (10), for pest control is identified. Finally, from a prevention perspective, it is identified how chemicals
29 MARCH 2024

(biocides)should not be used to monitor infestations, recognizing a proper distinction between monitoring and pest control. For the concept of flexibility, on the other hand, it is identified as it would be best to use professional pest control even though, in most cases, it is not mandatory as long as personnel can demonstrate their competence. On this point, it is then identified how small businesses, in particular, can apply such flexibility.
Small food companies
It is important to go and identify what might be a proper procedure for pest management in a small business to ensure proper food safety, with the primary goal being to reduce the number of CCPs without jeopardizing food safety. To achieve this, it is increasingly important, in the first instance, that pro-
fessional figures specialized in pest management go to identify, on the basis of production processes, the various preventive works to be put in place in addition to identifying the areas of risk according to the food processed and/or administered to identify the correct critical control points, giving an indication of the correct monitoring system to be put in place and included in the HACCP plan.
Once these points have been identified, it is also important to go on to establish what can be defined as Critical Limits (thresholds) beyond which a single pest could lead to possible contamination of the food, and then establish the cadence of CCP monitoring.
While in a spirit of flexibility, monitoring can be performed by the FBO, it is essential that the FBO has been properly instructed in the compilation of doc-
umentation and has knowledge of what may be the main opportunistic pests (in addition to food-specific pests), to go on to identify whether critical limits are exceeded that could lead to food contamination. Specific and documented training is therefore required to achieve this, to demonstrate competence. In pest monitoring, however, wastes are also to be taken into consideration, in fact the FBO, in case it independently complies with monitoring and pest control, becomes both a legal producer and a material producer, i.e., that materially produces the waste, so it should have all the necessary traceability documentation for the disposal of what are identified as special wastes (dead rodent carcasses, used ratticide baits, supports with glues soiled by insects and/or rodents, containers of insecticidal or rodenticidal products).
30 MARCH 2024
HACCP
On the other hand, with regard to pest control, it is necessary (in my opinion) to refer to professionals in the field, namely pest control companies. In fact, it is known that the use of biocides and PMCs is increasingly regulated and that the same must be used according to what is indicated in their authorization, in order not to incur the risk of arrest up to three months and fine from € 1,000.00 to € 10,000.00 (11). Based on this, it is therefore clear that the FBO, in order to use what are generally called insecticides, must be properly trained in their use.
The possible solutions
So, with a view to flexibility, what can be the best solution for pest management in a small food business? In my opinion, two paths can be pursued. In the first scenario, cooperation starts with proper identification of monitoring processes and identification of CCPs developed by a Pest Management professional in collaboration with the FBO. Once the monitoring processes have been identified and trained, the food handler (and his possible collaborators) can move on to a contract with a pest management company, where to go and properly define the different activities and competencies. One could leave standard monitoring, based on the Risk Analysis to the FBO, while the Pest Control Company periodically provides for the change of locations in addition to
intervening in case of urgency in case of threshold exceedance and need for specific pest control with biocides. In the second hypothesis, subject to the identification of CCPs in collaboration between professional in the field and FBO and the identification of risk thresholds, after careful and documented training leave all monitoring management, perhaps even through new digital technologies, to the managers of the small food business and involve the pest control company only in case of actual need (pest control intervention). In this case, however, it is important for the small food business to set up proper waste management and to be able to prove the purchase of the CCP replacement material to the authorities in case of inspection.
(4) CXC 80-2020
(5) “Hazard Analysis Approaches for Certain Small Retailers for the Application of their Food Safety Management Systems” (EFSA Journal 2017; 15(3):4697) and “Second Scientific Opinion on Hazard Analysis Approaches for Certain Small Retailers and Food Donations” (EFSA Journal 2018; 16(11):5432).
(6) CXC 1-1969 Rev.2020
(7) Regulation (EC) No. 178/2002 of the European Parliament and of the Council of January 28, 2002, laying down the general principles and requirements of food law, establishing the European Food Safety Authority and laying down procedures in matters of food safety (OJ L 31, 1.2.2002, p. 1)
(1) Commission Regulation (EU) 2021/382 of March 3, 2021 amending the annexes to Regulation (EC) No 852/2004 of the European Parliament and of the Council on the hygiene of foodstuffs as regards food allergen management, food redistribution and food safety culture (OJ L 74, 4.3.2021, p. 3).
(2) ISO 22000:2018 Food safety management systems – Requirements for any organization in the food chain (https://www. iso.org/standard/65464.html).
(3) CXC 1-1969.
(8) In the Codex Alimentarius General principles of food hygiene document, the FSMS is referred to as a “food hygiene system.” FSMS can be part of a broader quality management system (such as ISO 9000), which also includes food quality aspects (including composition and nutritional values). Quality aspects are outside the scope of the guideline.
(9) Communication from the commission on the implementation of food safety management systems covering good hygiene practices and procedures based on HACCP principles, including facilitation/flexibility on implementation in certain food businesses (Annex I, Ch. 3.3, p. 14)
(10) Regulation (EU) No.528/2012
(11) Legislative Decree 02/11/2021, no.179

31 MARCH 2024
GESTIÓN DE PLAGAS EN HO.RE.CA.
Las nuevas directrices de seguridad alimentaria basadas en el sistema HACCP
En 2016, la Comisión Europea emitió una comunicación sobre la aplicación de sistemas para una correcta gestión de la seguridad alimentaria basada en programas de prerrequisitos (PRP) con procedimientos basados en el sistema HACCP. Tras las actualizaciones y revisiones de reglamentos como: Reglamento (UE) 2021/382 (1) sobre cultura de seguridad alimentaria y control de alérgenos y revisión de normas internacionales; ISO 22000 (2); Codex Alimentarius Principios generales de higiene de los alimentos (3); adopción del Código de prácticas sobre gestión de alérgenos alimentarios para las empresas alimentarias del Codex Alimentarius (4); la EFSA (Autoridad Europea de Seguridad Alimentaria) emitió una serie de dictámenes científicos pertinentes (5) que, junto con otras experiencias prácticas llevaron a la revisión del documento de 2016 con un nuevo documento identificado como "Comunicación de la Comisión Europea sobre la aplicación de sistemas de gestión de la seguridad alimentaria que incluyan buenas prácticas y procedimientos de higiene basados en los principios APPCC, incluida la facilitación/ flexibilidad de la aplicación en determinadas empresas alimentarias (2022/C 355/01) de 16 de septiembre de 2022".
El objetivo de este nuevo documento, que vamos a analizar, es armonizar la aplicación de los requisitos de la UE en materia de Buenas Prácticas de Higiene (BPH), procedimientos basados en el principio de Análisis de Peligros y Puntos Críticos de Control (PCC) dentro de un Sistema de Seguridad Alimentaria (SGSA) ofreciendo una guía práctica, entendiendo que el documento elaborado por la comisión no es jurídicamente vinculante a diferencia de los requisitos legales identificados en el apartado 4 del documento.
Buenas Prácticas de Higiene (BPH)
Son las medidas y condiciones básicas que, aplicadas en cualquier fase de la cadena alimentaria, garantizan el suministro de alimentos seguros y adecuados (6) y se desarrollan con un plan de BPH dotado de documentos y registros justificativos de las acciones realizadas, vigilancia, verificación y acciones correctoras (si procede), procedimientos que se integran de forma natural en el plan HACCP. Esto significa que el operador de empresa alimentaria (OEA) debe seguir procedimientos basados en el sistema APPCC, como el artículo 5 del Reglamento (CE) nº 852/2004, que estipula el cumplimiento de los requisitos generales de higiene del anexo I, aplicable a la producción primaria y a las operaciones asociadas, y
del anexo II, aplicable a otras fases de la cadena deproducción alimentaria. En esencia, el artículo 5 exige que los OC establezcan, apliquen y mantengan uno o varios procedimientos permanentes basados en los principios del APPCC para controlar los posibles peligros alimentarios.
A continuación, pueden identificarse otras obligaciones en el Reglamento (CE) nº 178/2002 (7), que establece otra serie de principios y requisitos obligatorios en el marco de una gestión adecuada del sistema de seguridad alimentaria, como son: el análisis de riesgos, el principio de precaución, la transparencia/ comunicación, la responsabilidad principal del OC, etc. También existen otras directrices dadas por la Comisión Europea sobre direcciones específicas (https://food.ec.europa.eu/horizontal-topics/general- food-law_en).
El Sistema de Gestión de la Seguridad Alimentaria (SGSA)
En su conjunto, por tanto, el SGSA (8) es un sistema que debe incluir Buenas Prácticas de Higiene (BPH) y procedimientos basados en el sistema HACCP con un programa de prerrequisitos (PRP), complementado con medidas de control en los Puntos Críticos de Control (PCC), que garanticen que los alimentos son seguros y adecuados para el uso previsto.
Así pues, un sistema de gestión de la seguridad alimentaria (SGSA) en el sector Ho.Re.Ca. también incluye plenamente el control de las
posibles plagas en una perspectiva de gestión integrada de plagas (GIP).
Formación
Un punto fundamental del documento es la formación de los OC, que debe dividirse en función de la función.
Así, se identifica la formación general en higiene (para todos los empleados) y la formación específica para aquellos que supervisan/gestionan los CSA. En marzo de 2021, la importancia de la formación se refuerza aún más con un requisito obligatorio de cultura de seguridad alimentaria en el Reglamento (CE) nº 852/20024 (véase la sección 4.14 del anexo I).
Gestión de plagas
Por lo tanto, el operador de seguridad alimentaria debe documentar las prácticas higiénicas correctas para garantizar la seguridad alimentaria, teniendo en cuenta el tamaño de la empresa alimentaria, así como identificar a la persona o personas responsables de su aplicación. Evidentemente, en las buenas prácticas de higiene, la gestión de plagas se identifica como un punto clave de las BPH. El concepto de control de plagas, en el ejemplo expuesto en el documento, se desarrolla desde una perspectiva de Gestión Integrada de Plagas (GIP), enfatizando las actividades de prevención sobre las de control.
De hecho, desde la perspectiva de la prevención, los primeros puntos del documento (9)

32 MARCH 2024
HACCP
establecen que: las paredes exteriores deben estar libres de grietas o hendiduras; las zonas circundantes deben estar cuidadas y libres de lugares de refugio de plagas; se debe prohibir/ prohibir el acceso a animales domésticos o salvajes; las ventanas deben estar provistas de mosquiteras; las puertas deben mantenerse cerradas; las grietas entre puertas y suelos debenestar selladas; los equipos y los locales deben mantenerse limpios. Tras las labores de prevención, se considera necesario un programa de vigilancia de plagas que incluya: la oportunidad de disponer de un número adecuado de cebos o trampas con una colocación estratégica (en interiores y exteriores); la vigilancia de roedores, insectos rastreros y voladores; la eliminación de cualquier cadáver o insecto muerto para evitar el riesgo de contacto con los alimentos. Por último, en caso de problemas recurrentes de plagas, se identifica la posibilidad de control mediante sustancias químicas autorizadas por el reglamento sobre biocidas (10). Por último, de cara a la prevención, se identifica que las sustancias químicas (biocidas) no deben utilizarse para el control de plagas, reconociendo una correcta distinción entre control y lucha contra las plagas. Por otro lado, para el concepto de flexibilidad, se identifica que sería mejor recurrir a un control de plagas profesional aunque, en la mayoría de los casos, no sea obligatorio siempre que el personal pueda demostrar su competencia. Sobre este punto, se identifica a continuación cómo las pequeñas empresas, en particular, pueden aplicar dicha flexibilidad.
En las pequeñas empresas alimentarias
Es importante identificar cuál puede ser el procedimiento correcto para la gestión de plagas en una pequeña empresa, con el fin de garantizar una seguridad alimentaria adecuada, entendiendo que la flexibilidad tiene como objetivo principal reducir el número de CMP sin poner en peligro la seguridad alimentaria. Para conseguir este resultado, es cada vez más importante, en primer lugar, que los profesionales especializados en la gestión de plagas identifiquen, en base a los procesos productivos, las distintas medidas de prevención a implantar, así como identificar las áreas de riesgo en función del alimento elaborado y/o administrado para identificar los puntos críticos de control correctos, indicando el sistema de vigilancia correcto a implantar e incluir en el plan HACCP. Una vez identificados estos puntos, también es importante pasar a establecer lo que pueden definirse como Límites Críticos (umbrales) más allá de los cuales una sola plaga podría provocar una posible contaminación del alimento, y a continuación establecer la frecuencia del seguimiento de los PCC. Aunque el seguimiento puede ser llevado a cabo de forma flexible por el OC, es esencial que el OC haya sido debidamente instruido en
la recopilación de la documentación y tenga conocimiento de las principales plagas oportunistas (además de las específicas de los productos alimenticios), con el fin de identificar si se han superado los límites críticos que podrían conducir a la contaminación de los alimentos. Para ello, es necesaria una formación específica y documentada. En el control de plagas, sin embargo, también hay que tener en cuenta los residuos. De hecho, si el OC realiza el control y la lucha contra las plagas de forma independiente, se convierte tanto en productor legal como en productor material, es decir, produce materialmente los residuos, por lo que debe disponer de toda la documentación de trazabilidad necesaria para la eliminación de lo que se identifique como residuos especiales (cadáveres deroedores muertos, cebos para ratas usados, soportes con colas manchados por insectos y/o roedores, envases de insecticidas o rodenticidas).
Por otro lado, en lo que respecta al control de plagas, es necesario (en mi opinión) recurrir a profesionales en la materia, es decir, a empresas de control de plagas. De hecho, es bien sabido que el uso de biocidas y PMC está cada vez más regulado y que deben utilizarse de acuerdo con su autorización, para no incurrir en el riesgo de arresto de hasta tres meses y una multa de entre 1.000,00 y 10.000,00 euros (11). Sobre la base de lo anterior, queda claro, por tanto, que el OC, para utilizar lo que generalmente se define como insecticidas, debe estar debidamente formado en su uso.
Posibles soluciones
Así pues, con vistas a la flexibilidad, ¿cuál puede ser la mejor solución para la gestión de plagas en una pequeña empresa alimentaria? En mi opinión, se pueden tomar dos caminos. El primero es la cooperación que comienza con una identificación adecuada de los procesos de control y la identificación de los PCC desarrollados por un profesional de la gestión de plagas en cooperación con la empresa alimentaria. Una vez identificados los procesos de supervisión y formado el operador de la empresa alimentaria (y sus posibles colaboradores), se pasa a un contrato con una empresa de gestión de plagas, en el que se definen adecuadamente las distintas actividades y competencias. El seguimiento estándar podría dejarse en manos del explotador de la empresa alimentaria sobre la base del Análisis de Riesgos, mientras que la empresa de control de plagas cambiaría periódicamente las ubicaciones, además de intervenir de urgencia en caso de superación de umbrales y necesidad de control específico de plagas con biocidas.
En la segunda hipótesis, sin perjuicio de la identificación de los PCC en colaboración entre el profesional del sector y la empresa alimentaria y la identificación de los umbrales de riesgo, después de una formación cuidadosa y documentada dejar toda la gestión del control,
tal vez también gracias a las nuevas tecnologías digitales, a los gestores de la pequeña empresa alimentaria y sólo involucrar a la empresa de control de plagas en caso de necesidad real (intervención de control de plagas). En este caso, sin embargo, es importante que la pequeña empresa alimentaria establezca una gestión adecuada de los residuos y pueda demostrar a las autoridades la compra de material de sustitución de PCC en caso de inspección.
(1) Reglamento (UE) 2021/382 de la Comisión, de 3 de marzo de 2021, por el que se modifican los anexos del Reglamento (CE) nº 852/2004 del Parlamento Europeo y del Consejo, relativo a la higiene de los productos alimenticios, en lo que respecta a la gestión de los alérgenos alimentarios, la redistribución de alimentos y la cultura de la seguridad alimentaria (DO L 74 de 4.3.2021, p. 3).
(2) ISO 22000:2018 Sistemas de gestión de la seguridad alimentaria - Requisitos para cualquier organización de la cadena alimentaria (https://www.iso.org/standard/65464.html). (3) CXC 1-1969.
(4) CXC 80-2020.
(5) "Enfoques de análisis de peligros para determinados pequeños minoristas para la aplicación de sus sistemas de gestión de la seguridad alimentaria" (EFSA Journal 2017; 15(3):4697) y "Segundo dictamen científico sobre enfoques de análisis de peligros para determinados pequeños minoristas y donaciones de alimentos" (EFSA Journal 2018; 16(11):5432).
(6) CXC 1-1969 Rev.2020
(7) Reglamento (CE) nº 178/2002 del Parlamento Europeo y del Consejo, de 28 de enero de 2002, por el que se establecen los principios y los requisitos generales de la legislación alimentaria, se crea la Autoridad Europea de Seguridad Alimentaria y se fijan procedimientos relativos a la seguridad alimentaria (DO L 31 de 1.2.2002, p. 1).
(8) En el documento del Codex Alimentarius Principios generales de higiene de los alimentos, el SGSA se denomina "sistema de higiene de los alimentos". El SGSA puede formar parte de un sistema de gestión de la calidad más amplio (como ISO 9000), que también incluye aspectos de calidad de los alimentos (incluidos la composición y los valores nutricionales). Los aspectos de calidad quedan fuera del ámbito de aplicación de la directriz.
(9) Comunicación de la Comisión sobre la aplicación de sistemas de gestión de la seguridad alimentaria que incluyan prácticas correctas de higiene y procedimientos basados en el HACCP, incluida la facilitación/flexibilidad de la aplicación en determinadas empresas alimentarias (anexo I, capítulo 3.3, p. 14).
(10) Reglamento (UE) nº 528/2012.
(11) Decreto Legislativo n.º 179 de 02/11/2021t
33 MARCH 2024
Innovation and Excellence: Orma's mission in Pest Management
Orma has been a leading company in Pest Control for
over 40 years, driven by innovation and excellence to

Innovación y Excelencia:
Orma ha sido una empresa líder en el Control de Plagas durante más de 40 años, impulsada por la innovación y la excelencia para ofrecer soluciones profesionales, innovadoras y funcionales que satisfagan las necesidades cada vez mayores de nuestros clientes.
Uno de nuestros productos más exitosos, Air Control S®, es un ejemplo tangible de nuestro compromiso de crear productos efectivos para necesidades específicas. Este insecticida a base de piretro, utilizado con difusores automáticos electrónic-
provide professional, innovative, and functional solutions to meet the ever-growing needs of our customers.
One of our most successful products, Air Control S®, is a tangible example of our commitment to creating effective products for specific needs. This pyrethrum-based insecticide, used with electronic automatic diffusers, provides immediate knockdown action on flying insects such as flies, mosquitoes, and moths. But that's not all: the repellent effect of the pyrethrum extract helps prevent infestation of treated areas by insects, offering longterm protection.
Air Control S is versatile and suitable for a wide range of environments, from domestic environments to commercial buildings, including offices, schools, restaurants,
hotels, and transportation vehicles. Its effectiveness is further enhanced by its ease of use: it can also be manually applied, ensuring complete and uniform coverage of the treated environment.
We are here to provide our customers with products and services that exceed expectations, for the well-being of people and the environments in which we live and work.
Discover more about our solutions and the new ORMA 2024 Catalog by visiting our website and contacting us for any additional information.

La
misión de Orma en el Manejo de Plagas
os, proporciona una acción inmediata de derribo sobre insectos voladores como moscas, mosquitos y polillas. Pero eso no es todo: el efecto repelente del extracto de piretro ayuda a prevenir la infestación de áreas tratadas por insectos, ofreciendo protección a largo plazo.
Air Control S es versátil y adecuado para una amplia gama de entornos, desde entornos domésticos hasta edificios comerciales, incluidas oficinas, escuelas, restaurantes, hoteles y vehículos de transporte. Su eficacia se ve reforzada aún más por su
facilidad de uso: también se puede aplicar manualmente, asegurando una cobertura completa y uniforme del entorno tratado. Estamos aquí para proporcionar a nuestros clientes productos y servicios que superen las expectativas, para el bienestar de las personas y los entornos en los que vivimos y trabajamos. Descubre más sobre nuestras soluciones y el nuevo Catálogo ORMA 2024 visitando nuestro sitio web y conectándonos para obtener información adicional.
ormatorino.com | instagram.com/orma_srl
sponsored content






ORMA srl Via A. Chiribiri 2, 10028 Trofarello (TO) - Italy automatic solution Against flyes AND mosquitoes air control® S 1,75% pure pyrethine THE RIGHT solution! any problem? mastercid Micro® micro encapsulated liquid insecticide Tel: +39 011 64 99 064 aircontrol@ormatorino.it www.ormatorino.com
plus® rodenticides bait station rodenticides with: • brodifacoum
difenacoum
bromadiolon
virtual nova® uv fly trap 30 W -160 M² eurofly® uv fly trap 30/80 W - 200/350 M² scan for website
masterbox
•
•
•
Hospitality and technological development
The pandemic gave a significant boost to the adoption of technology in hotels. By understanding how to use technology as a tool to best connect human beings, the industry will set itself up to thrive in the years to come
edited by Giacomo Torrenzi
An estimated 1286 million international tourists (overnight visitors) were recorded around the world in 2023, an increase of 34% over 2022, or 325 million. International tourism recovered 88% of pre-pandemic levels in 2023, supported by strong pent-up demand. Europe reached 94% of pre-pandemic levels in 2023, while Africa recovered 96% and the Americas 90%.
Following a strong rebound in 2023, international tourism is expected to fully recover pre-pandemic levels this year, in 2024, with initial estimates pointing to 2% growth above 2019 levels in international tourist arrivals. The positive outlook for the sector is reflected in the latest UN Tourism Confidence Index survey, with 67% of tourism professionals indicating better or much better prospects for 2024
compared to 2023.
The unleashing of remaining pent-up demand, increased air connectivity, and a stronger recovery of Asian markets and destinations are expected to underpin a full recovery by the end of 2024. Economic and geopolitical challenges continue to pose significant challenges to the sustained recovery of international tourism and confidence levels.
A sudden development
The pandemic has contributed to give a decisive boost to the adoption of technology in hotels. Technology, labor, and service models that have been talked about for years have sprung into activation out of necessity, such as contactless, automation, and unbundling amenities and services from standard rates. Meanwhile, heavy in-
vestments in cloud technology and data security have enabled advanced technologies that seemed a long way of, not long ago. Artificial intelligence and predictive analytics, along with the rise of virtual reality and potential use of the metaverse, are being considered industry-wide in ways that would have been unimaginable years ago.
A research by Oracle and Skift conducted across nine global markets in five languages, asked to more than 5,000 consumers about what they expect from the next phase of hotel technology and services, and more than 600 hoteliers shared what they are most likely to implement, where they are in their investment cycles for new features and models, and tangible evidence of what they plan to do. Both guests and hotels agreed that contactless is king. More than 60 percent of
36 MARCH 2024
TOURISM

hospitality executives worldwide said that “a fully contactless experience for all basic hotel transactions, including check-in/out, food & beverage, room keys, etc.,” would be the most likely feature or technology that the industry will adopt widely in the next three years. The next-highest response, positioned in the survey as “a self service model, with hotel staff available only upon request,” garnered 31.2 percent of executive responses.
At the same time, more than half (53.6 percent) of travelers said that they’d most like to see contactless check-in and check-out remain a constant feature at hotels. Contactless payments were nearly as popular - 49.1 percent of travelers said they’d most like to see them permanently retained as they visit hotels in the future.
The data on contactless is illustrative
of a broader shift in the cultural mindset. Guests are not interested in technology solely for its own sake - it has to do something that enables a better experience. Tellingly, the technologies voted most popular among travelers in Oracle and Skift’s survey all share a common ability to provide personalized customer service throughout their journey. Travelers worldwide said that on-demand entertainment access - defined in the survey as “an in-room entertainment set-up that allows me to seamlessly access personal streaming or gaming accounts” - was the No. 1 “must-have” to create an amazing hotel stay in the future. What sounds like a relatively simple amenity can make or break a stay. While the delivery of these services may look different than in the past, ultimately travelers still simply want the
comforts and convenience they enjoy at home. Hotels have to give guests the ability to control their own environments and give them a smooth transition from their everyday lives. For example, no parent wants to spend the first hour of vacation with the kids screaming for their favorite show while they fumble around with the in-room entertainment system - or have to explain that “we can’t watch that show here.”
Beyond wanting hotels to meet their entertainment needs, guests showed strong interest in personalized amenities and services throughout the hotel. Nearly as many (43.2 percent) said they’d like voice-activated controls for all amenities in their rooms (such as lights, curtains, door locks, sinks, showers, TVs, etc.), and 34.4 percent want to use their own devices for ac-
37 MARCH 2024
cess throughout the hotel. In addition, 25.4 percent said they were interested in room controls that auto-adjust temperature, lighting, and even digital art, based on pre-shared preferences. Hotelier sentiment aligned with these expectations. Over the next three years, more than 40 percent of executives worldwide said they expected to implement on-demand entertainment access, voice controls, and the ability for guests to use their own devices to access their room and other areas of the property in place of a physical room key. In fact, 47.7 percent said that they were in some stage of the shift to replace key cards, and another 16.4 percent expect to begin that journey within the next year.
What about virtual reality?
As hoteliers consider future technology investments, there’s no question that virtual reality and metaverse applications for the hotel business will be a consideration. But unlike the other technologies that are “must-haves” today, VR technology is still in the warmup phase. For example, both travelers and hoteliers showed a high level of interest in virtual reality. More than
one-third of travelers that responded to Oracle and Skift’s survey said they want to explore a hotel virtually before they book. Meanwhile, almost half of executives said they are already developing VR maps of their hotels, or are planning to do so within the next year to accommodate such a feature. On the conference and events side of the business, metaverse meetings are all the buzz. Nearly half - 46.4 percent - of consumers that identified as frequent business travelers said that they were “very interested” in attending conferences remotely from their home or office through a metaverse experience. One-third of hospitality executives said they “want in on the ground floor” on VR events and conferences.
As showrunners start to experiment with virtual conferences, there’s much more than just the technology to consider. Just like in real life, they may be responsible for attendee safety, even if they’re not physically in the space.
“While the potential for fantastical metaverse venues has generated a lot of buzz, what’s less talked about is the complexity of making these spaces accessible and easy to navigate,” wrote Angela Tupper, deputy editor for Skift


Meetings. “Event organizers have a responsibility to ensure they aren’t risking the safety of their attendees when they ask them to ignore their real-world surroundings in favor of a VR venue. It’s reasons like these that VR and metaverse-related hotel amenities were among the least popular technology upgrades guests expect or hoteliers expected to implement by 2025. Just 7.8 percent of consumers said a VR console in the room was a “must-have” technology in the next three years, trailed only, notably, by “ability to pay with crypto” (5.0 percent). Meanwhile, only 4.0 percent of executives said they expect to implement VR consoles in the room at their hotel in the next three years, and just 11.2 percent said investing in the metaverse is among their three highest priorities. Although the latter may be higher than some might expect, it was still the least popular response.
Source: Skift and Oracle Hospitality, Hospitality in 2025: automated, intelligent… and more personal
38 MARCH 2024
Tab. 1: Technologies popularized by pandemic which travelers would like to see permanently adopted
TOURISM
Tab. 2: Technologies which, according to travelers, would be a must-have in the future
E-Tissue, the “First-Gen” recycled paper as strong yet delicate as pure pulp

The hospitality industry is increasingly connected to the concept of quality, waste reduction and sustainability. Sharing the same values,
Celtex offers to hotellerie specialists the E-Tissue line, the “first-gen” recycled paper which gives new life to pure pulp fibres and kraft offcuts, both recovered in pre-consumer phase. A clear example of circular economy able to combine performance, affordability and environmental commitment. E-Tissue has a delicate shade resulting from its sand-coloured kraft origin, a guarantee of maximum absorbency and resistance, even when wet with a non-invasive smell.
E-Tissue line covers the main demands of the Away From Home market, from industrial rolls, to handtowel and single-wrapped toilet paper, featuring an elegant decoration that furnishes the toilet with style and sophistication. E-Tissue paper is 100% natural, delicate
on the skin and PEFC and Ecolabel certified, in full respect of forests and the specific environmental cri-
guarantee of efficiency for hotels managers and an assurance of service availability for the customer.


teria required by the European Union. The special Flutech® technology allows toilet papers to dissolve in 15 seconds in contact with water in combination with the mechanical movement of the drain, preventing unpleasant pipe clogs. A
E-Tissue: performance, pleasantness and affordability, in full respect of the environment.
E-Tissue, el reciclado de primera generación fuerte y delicado como una pura celulosa
El sector de la hostelería está cada vez más conectado a conceptos de calidad, gestión de los desperdicios y a la ecosostenibilidad Celtex comparte estos valores proponiendo a los especialistas del mundo de la hostelería, E-Tissue, el papel reciclado de primera generación que da nueva vida a las fibras de la pura celulosa y a los residuos del papel kraft, ambos recuperados en pre-consumo. Un ejemplo de circularidad capaz de sumar rendimiento, conveniencia y compromiso medioambiental. Un papel con un delicado
color avana, que replica las principales características de las materias primas de las que proviene; una garantía de máxima absorción y resistencia, también en húmedo y que no deja olores desagradables. La línea E-Tissue cubre las principales exigencias del mercado profesional, desde las bobinas industriales y los secamanos, hasta el papel higiénico con fajas, que se caracteriza por una decoración elegante y delicada, que contribuye a decorar el baño con un estilo refinado. El papel es 100% natural, delicado con la piel y certifi-
cado PEFC y Ecolabel, en el respeto de los bosques y de los estandares pedidos por la Unión Europea. Gracias a la especial tecnología Flutech®, además los papeles higiénicos se disuelven en 15 segundos en combinación con el movimiento mecánico del WC, evitando problemas de atascos en las tuberías. Una garantía de eficacia para el gestor y una seguridad de disponibilidad de servicios para el cliente. E-Tissue; rendimiento, agradabilidad y conveniencia, en pleno respeto del medio ambiente.
39 MARCH 2024
industrieceltex.com sponsored content
HOSTELERÍA Y DESARROLLO TECNOLÓGICO
La pandemia dio un impulso significativo a la adopción de la tecnología en los hoteles. Si se sabe utilizar la tecnología como herramienta para conectar mejor a los seres humanos, el sector se preparará para prosperar en los próximos años
Se estima que en 2023 se registraron 1286 millones de turistas internacionales (visitantes que pernoctaron) en todo el mundo, lo que supone un aumento del 34% con respecto a 2022, es decir, 325 millones. El turismo internacional recuperó el 88% de los niveles anteriores a la pandemia en 2023, apoyado por una fuerte demanda reprimida. Europa alcanzó el 94% de los niveles prepandémicos en 2023, mientras que África se recuperó en un 96% y América en un 90%.
Tras un fuerte repunte en 2023, se espera que el turismo internacional recupere plenamente los niveles prepandémicos este año, en 2024, con estimaciones iniciales que apuntan a un crecimiento del 2% por encima de los niveles de 2019 en llegadas de turistas internacionales. Las perspectivas positivas para el sector se reflejan en la última encuesta del Índice de Confianza Turística de las Naciones Unidas, en la que el 67% de los profesionales del turismo indican unas perspectivas mejores o mucho mejores para 2024 en comparación con 2023.
Se espera que la liberación de la demanda reprimida restante, el aumento de la conectividad aérea y una mayor recuperación de los mercados y destinos asiáticos apuntalen una recuperación total a finales de 2024. Los retos económicos y geopolíticos siguen planteando importantes desafíos para la recuperación sostenida del turismo internacional y los niveles de confianza.
Una evolución repentina
La pandemia ha contribuido a dar un impulso decisivo a la adopción de la tecnología en los hoteles. La tecnología, la mano de obra y los modelos de servicio de los que se venía hablando desde hace años se han activado por necesidad, como el contactless, la automatización y la desagregación de comodidades y servicios de las tarifas estándar. Mientras tanto, las fuertes inversiones en tecnología en la nube y seguridad de los datos han hecho posibles tecnologías avanzadas que parecían muy lejanas, no hace mucho. La inteligencia artificial y el análisis predictivo, junto con el auge de la realidad virtual y el uso potencial del metaverso, se están considerando en todo el sector de formas que habrían sido inimaginables hace años. En un estudio realizado por Oracle y Skift en nueve mercados mundiales y en cinco idiomas, se preguntó a más de 5.000 consumidores qué esperan de la próxima fase de la tecnología y
los servicios hoteleros, y más de 600 hoteleros compartieron qué es más probable que implementen, en qué punto seencuentran sus ciclos de inversión para nuevas funciones y modelos, y pruebas tangibles de lo que tienen previsto hacer. Tanto los huéspedes como los hoteles coincidieron en que la tecnología sin contacto es la clave. Más del 60% de los ejecutivos del sector de la hostelería de todo el mundo afirmaron que "una experiencia totalmente sin contacto para todas las transacciones básicas del hotel, incluido el registro de entrada y salida, la comida y bebida, las llaves de las habitaciones, etc." sería la característica o tecnología que el sector adoptaría con mayor probabilidad en los próximos tres años. La siguiente respuesta más alta, posicionada en la encuesta como "un modelo de autoservicio, con personal del hotel disponible sólo bajo petición", obtuvo el 31,2% de las respuestas de los ejecutivos. Al mismo tiempo, más de la mitad (53,6%) de los viajeros dijeron que lo que más les gustaría es que el check-in y el check-out sin contacto siguieran siendo una característica constante en los hoteles. Los pagos sin contacto fueron casi igual de populares: el 49,1% de los viajeros dijeron que lo que más les gustaría es que se
mantuvieran de forma permanente cuando visiten hoteles en el futuro.
Los datos sobre los pagos sin contacto son ilustrativos de un cambio más amplio en la mentalidad cultural. A los huéspedes no les interesa la tecnología sólo por sí misma: tiene que hacer algo que permita mejorar la experiencia. Resulta revelador que las tecnologías más votadas por los viajeros en la encuesta de Oracle y Skift tengan en común la capacidad de ofrecer un servicio personalizado al cliente durante todo el viaje. Los viajeros de todo el mundo afirmaron que el acceso al entretenimiento a la carta - definido en la encuesta como "una instalación de entretenimiento en la habitación que me permita acceder sin problemas a cuentas personales de streaming o juegos" - era el "must-have" número 1 para crear una estancia increíble en un hotel en el futuro. Lo que parece un servicio relativamente sencillo puede marcar la diferencia en una estancia. Aunque la prestación de estos servicios puede parecer diferente a la del pasado, en última instancia los viajeros siguen queriendo simplemente las comodidades y el confort que disfrutan en casa. Los hoteles tienen que dar a los huéspedes la posibilidad de controlar su

Gráfico 1: Tecnologías popularizadas por la pandemia que a los viajeros les gustaría ver permanentemente adoptadas
40 MARCH 2024
TURISMO

Gráfico 2: Tecnologías que, según los viajeros, serían imprescindibles en el futuro
propio entorno y facilitarles una transición suave desde su vida cotidiana. Por ejemplo, ningún padre quiere pasarse la primera hora de vacaciones con los niños pidiendo a gritos su programa favorito mientras ellos tantean el sistema de entretenimiento de la habitación, o tener que explicarles que "aquí no podemos ver ese programa". Además de querer que los hoteles satisfagan sus necesidades de entretenimiento, los huéspedes mostraron un gran interés por las comodidadesy servicios personalizados en todo el hotel. Casi el mismo porcentaje (43,2%) dijo que les gustaría tener controles activados por voz para todos los servicios de sus habitaciones (como luces, cortinas, cerraduras de puertas, lavabos, duchas, televisores, etc.), y el 34,4% quiere utilizar sus propios dispositivos para acceder a todo el hotel. Además, el 25,4% dijo estar interesado en controles de habitación que autoajusten la temperatura, la iluminación e incluso el arte digital, basándose en preferencias compartidas.
La opinión de los hoteleros coincide con estas expectativas. En los próximos tres años, más del 40% de los ejecutivos de todo el mundo afirmaron que esperaban implantar el acceso al entretenimiento a la carta, los controles de voz y la posibilidad de que los huéspedes utilicen sus propios dispositivos para acceder a su habitación y a otras zonas del establecimiento en lugar de la llave física de la habitación. De hecho, el 47,7% afirmó que se encontraba en alguna fase del cambio para sustituir las llaves-tarjeta, y otro 16,4% espera iniciar ese camino en el próximo año.
¿Y la realidad virtual?
Cuando los hoteleros se planteen futuras inversiones en tecnología, no hay duda de que la realidad virtual y las aplicaciones metaversas para el negocio hotelero serán una consideración a tener en cuenta. Pero, a diferencia de otras tecnologías que hoy son "imprescindibles", la de la realidad virtual está aún en fase de calentamiento. Por ejemplo, tanto los viajeros como los hoteleros mostraron un gran interés por la realidad virtual. Más de un tercio de los viajeros que respondieron a la encuesta de Oracle y Skift dijeron que querían explorar un hotel virtualmente antes de reservar. Mientras tanto, casi la mitad de los ejecutivos afirmaron que ya están desarrollando mapas de realidad virtual de sus hoteles, o tienen previsto hacerlo en el próximo año para dar cabida a dicha función. En el sector de las conferencias y los eventos, las reuniones metaversas están de moda. Casi la mitad (el 46,4%) de los consumidores que se identifican como viajeros de negocios frecuentes afirmaron estar "muy interesados" en asistir a conferencias a distancia desde su casa u oficina a través de una experiencia metaversa. Un tercio de los ejecutivos del sector de la hostelería afirmaron que "quieren estar en la planta baja" de los eventos y conferencias de RV. Cuando los directores de programas empiecen a experimentar con las conferencias virtuales, habrá que tener en cuenta mucho más que la tecnología. Al igual que en la vida real, pueden ser responsables de la seguridad de los asistentes, aunque no estén físicamente en el espacio.
"Aunque el potencial de los metaversos fantásticos ha generado mucha expectación, de lo que menos se habla es de la complejidad de hacer que estos espacios sean accesibles y fáciles de recorrer", escribió Angela Tupper, redactora adjunta de Skift Meetings. Los organizadores de eventos tienen la responsabilidad de garantizar que no están poniendo en riesgo la seguridad de sus asistentes cuando les piden que ignoren su entorno real en favor de un lugar de RV". Por este tipo de razones, la RV y los servicios hoteleros relacionados con el metaverso se encuentran entre las actualizaciones tecnológicas menospopulares que los huéspedes esperan o que los hoteleros esperan implementar para 2025. Sólo el 7,8% de los consumidores dijo que una consola de RV en la habitación era una tecnología "imprescindible" en los próximos tres años, sólo superada, en particular, por la "posibilidad de pagar con criptomonedas" (5,0%). Mientras tanto, sólo el 4,0 por ciento de los ejecutivos dijeron que esperan implementar consolas de RV en la habitación de su hotel en los próximos tres años, y sólo el 11,2 por ciento dijo que la inversión en el metaverso está entre sus tres principales prioridades. Aunque esta última puede ser más alta de lo que algunos podrían esperar, sigue siendo la respuesta menos popular.
Fuente: Skift y Oracle Hospitality, La hostelería en 2025: automatizada, inteligente... y más personal

41 MARCH 2024
Service Robots
The service robot industry is more diverse and less tangible than the industrial robot industry. The International Federation of Robotics (IFR) Statistical Department is currently aware of 975 service robot producers worldwide. However, many companies are still in the funding or prototyping stage and intend to offer a marketable product in the future
edited by Cristina Cardinali

42 MARCH 2024
MARKET SURVEY
In 2023, the International Federation of Robotics (IFR) Statistical Department carried out for the 24th time a market survey of service robots. From a list of nearly 1,000 companies worldwide, a questionnaire was sent out to ask for data on sales in 2021 and 2022. Additional data was gained from desktop research conducted from July to August 2023.
IFR generally defines robots according to ISO 8373:2012. However, ISO definitions mentions only a few examples and does not provide a full list of industrial automation applications. IFR, therefore, developed its own application classification schemes for industrial robots and service robots. In contrast to the IFR industrial robot statistics, which counts robots only, IFR service robot statistics include robotic devices in some applications. Groundbased, aerial, and water-based vehicles are only included if they possess autonomous navigation capabilities that exceed a simple autopilot function.
Classification of Service Robots
A service robot is an actuated mechanism programmable in two or more axes, moving within its environment, to perform useful tasks for humans or equipment excluding industrial automation applications. IFR introduced a new scheme that distinguishes service robots along two dimensions: the robot application and the type of movement.
Four main types of movement have been envisaged for service robots: they can move on land (A), in water (B), in the air (C), wearable (D) or none of these (E). On the class-level, groundbased robots can either be rolling (A1), walking (A2), be fixed in place (A3), or have any other ground-based type of movement (A4). Water-based robots can either be swimming (B1) or diving (B2). Aerial robots are usually flying (C1) but there might also be hovering robots in the future (C2). Similarly,
wearable robots are powered exoskeletons (D1) today, but there might be other types of wearable robots (D2) in the future. Robots that do not fit into any of these classes, e.g. robots for orbital space or hybrid robots that fit into more than one of the above classes, can be classified as type E1. The classification of service robots by application provides two distinct categories: consumer robots (AC - “applications, consumer”) and professional service robots (AP - “applications,professional”).
Professional Service Robot Applications
The category of professional service robot applications uses eight different application groups plus group AP9 “other professional service robots” which is the appropriate class for all service robots that do not fit into any of the following groups and classes. Agricultural applications of all kinds are grouped in AP1. Professional cleaning robots are grouped in AP2. In analogy to domestic cleaning robots are divided into floor cleaning, and window and wall cleaning. Professional cleaning robots are also used for tank, tube, and pipe cleaning, hull cleaning. As a consequence of the Covid 19 pandemic, many companies offer disinfection robots. Robots for professional inspection and maintenance (AP3) are classified by the object that they are designed for: inspection of damage in building and civil construction of all kinds, Inspection of tanks, tubes, pipes, and sewers. There are also many robotic devices available that provide inspection and maintenance services with remote manual control, but they are not included in this group: at least some basic autonomous functions like navigation are required to qualify a machine as a robot. Group AP5 includes various logistics and transportation robots. Some logistics applications like packaging, pick and place, and palletizing are considered
industrial robotics and thus covered by the companion publication World Robotics Industrial Robots. Logistics also includes inventory management, e.g. counting and refilling of stock. The group of medical robotics (AP6) as the group of search and rescue and security robots (AP7) includes robotic devices. Hospitality robots (AP8) are used for food or drink preparation and for mobile guidance, information, or telepresence. Robots designed for various kinds of food delivery are grouped in AP5.
IFR’s Market Observation
The service robot industry is more diverse and less tangible than the industrial robot industry. IFR is currently aware of 975 service robot producers worldwide. However, many companies are still in the funding or prototyping stage and intend to offer a marketable product in the future.
In 2022, worldwide sales of professional service robots grew by 48%. Almost 158,000 units sold were registered by the IFR Statistical Department. The size of the RaaS fleet grew by 50% to more than 21,000 units. Mobile robot solutions are already established in transportation and logistics (AP5) with 44% more units sold in 2022. More than every other professional service robot sold in 2022 was built for the transportation of goods or cargo. Traditional sales remain the main channel of monetization, but RaaS business models enjoy growing popularity: The RaaS fleet grew by 67% in 2022. Hospitality robots (AP8) enjoy growing popularity. Sales were up 125% in 2022 and the RaaS fleet size is growing rapidly. Sales of medical robots (AP6) were down 4%. Robotics is an important part of digitalization in agriculture (AP1) with sales being up 18% in 2022. Demand for professional cleaning robots (AP2) grew by 8%. In the application group of search and rescue and security robots (AP7) sales were up 18%. There are several robotic devices for inspection
43 MARCH 2024
and maintenance (AP3) available, but the portfolio of robots that conduct inspection and maintenance tasks autonomously is still limited. Service robots for construction or demolition (AP4) tasks constitute a niche market. There is still an abundance of specific product opportunities to be taken up by companies, therefore creating an attractive commercial market worldwide. Today’s service robotics market is composed of many niche products for professional services and a few high-volume applications both for professional and domestic use. Pioneers in the field of service robotics stress the significant opportunities for new companies entering this growth market with innovative products beyond the occasional robotics hype. Service robots for professional use are extremely diverse since they are usually designed to perform a specific task. Cost-benefit considerations from an end-user’s viewpoint are the main factor with respect to investment in such systems in addition to contributing to qualified and safe jobs. Although service robots are as diverse as their appli-
ABOUT THE IFR SERVICE ROBOTS GROUP
Founded on October 9, 2002, the IFR Service Robots Group is open to all companies producing service robots, components, or related services. Next to the excellent networking opportunity, it is the right place to discuss all antitrustcompliant, industryrelevant issues and topics.



cations, three design categories can be distinguished: Modification of industrial robot components (e.g. automated warehousing and medical robots), use of advanced robot technology for the upgrading of high-end systems of existing product lines with automation functions. (e.g. cleaning, inspection), and new robotic designs “from scratch” (e.g. window cleaners, security robots).
Trends Market
The service robot industry is developing at a high pace with a lot of merger and acquisition activity. Many companies identify themselves as “deep tech”, meaning that they are willing to accept technological challenges during their product development phase to create technological advancement. Although the service robotics industry is a young and growing industry, 91% of the suppliers are considered incumbents. This includes mature service robot suppliers as well as companies from other industries that added service robots to their portfolio. The 2010s saw a wave of new service robot manufacturers. Since then, the number of newly established companies has steeply declined. IFR’s market observation suggests two reasons for the decreasing share: some market seg-

ments have already achieved a level of maturity that sees companies growing, for instance AMRs for warehouse logistics. Sales of AMRs have been growing strongly for many years now and companies grew and became incumbents. Further, founding activities shifted away from the development of robot hardware. Many service applications are based on collaborative industrial robots, purchased from an industrial robot producer. The service robot supplier is therefore not considered a robot producer as the robot is purchased from a third party. These companies act like a system integrator, combining different components and developing software to create a solution. The United States is home of most service robot suppliers. 218 companies are located there. China has 106 companies and in Germany 85 companies produce service robots. Japan has 72 service robot suppliers and France has 53 (see the graphic).
Source: Müller, Christopher; Kraus, Werner, Graf, Birgit; Bregler, Kevin (Eds.): World Robotics 2023 - Service Robots, IFR Statistical Department, VDMA Services GmbH, Frankfurt am Main, Germany, 2023.
44 MARCH 2024 MARKET SURVEY
Italian Sweeper Specialists

For MP-HT, an Italian company that designs and produces sweeping machines, innovating is synonym of “having a long view”, so understanding what is needed in order to better respond to the requests of a constantly evolving market. The desire of innovating
is always alive and springs from an idea, then converts into the creation of a prototype, up to the realization of high technological professional solutions. Manufacturing an innovative sweeper it means offering the best machine to manage effectively the different cle-
aning operations, to perform works in total safety and to optimize time. Today the direction is towards solutions that ensure a high degree of
cleanliness and hygiene but are also eco-friendly. In 2024 the MP-HT sweeper range will expand and two new machines will be presented.
Especialistas Italianos En Barredoras
Para MP-HT, una empresa italiana que diseña y fabrica máquinas barredoras, innovar significa “tener la vista larga”, entender lo que se necesita y responder mejor a un mercado en continua evolución. El deseo de innovar está siempre vivo y comienza desde la idea hasta la creación de prototipos, hasta la realización de soluciones profesionales de alta eficiencia tecnológica. Construir una barredora innovadora significa construir una máquina más fácil de usar, fácil de manejar y segura para el operador y las personas a su alrededor. Hoy en día, la tendencia se orienta hacia soluciones que garanticen un alto grado de limpieza e higiene, pero que también sean respetuosas con el medio ambiente. En 2024 se ampliará la gama de barredoras MP-HT y se presentarán dos nuevas máquinas.



mp-ht.it sponsored content
RELIABLE SWEEPERS, MADE TO LAST. Via Tamburin, 19 Limena (PD) ITALY +39 049 796 8360 www.mp-ht.it
ROBOTS DE SERVICIO
El sector de los robots de servicio es más diverso y menos tangible que el de los robots industriales. El Departamento de Estadística de la Federación Internacional de Robótica (IFR) tiene constancia de la existencia de 975 fabricantes de robots de servicio en todo el mundo. Sin embargo, muchas empresas aún se encuentran en fase de financiación o creación de prototipos y pretenden ofrecer un producto comercializable en el futuro
En 2023, el Departamento de Estadística de la Federación Internacional de Robótica (IFR) realizó por 24ª vez un estudio de mercado de robots de servicio. A partir de una lista de casi 1.000 empresas de todo el mundo, se envió un cuestionario para solicitar datos sobre las ventas en 2021 y 2022. Se obtuvieron datos adicionales a partir de una investigación documental realizada entre julio y agosto de 2023.
En general, el IFR define los robots según la norma ISO 8373:2012. Sin embargo, las definiciones de la ISO solo mencionan algunos ejemplos y no proporcionan una lista completa de aplicaciones de automatización industrial. Por ello, el IFR ha desarrollado sus propios esquemas de clasificación de aplicaciones para robots industriales y robots de servicio.
A diferencia de las estadísticas de robots industriales del IFR, que solo contabilizan robots, las estadísticas de robots de servicio del IFR incluyen dispositivos robóticos en algunas aplicaciones. Los vehículos terrestres, aéreos y acuá-
ticos sólo se incluyen si poseen capacidades de navegación autónoma que superen una simple función de piloto automático.
Clasificación de los robots de servicio
Un robot de servicio es un mecanismo accionado programable en dos o más ejes, que se mueve dentro de su entorno, para realizar tareas útiles para humanos o equipos, excluyendo las aplicaciones de automatización industrial. El IFR ha introducido un nuevo esquema que distingue los robots de servicio en dos dimensiones: la aplicación del robot y el tipo de movimiento. Se han previsto cuatro tipos principales de movimiento para los robots de servicio: pueden moverse en tierra (A), en el agua (B), en el aire (C), vestirse (D) o ninguno de ellos (E). A nivel de clase, los robots terrestres pueden rodar (A1), caminar (A2), estar fijos (A3) o tener cualquier otro tipo de movimiento terrestre (A4). Los robots acuáticos pueden nadar (B1) o bucear (B2). Los robots aéreos suelen volar
(C1), pero en el futuro también podría haber robots suspendidos (C2). Del mismo modo, los robots son exoesqueletos motorizados (D1) en la actualidad, pero podría haber otros tipos de robots vestibles (D2) en el futuro. Los robots que no encajan en ninguna de estas clases, por ejemplo los robots para el espacio orbital o los robots híbridos que encajan en más de una de las clases anteriores, pueden clasificarse como tipo E1.
La clasificación de los robots de servicio por aplicación ofrece dos categorías distintas: robots de consumo (AC - "aplicaciones, consumidor") y robots de servicio profesional (AP - "aplicaciones profesional").
Aplicaciones de robots de servicios profesionales
La categoría de aplicaciones de robots de servicios profesionales utiliza ocho grupos de aplicaciones diferentes más el grupo APU "otros robots de servicios profesionales", que es la clase adecuada para todos los robots de servi-



ESTUDIO DE MERCATO
cios que no encajan en ninguno de los grupos y clases siguientes.
Las aplicaciones agrícola de todo tipo se agrupan en AP1. Los robots de limpieza profesionales se agrupan en AP2. Por analogía con los robots de limpieza doméstica, se dividen en limpieza de suelos y limpieza de ventanas y paredes. Los robots de limpieza profesionales también se utilizan para la limpieza de tanques, tubos y tuberías, y la limpieza de cascos. Como consecuencia de la pandemia del Covid, muchas empresas ofrecen robots de desinfección. Los robots para inspección y mantenimiento profesional (AP3) se clasifican por el objeto para el que están diseñados: inspección de daños en edificios y construcciones civiles de todo tipo, inspección de tanques, tubos, tuberías y alcantarillas. También existen muchos dispositivos robóticos que prestan servicios de inspección y mantenimiento con control manual a distancia, pero no se incluyen en este grupo: para calificar una máquina como robot se requieren al menos algunas funciones autónomas básicas como la navegación. El grupo AP5 incluye varios robots de logística y transporte.
Algunas aplicaciones logísticas, como el embalaje, la recogida y colocación y el paletizado, se consideran robótica industrial y, por tanto, están cubiertas por la publicación complementaria World Robotics Industrial Robots. La logística también incluye la gestión de inventarios, como el recuento y reposición de existencias. El grupo de robótica médica (APG) como el de robots de búsqueda y rescate y seguridad (AP7) incluyen dispositivos robóticos. Los robots de hostelería (AP8) se utilizan para la preparación de alimentos o bebidas y para el guiado móvil, la información o la telepresencia. Los robots diseñados para diversos tipos de reparto de alimentos se agrupan en AP5.
ACERCA DEL GRUPO IFR SERVICE ROBOTS
Fundado el 9 de octubre de 2002, el Grupo de Robots de Servicio IFR está abierto a todas las empresas que producen robots de servicio, componentes o servicios relacionados. Además de la excelente oportunidad de establecer contactos, es el lugar adecuado para debatir todas las cuestiones y temas relacionados con el sector que cumplan las normas antimonopolio.
Observaciónes del IFR sobre el mercado
El sector de los robots de servicios es más diverso y menos tangible que el de los robots industriales. El IFR tiene constancia de la existencia de U75 fabricantes de robots de servicio en todo el mundo. Sin embargo, muchas empresas aún se encuentran en fase de financiación o de creación de prototipos con la intención de ofrecer un producto comercializable en el futuro. En 2022, las ventas mundiales de robots de servicio profesionales crecieron un 48%. El Departamento de Estadística del IFR registró casi 158.000 unidades vendidas. El tamaño de la flota de RaaS creció un 50% hasta superar las 21.000 unidades. Las soluciones robóticas móviles ya se han establecido en el transporte y la logística (AP5), con un 44% más de unidades vendidas en 2022. Más de uno de cada dos robots de servicios profesionales vendidos en 2022 seconstruyó para el transporte de mercancías o carga. Las ventas tradicionales siguen siendo el principal canal de monetización, pero los modelos de negocio RaaS gozan de una popularidad creciente: La flota de RaaS creció un 67% en 2022. Los robots de hostelería (AP8) disfrutan de una popularidad creciente. Las ventas aumentaron un 125% en 2022 y el tamaño de la flota RaaS está creciendo rápidamente. Las ventas de robots médicos (APG) descendieron un 4%. La robótica es una parte importante de la digitalización en la agricultura (AP1), con un aumento de las ventas del 18% en 2022. La demanda de robots de limpieza profesional (AP2) creció un 8%. En el grupo de aplicaciones de robots de búsqueda y rescate y seguridad (AP7), las ventas aumentaron un 18%. Existen varios dispositivos robóticos para inspección y mantenimiento (AP3), pero la cartera de robots que realizan tareas de inspección y mantenimiento de forma autónoma es todavía limitada. Los robots de servicio para tareas de construcción o demolición (AP4) constituyen un nicho de mercado. Las empresas aún pueden aprovechar muchas oportunidades de productos específicos, lo que crea un atractivo mercado comercial en todo el mundo. El mercado actual de la robótica de servicio se compone de muchos productos nicho para servicios profesionales y unas pocas aplicaciones de gran volumen tanto para uso profesional como doméstico. Los pioneros en el campo de la robótica de servicio subrayan las importantes oportunidades que se abren a las nuevas empresas que se incorporan a este mercado en crecimiento con productos innovadores que van más allá del bombo ocasional de la robótica.
Los robots de servicio para uso profesional son muy diversos, ya que suelen estar diseñados para realizar una tarea específica. Las consideraciones de coste-beneficio desde el punto de vista del usuario final son el principal factor a la hora de invertir en estos sistemas, además de contribuir a la cualificación y seguridad de los puestos de trabajo. Aunque los robots de ser-
vicio son tan diversos como sus aplicaciones, pueden distinguirse tres categorías de diseño: Modificación de componentes de robots industriales (por ejemplo, robots médicos y de almacenamiento automatizado), uso de tecnología robótica avanzada para la actualización de sistemas de gama alta de líneas de productos existentes con funciones de automatización. (por ejemplo, limpieza, inspección), y nuevos diseños robóticos "desde cero" (por ejemplo, limpiacristales, robots de seguridad).
Tendencias del mercado
El sector de los robots de servicios se está desarrollando a un ritmo vertiginoso, con una gran actividad de fusiones y adquisiciones. Muchas empresas se identifican como "deep tech", lo que significa que están dispuestas a aceptar retos tecnológicos durante la fase de desarrollo de sus productos para crear avances tecnológicos.
Aunque el sector de la robótica de servicios es una industria joven y en crecimiento, el 91% de los proveedores se consideran incumbentes. Esto incluye proveedores de robots de servicio maduros, así como empresas de otras industrias que añadieron robots de servicio a su cartera. En la década de 2010 se produjo una oleada de nuevos fabricantes de robots de servicio. Desde entonces, el número de empresas de nueva creación ha disminuidoconsiderablemente. La observación del mercado del IFR sugiere dos razones para la disminución de la cuota: algunos segmentos del mercado ya han alcanzado un nivel de madurez que permite a las empresas crecer, por ejemplo los AMR para logística de almacenes. Las ventas de AMR llevan muchos años creciendo con fuerza y las empresas crecieron y se convirtieron en incumbentes. Además, las actividades de fundación se alejaron del desarrollo de hardware robótico. Muchas aplicaciones de servicios se basan en robots industriales colaborativos, adquiridos a un fabricante de robots industriales. Por tanto, el proveedor de robots de servicio no se considera un productor de robots, ya que el robot se compra a un tercero. Estas empresas actúan como un integrador de sistemas, combinando distintos componentes y desarrollando software para crear una solución. Estados Unidos acoge a la mayoría de los proveedores de robots de servicio. Allí se encuentran 218 empresas. China cuenta con 106 empresas y en Alemania 85 fabrican robots de servicio. Japón cuenta con 72 proveedores de robots de servicio y Francia con 53 (véase el gráfico).
Fuente: Müller, Christopher; Kraus, Werner, Graf, Birgit; Bregler, Kevin (Eds.): World Robotics 2023 - Service Robots, IFR Statistical Department, VDMA Services GmbH, Fráncfort del Meno, Alemania, 2023.
47 MARCH 2024
ARIES 70
Powerful and robust
Aries 70 is the first walk-behind floor-cleaning machine designed by Adiatek.
Two front trays facilitate emptying operations by the operator: the two trays have a low weight with a full load, an important factor when having to clean outdoor yards or environments with sand and other high-density materials. The trays are also visible with a simple locking and extraction system that does not require lifting or removal of any parts for unloading operations.
The broad dashboard has all the machine’s controls indicated with symbols that are easy and intuitive to understand and that allow the operator to easily approach the job.
The machine is equipped with a dual-wing electric filter shaker that allows for spreading the impulse on a broad surface for effective removal of dust from the panel filter.
www.adiatek.com

14-15-16-17 MAY Hall 2.113

The future of the autonomous cleaning

R-QUARTZ was designed following the Quartz 66-80 model, a highlevel performances and technical features scrubber.
Thanks to a 100l capacity solution tank and the Solution Saving System Dispenser (3SD) as standard equipment, it is possible to precisely adjust the consumptions, granting up to 4 hours of continuous work.
The 24V 330Ah Lithium battery pack, offers up to 6 hours of autonomy and a 5 hour fast charge.
R-QUARTZ has two different learning modes and the possibility to create work sequences combining different routes which were memorized with different modes and with different features between each other.
The dashboard is provided with a 7” touch screen which allows an easy and intuitive communication between the machine and the operator.
The machine is always in touch with the user thanks to the
TELEMATICS system.
The operator can always monitor the sequence on the map, the time left to complete the job and the eventual indications and warnings that the machine signals; it is possible also the receive real-time notices transmitted by the machine directly on the smartphone.
www.adiatek.com
Professional cleaning and hygiene Trends for 2024
There is a great potential for innovation in the cleaning and hygiene industry. Let’s see all the new technologies that will reshape the way we think about cleanliness
edited by Simone Ciapparelli
Like many other fields, the cleaning industry is experimenting with the use of advanced technologies and innovations to improve work efficiency while optimizing time, reducing human effort, and operating in the most environmentally sustainable way possible.
As explained in the report by Interclean The future is crystal clean: 10 innovations and trends in professional cleaning and hygiene for 2024 , this should be a promising year for the professional cleaning and hygiene industry, with trends and innovations ready to change cleanliness across diverse sectors.
Food Service and Hospitality
Restaurant furniture and surfaces will be treated with antimicrobial coatings to combat the spread of germs, boosting guest confidence and hygiene lev-
els. Robots will handle tasks like floor cleaning, dishwashing, and even disinfecting surfaces, improving hygiene standards and freeing up staff for guest interaction.
Smart thermometers and blockchain technology will track food preparation temperatures and ingredient provenance, minimizing the risk of foodborne illnesses.
More safety for healthcare
Remotely operated robots will disinfect contaminated areas, minimising patient and staff exposure to hazardous materials. Robots equipped with UV-C light or other antimicrobial technologies will target high-touch surfaces and critical areas to combat hospital-acquired infections (HAIs). Smart sensors will detect air quality, temperature, and even pathogen presence, prompting proactive cleaning
and real-time alerts for potential outbreaks. As for the safety of surfaces, in high-traffic areas they will be coated with self-cleaning nano-coatings that repel dirt and germs, reducing the need for frequent cleaning.
Smart office spaces
Cleaning robots and sensor networks will become seamlessly integrated with building management systems, optimizing cleaning schedules and resource allocation based on occupancy and air quality data. Natural elements like plants and natural materials into office spaces will be paired with eco-friendly cleaning solutions, promoting both physical and mental wellbeing.
Voice-activated handwashing stations, automated door openers, and sensor-triggered sanitizing dispensers will minimize contact with po -
50 MARCH 2024
TECHNOLOGY & TRENDS

tential germ hotspots. Cleaning schedules will be dynamically adjusted based on real-time data about foot traffic, occupancy patterns, and potential allergen levels, ensuring targeted and efficient hygiene practices.
The revolution of Virtual and Augmented reality VR and AR are a big trend that could transform the way in which cleaning and hygiene staff learn and work. AR is the technology that blends digital information or images into the real world via devices such as smartphones, tab -
lets or AR glasses. For example, AR can be used to create interactive education and training programs for cleaners. Through AR glasses or mobile devices, virtual training content can be superimposed over real work environments. VR training modules can recreate any cleaning scenario, from hospital wards to office kitchens, allowing trainees to practice proper protocol in a safe, controlled environment. They can learn proper cleaning techniques and receive instant feedback on their performance. This immersive training can boost knowledge retention and also
build confidence and prepare staff for any cleaning challenge.
AR can overlay visual guidance and work instructions over real-world scenarios in real time. This can improve the accuracy and efficiency of cleaning processes, as employees know exactly which steps to perform and in what order.
AR overlays digital information onto the real world, turning any environment into a training ground. For example, staff can wear smart glasses that display cleaning protocols for specific surfaces, highlight areas requiring disinfection or provide step-by-step
51 MARCH 2024

instructions for operating complex equipment. Real-time guidance reduces errors and empowers staff to tackle any cleaning task with precision and efficiency. VR can transform the act of learning into a video game: gamified VR training modules can turn cleaning into a virtual competition, awarding points for proper technique and speed.
AR can display cleaning progress visualized through augmented reality, creating a sense of accomplishment and satisfaction with each completed task. This increased engagement leads to better learning outcomes and a more motivated workforce.
But the benefits of this technology extend beyond training: AR can also be used to detect defects or soiling that are difficult to see with the naked eye. Cameras can capture images of surfaces, and AR software can highlight irregularities or provide instructions on how to fix problems.
The surge of Internet of Things IoT can streamline and optimize processes and protocols. Buildings are able to communicate valuable data about every surface, every air particle, every movement. Smart floors embedded with pressure sensors can reveal which areas are most heavily trafficked and need priority cleaning. Walls painted with air quality sensors can map out invisible pollution patterns, guiding targeted disinfection efforts. Gathering data about the amount of people that go in the office, when they go into the office and what they are doing in the office allows us to understand what part of the building needs to be cleaned, saving labor,
cleaning materials, costs and time. Optimized cleaning schedules will emerge, dynamically adjusting to real-time data, ensuring high-traffic areas are spotless during peak usage while lower-traffic zones receive the attention they deserve, avoiding wasted effort and missed spots.
Data isn’t just about efficiency but it’s also about hygiene on a microscopic level. Sensors detect specific pathogens on surfaces, revealing previously invisible contamination patterns. AI analyzes these patterns, identifying high-risk areas and even predicting potential outbreaks. Data allows for proactive interventions, preventing threats before they blossom into fullblown problems. All this without forgetting the human touch: the use of data and technology is effective only if employed alongside human expertise.
Exoskeletons are an increasingly used technology that can reduce physical strain preventing musculoskeletal injuries and fatigue

52 MARCH 2024 TECHNOLOGY & TRENDS
AR glasses can overlay visual guidance and work instructions over real-world scenarios in real time
Wearable innovations and exoskeletons
Technology is bringing to the table wearable technologies which can monitor and guide the crews through cleaning tasks. Wristbands equipped with RFID (radio frequency identification) tags can track cleaning progress recording which areas have been cleaned and ensure nothing gets missed.
Wearables can track factors like heart rate and temperature, alerting supervisors to potential fatigue or heat stress, protecting worker health. Real-time data on workload and cleaning times can be used to create efficient cleaning routes, saving time and effort.
Exoskeletons are an increasingly used technology that can reduce physical strain supporting the weight of heavy equipment and tools, preventing musculoskeletal injuries and fatigue. The cleaner's lifting capacity is increased, allowing them to handle heavier loads with ease. Exoskeletons can also adjust to individual body shapes and postures, promoting proper form and reducing the risk of back pain.
Data-driven cleaning
Once seen as a strictly physical domain, the world of professional cleaning is undergoing a data-driven metamorphosis. Data science and AI are transforming the industry, casting light on previously hidden aspects of cleaning efficacy and efficiency. Sensors embedded in cleaning tools, si-
lently collecting data with every swipe and scrub, from pressure applied to surfaces cleaned, will communicate valuable insights to data scientists. Algorithms then analyze these numbers, revealing what tools truly perform best on specific surfaces, optimizing cleaning routines for speed and thoroughness.
As for building spaces, algorithms will substitute static schedules, dynamically dispatching cleaning crews based on real-time data, ensuring high traffic areas are spotless during peak usage, while lower-traffic zones receive the attention they deserve without unnecessary effort. But the data revolution isn’t just about robots and algorithms. It’s about empowering cleaning professionals with actionable insights. Cleaning staff can be equipped with AI-powered tablets, displaying real-time information on surface cleanliness, potential contamination hotspots, and optimized cleaning routes. This data-driven partnership between humans and technology elevates cleaning from a chore to a science, ensuring a truly sparkling future for all. Some innovations such as AI-powered drones or advanced predictive analysis might appear a bit futuristic, but they paint an exciting and promising picture of the cleaning industry’s high tech horizon.
Big Data: what about privacy? Behind all this technological shine, a problem emerges: data privacy. Whose
THE SHIFT TO ESG PRINCIPLES
The professional cleaning and hygiene industry is undergoing a significant shift, driven by the rising importance of Environmental, Social, and Governance (ESG) principles. Procurement teams are playing a crucial role in this transformation, pushing for suppliers and service providers to prioritize
sustainability, ethical practices, and social responsibility.
Procurement teams are seeking cleaning products and equipment with reduced environmental impact. This includes looking for biodegradable and non-toxic cleaning solutions, energy-efficient equipment, and
data are tracked, the building owner’s, the cleaning company’s, or even the individual cleaners? Clear ownership and consent protocols are fundamental. What data is collected? Is it limited to cleaning specifics, or does it delve deeper into building usage, employee schedules, or even personal health data through air quality sensors? Transparency and purpose limitation are key. How is data used and secured? Will insights be anonymous and aggregated, or will individual cleaning patterns be identifiable? Robust security measures and clear deletion policies are essential. Who has access to the data? Is it limited to authorized cleaning personnel and building management, or will third-party vendors be involved? Access control and audit trails are paramount. Regulatory frameworks need to evolve to keep pace with these innovations. Data protection laws must be revised to address the specific challenges of cleaning data, ensuring responsible collection, use, and disposal. The potential of AI-powered cleaning is undeniable, but ensuring data privacy needs to be an integral part of the conversation. Building trust is a continuous process, and AI-powered cleaning companies must actively engage with clients and address concerns head-on.
Source: Interclean, The future is crystal clean: 10 innovations and trends in professional cleaning and hygiene for 2024
sustainable packaging practices. The focus extends beyond products, with procurement teams considering the environmental footprint of cleaning services themselves, encouraging the use of electric cleaning vehicles and optimizing routes to reduce emissions.
LIMPIEZA E HIGIENE PROFESIONAL LAS TENDENCIAS PARA 2024
Existe un gran potencial de innovación en el sector de la limpieza. Veamos las nuevas tecnologías que cambiarán nuestra forma de concebir la higiene.

Al igual que muchos otros campos, la industria de la limpieza está experimentando con el uso de tecnologías avanzadas e innovaciones para mejorar la eficiencia del trabajo a la vez que se optimiza el tiempo, se reduce el esfuerzo humano y se opera de la forma más sostenible posible para el medio ambiente.
Como se explica en el informe de Interclean
El futuro es limpio como el cristal: 10 innovaciones y tendencias en limpieza e higiene profesional para 2024 , este debería ser un año prometedor para la industria de la limpieza e higiene profesional, con tendencias e innovaciones listas para cambiar la limpieza en diversos sectores.
Servicios de alimentación y hospitalidad
El mobiliario y las superficies de los restaurantes se tratarán con revestimientos antimicrobianos para combatir la propagación de gérmenes, lo que aumentará la confianza de los clientes y los niveles de higiene. Los robots se encargarán de tareas como la limpieza de suelos, el lavado de vajilla e incluso la desinfección de superficies, mejorando los niveles de higiene y liberando personal para la interacción con los huéspedes.
Los termómetros inteligentes y la tecnología blockchain rastrearán las temperaturas de preparación de los alimentos y la procedencia de los ingredientes, minimizando el riesgo de enfermedades transmitidas por los alimentos.
Más seguridad para la atención sanitaria
Robots telecomandados desinfectarán zonas contaminadas, minimizando la exposición de pacientes y personal a materiales peligrosos. Los robots equipados con luz UV-C u otras tecnologías antimicrobianas se centrarán en las superficies que más se tocan y en las zonas críticas para combatir las infecciones hospitalarias. Los sensores inteligentes detectarán la calidad del aire, la temperatura e incluso la presencia de patógenos, lo que impulsará una limpieza proactiva y alertas en tiempo real de posibles brotes. En cuanto a la seguridad de las superficies, en las zonas de mucho tránsito se recubrirán con nanorevestimientos autolimpiables que repelen la suciedad y los gérmenes, reduciendo la necesidad de limpiezas frecuentes.
Espacios de oficina inteligentes
Los robots de limpieza y las redes de sensores se integrarán a la perfección con los sistemas de gestión de edificios, optimizando los horarios de limpieza y la asignación de recursos en función de los datos de ocupación y calidad del aire. Los elementos naturales como las plantas y los materiales naturales en los espacios de oficina se combinarán con soluciones de limpieza respetuosas con el medio ambiente, fomentando el bienestar físico y mental. Los lavamanos activados por voz, las puertas automáticas y los dispensadores de productos higiénicos activados por sensores minimizarán el contacto con
posibles focos de gérmenes.
Los programas de limpieza se ajustarán dinámicamente en función de los datos en tiempo real sobre el tráfico peatonal, los patrones de ocupación y los posibles niveles de alérgenos, garantizando prácticas de higiene específicas y eficientes.
La revolución de la realidad virtual y aumentada
La realidad virtual y la realidad aumentada son una gran tendencia que podría transformar la forma en que el personal de limpieza e higiene aprende y trabaja. La RA es la tecnología que mezcla información o imágenes digitales en el mundo real a través de dispositivos como teléfonos inteligentes, tabletas o gafas de RA. Por ejemplo, la RA puede utilizarse para crear programas interactivos de educación y formación para limpiadores. A través de gafas de realidad aumentada o dispositivos móviles, el contenido de formación virtual puede superponerse a entornos de trabajo reales.
Los módulos de formación de RV pueden recrear cualquier escenario de limpieza, desde salas de hospital hasta cocinas de oficinas, permitiendo a los alumnos practicar el protocolo adecuado en un entorno seguro y controlado. Pueden aprender técnicas de limpieza adecuadas y recibir información instantánea sobre su rendimiento. Esta formación inmersiva puede aumentar la retención de conocimientos, además de generar confianza y preparar al personal para cualquier reto de limpieza.
La realidad aumentada puede superponer guías visuales e instrucciones de trabajo sobre escenarios del mundo real en tiempo real. Esto puede mejorar la precisión y la eficacia de los procesos de limpieza, ya que los empleados saben exactamente qué pasos deben realizar y en qué orden. La realidad aumentada superpone información digital al mundo real, convirtiendo cualquier entorno en un campo de entrenamiento. Por ejemplo, el personal puede llevar gafas inteligentes que muestren protocolos de limpieza para superficies específicas, resalten las zonas que requieren desinfección o proporcionen instrucciones paso a paso para manejar equipos complejos. La orientación en tiempo real reduce los errores y capacita al personal para abordar cualquier tarea de limpieza con precisión y eficacia. La RV puede transformar el acto de aprender en un videojuego: los módulos de formación de RV gamificados pueden con-
54 MARCH 2024
TECNOLOGÍA Y TENDENCIAS
vertir la limpieza en una competición virtual, otorgando puntos por la técnica adecuada y la velocidad. La RA puede mostrar el progreso de la limpieza visualizado a través de la realidad aumentada, creando una sensación de logro y satisfacción con cada tarea completada. Este mayor compromiso conduce a mejores resultados de aprendizaje y a una manode obra más motivada. Pero las ventajas de esta tecnología van más allá de la formación: La RA también puede utilizarse para detectar defectos o suciedad difíciles de ver a simple vista. Las cámaras pueden capturar imágenes de las superficies, y el software de RA puede resaltar las irregularidades o proporcionar instrucciones sobre cómo solucionar los problemas.
El auge del Internet de las Cosas IoT puede agilizar y optimizar procesos y protocolos. Los edificios pueden comunicar datos valiosos sobre cada superficie, cada partícula de aire, cada movimiento. Los suelos inteligentes dotados de sensores de presión pueden revelar qué zonas son más transitadas y necesitan una limpieza prioritaria. Las paredes pintadas con sensores de calidad del aire pueden trazar patrones de contaminación invisibles y orientar los esfuerzos de desinfección. Recopilar datos sobre la cantidad de gente que entra en la oficina, cuándo entra y qué hace en ella permite saber qué parte del edificio hay que limpiar, ahorrando mano de obra, materiales de limpieza, costes y tiempo. Aparecerán programas de limpieza optimizados, que se ajustarán dinámicamente a los datos en tiempo real, garantizando que las zonas de mayor tráfico estén impecables durante los picos de uso, mientras que las zonas de menor tráfico reciben la atención que merecen, evitando esfuerzos inútiles y puntos perdidos. Los datos no sólo tienen que ver con la eficiencia, sino también con la higiene a nivel microscópico. Los sensores detectan patógenos específicos en las superficies, revelando patrones de contaminación antes invisibles. La IA analiza estos patrones, identificando zonas de alto riesgo e incluso prediciendo posibles brotes. Los datos permiten intervenciones proactivas, previniendo amenazas antes de que se conviertan en problemas en toda regla. Todo ello sin olvidar el toque humano: el uso de datos y tecnología sólo es eficaz si se emplea junto con la experiencia humana.
Innovaciones portátiles y exoesqueletos
La tecnología está poniendo sobre la mesa tecnologías portátiles que pueden supervisar y guiar al personal en las tareas de limpieza. Las pulseras equipadas con etiquetas RFID (identificación por radiofrecuencia) permiten seguir el progreso de la limpieza, registrar las zonas que se han limpiado y asegurarse de que no se pasa nada por alto.
Los dispositivos portátiles pueden controlar factores como la frecuencia cardiaca y la tem-
peratura, alertando a los supervisores de posibles fatigas o golpes de calor y protegiendo así la salud de los trabajadores. Los datos en tiempo real sobre la carga de trabajo y los tiempos de limpieza pueden utilizarse para crear rutas de limpieza eficientes, ahorrando tiempo y esfuerzo. Los exoesqueletos son una tecnología cada vez más utilizada que puede reducir el esfuerzo físico soportando el peso de equipos y herramientas pesados, evitando lesiones musculo esqueléticas y fatiga. La capacidad de elevación del limpiador aumenta, lo que le permite manejar cargas más pesadas con facilidad. Los exoesqueletos también pueden ajustarse a las formas y posturas corporales individuales, fomentando una forma adecuada yreduciendo el riesgo de dolor de espalda.
Limpieza basada en datos
El mundo de la limpieza profesional, antes considerado un ámbito estrictamente físico, está experimentando una metamorfosis impulsada por los datos. La ciencia de los datos y la IA están transformando el sector, arrojando luz sobre aspectos antes ocultos de la eficacia y la eficiencia de la limpieza. Los sensores integrados en las herramientas de limpieza, que recogen silenciosamente datos con cada pasada y fregado, desde la presión aplicada hasta las superficies limpiadas, comunicarán información valiosa a los científicos de datos. A continuación, los algoritmos analizarán estas cifras y revelarán qué herramientas funcionan realmente mejor en superficies específicas, optimizando las rutinas de limpieza para que sean más rápidas y minuciosas. En cuanto a los espacios de los edificios, los algoritmos sustituirán a los programas estáticos y enviarán equipos de limpieza de forma dinámica basándose en datos en tiempo real, garantizando que las zonas de mucho tráfico estén impecables durante los picos de uso, mientras que las zonas de menos tráfico reciben la atención que merecen sin esfuerzos innecesarios. Pero la revolución de los datos no consiste sólo en robots y algoritmos. Se trata de dotar a los profesionales de la limpieza de información práctica. El personal de limpieza puede equiparse con tabletas dotadas de inteligencia artificial que muestren información en tiempo real sobre la limpieza de las superficies, los posibles focos de contaminación y las rutas de limpieza optimizadas. Esta asociación basada en datos entre humanos y tecnología hace que la limpieza deje de ser una tarea para convertirse en una ciencia, garantizando un futuro realmente brillante para todos. Algunas innovaciones, como los drones impulsados por inteligencia artificial o los análisis predictivos avanzados, pueden parecer un poco futuristas, pero dibujan un panorama emocionante y prometedor del horizonte de alta tecnología del sector de la limpieza.
Big Data: ¿y la privacidad? Detrás de todo este brillo tecnológico, surge un
problema: la privacidad de los datos. ¿De quién son los datos que se rastrean, del propietario del edificio, de la empresa de limpieza o incluso de los propios limpiadores? Es fundamental contar con protocolos claros de propiedad y consentimiento.
¿Qué datos se recopilan? ¿Se limitan a los datos específicos de la limpieza o se profundiza más en el uso del edificio, los horarios de los empleados o incluso los datos personales de salud a través de sensores de calidad del aire? La transparencia y la limitación de los fines son fundamentales.
¿Cómo se utilizan y protegen los datos? ¿Serán anónimos y agregados, o se podrán identificar patrones de limpieza individuales? Es esencial contar con medidas de seguridad sólidas y políticas de eliminación claras. ¿Quién tiene acceso a los datos? ¿Se limita al personal de limpieza autorizado y a la dirección del edificio, o intervienen proveedores externos? El control de acceso y las pistas de auditoría son primordiales. Los marcos normativos deben evolucionar para seguir el ritmo de estasinnovaciones. Las leyes de protección de datos deben revisarse para abordar los retos específicos de los datos de limpieza, garantizando una recopilación, uso y eliminación responsables. El potencial de la limpieza impulsada por IA es innegable, pero garantizar la privacidad de los datos debe formar parte integral de la conversación. Generar confianza es un proceso continuo, y las empresas de limpieza asistida por IA deben comprometerse activamente con los clientes y abordar las preocupaciones de frente.
El cambio hacia los principios ESG
El sector de la limpieza y la higiene profesionales está experimentando un cambio significativo, impulsado por la creciente importancia de los principios medioambientales, sociales y de gobernanza (ESG). Los equipos de compras están desempeñando un papel crucial en esta transformación, presionando a los proveedores y prestadores de servicios para que den prioridad a la sostenibilidad, las prácticas éticas y la responsabilidad social. Los equipos de compras buscan productos y equipos de limpieza con un impacto medioambiental reducido. Esto incluye la búsqueda de soluciones de limpieza biodegradables y no tóxicas, equipos energéticamente eficientes y prácticas de envasado sostenibles. La atención se extiende más allá de los productos, y los equipos de contratación tienen en cuenta la huella medioambiental de los propios servicios de limpieza, fomentando el uso de vehículos de limpieza eléctricos y optimizando las rutas para reducir las emisiones.
Fuente: Interclean, El futuro es limpio como el cristal: 10 innovaciones y tendencias en limpieza e higiene profesional para 2024
55 MARCH 2024
Hospitality and maximum hygiene first and foremost: hotel floors and RCM cleaning systems
The stay in a hotel must put at ease the guests in a structure always up to standard, always clean, always welcoming.
If you book your stay in a hotel, whether for a single night or for a long holiday, you want to feel spoiled: the environment must be not only comfortable, but impeccable. Cleanliness,
service and attention are very important not to make the customer feel at home, but to spoil him and make him feel at the center of his stay experience.
As far as the cleaning of hotel floors is concerned, this activity is often entrusted to specialised cleaning companies.
Whether it is a cleaning

La hospitalidad y la máxima higiene son ante todo: suelos de hoteles y sistemas RCM de limpieza
La estancia (por negocios o placer) en un hotel debe poner a gusto a los huéspedes en una estructura siempre a la altura, siempre limpia, siempre acogedora. Si reserva su estancia en un hotel, ya sea para una sola noche o para unas largas va-
company or the hotel staff who clean the floors, the RCM scrubbers are suitable for all types of floors (clay, wood, marble, pvc..).
In addition to scheduled or extraordinary cleaning, owning one or more scrubbers can be an extraordinary aid in the cleaning of hotel environments. The lobby,
the kitchen, the restaurant, the rooms, the corridors, the wellness centre... everything will always be clean, with just one passage.
In addition, the use of a sweeper can make it easy to clean the outside areas, the parking lot, the patio … For a structure always ready to welcome guests!

caciones, quiere sentirse viciado: el entorno debe ser no sólo confortable, sino también impecable. La limpieza, el servicio y la atención son muy importantes no para hacer que el cliente se sienta como en casa, sino para visitarlo y hacer que se sienta en el centro de la experiencia de su estancia.
En lo que se refiere a la limpieza de los suelos de los hoteles, esta actividad se confía a empresas de limpieza especializadas. Tanto si se trata de una empresa de limpieza como del personal del hotel que limpia los suelos, las fregadoras RCM son adecua-
das para todo los suelos (terracota, madera, mármol, pvc…).
Además de la limpieza programada o extraordinaria, poseer una o más fregadoras puede ser una ayuda extraordinaria en la limpieza de los ambientes de los hoteles. El hall, la cocina, el restaurante, las habitaciones, los pasillos, el centro de bienestar… todo estará siempre limpio, con un solo pasaje. Además, el uso de una barredora puede facilitar la limpieza de las zonas exteriores, el aparcamiento, el patio… Para una estructura siempre lista para recibir a los huéspedes!
56 MARCH 2024
rcm.it sponsored content








www.rcm.it

THERE IS ALWAYS A RED ONE JUST FOR YOU.



ICON is a professional scrubber-drier, compact and agile, with an high productivity rate, to be used on mediumbig size areas, even in narrow passages and difficult lay-outs. It is available in 3 versions: 1000 mm cleaning width with rolling brushes, 900 and 1000 mm cleaning width with disk brushes. Quiet, to work without disturbing and safe even in crowdy places, because of the front LED light.

57 MARCH 2024
EFCI’s role in European policies
A conversation with the Director General of EFCI Matteo Matarazzo, who in Brussels is responsible for advancing the needs and demands of the corporate world of cleaning and facility management
Maurizio Pedrini


58 MARCH 2024
EU OBSERVATORY
Matteo Matarazzo, Director General of EFCI (European Cleaning and Facility Services Industry), in Brussels carries out the delicate and demanding task of taking care of the General Management of the international non-profit association to which the main companies of the industry of the countries of the Old Continent refer. With his contribution, we trace an overview of the main issues affecting a world in rapid transition, called upon to deal already at present with complex issues such as the post-pandemic, the green breakthrough, the energy crisis, giving an authoritative voice to the members' requests in the highest institutional bodies of the European Union.
First, what do we need to know about EFCI, this important association serving cleaning and service companies?
EFCI is the European federation of the cleaning and facility management industry. Its members are business associations from 14 European countries, which together represent some 300,000 companies (of all sizes) employing more than four million workers. And precisely because of this representativeness at the national level, EFCI is recognized by the European Commission as a European social partner and participates, along with Euro-

pean sectoral trade unions, in social dialogue. This is an exclusive recognition, which grants EFCI, and the other organizations recognized in other industrial and economic sectors, an institutional legitimacy all their own. In parallel, there is in EFCI a mechanism for direct representation of individual companies, the Circle.
What is your role and what tasks have been assigned to you as Director General of the Federation?
I like to think of myself as the ears, eyes, voice and arm of the European cleaning industry here in Brussels: by monitoring legislative activity, I try to anticipate the direction of future European regulatory choices, and to understand their impact on the industry's development prospects; in the same context, I bring forward to European decision-makers the demands and needs of our world, thus enabling policymakers to have a greater awareness of the "technical" effects of the decisions they take, helping to improve legislative activity (in general) and to protect the interests of our members. In addition, I carry out constant coordination of the network of which our members are part, so as to ensure that the local specificities of each can be brought to the attention of European institutions. Lastly, I am responsible for the proper functioning of the association's "machine", overseeing communication activities, organization, and continuous structural reinforcement to allow for an ever-increasing visibility of the association and the fundamental social role of the cleaning sector.
For about a year now, the presidency has been taken over by Lorenzo Mattioli, who has a prestigious experience at the top of ANIP Confindustria and the Confindustria Federation behind him: what priority goals and commitments have been undertaken and carried out, and with what results?
President Mattioli - whose term of of-
fice was unanimously extended by one year at the last General Assembly - assumed the EFCI presidency at a time when, at the European level, the emergency of the health crisis was waning. The pandemic certainly made it possible to greatly increase awareness - at least on the part of the public - of the centrality of our work in ensuring the basic safety conditions essential for the conduct of life in the community. Our work - that of the workers and the entrepreneurs who employ them - has emerged from the condition of invisibility in which it has always lived; it is now necessary that this heightened social awareness be matched by consideration on the part of politicians and institutions. President Mattioli's program focuses precisely on this aspect - giving our sector the attention and consideration it deserves from European policy - through three main axes: improving market conditions for our companies through a revision of the provisions on public procurement, strengthening the attractiveness of the sector by working, among others, on the issue of skills, and finally accompanying the transformations taking place in the cleaning world - in terms of technology and environmental sustainability - by facilitating innovation (as, for example, in the case of daytime cleaning) without neglecting the protection of competitiveness. And I really believe that we can recognize the success - in terms of increased visibility - of this work, which has led EFCI to establish strong links with the world of politics and to be present in multiple institutional contexts - especially, with respect to the issue of public procurement.
Procurement reform and the minimum wage, the latter a highly debated and controversial topic, are some of the main issues and problems on the table…
Public procurement is one of the central themes of our program for the coming months, and up to the European
59 MARCH 2024
Matteo Matarazzo, EFCI Director General
elections. Serious work needs to be done first of all to change the conception, unfortunately widespread even at the institutional level, of public procurement as referring solely to the purchase of goods or the execution of public works. Specifically then, action must be taken on European legislation - which is a framework legislation, that is, one that sets some framework provisions within which states retain considerable decision - making autonomy to eliminate "upstream" some of the more pernicious provisions, for example relating to the prohibition of price revisions. Finally, it is essential to work to increase the professionalism of procurement procedures by creating a new "conscience" among government employees. The European legislation currently in force is summarized by the 2014 directives, which were drafted in a production context profoundly different from the current one of low inflation; after 10 years, we are confident that we will be able to touch the right buttons so that European policy understands and shares our demands. The minimum wage issue has occupied
the European social agenda for the past three years, creating - on one side and the other - exaggerated expectations and unjustified concerns. Since it is a directive, each country is called upon to find the most appropriate and compatible ways with its industrial relations system to introduce its provisions, which, it should be reiterated, do not set a minimum level valid for the whole of Europe and do not require the use of a law to implement the directive by November 2024. Here in Brussels, the issue of the minimum wage per se is no longer as hotly debated as it is in other countries, e.g., Italy; instead, the topic is being evoked in the context of discussions - increasingly frequent as the European elections approach - about what the next European Commission's approach should be in the area of social and employment policies.
How much is felt, in Europe, the need to keep the spotlight on the valuable work done by those working in the cleaning sector, making people understand the economic and social value of this industry?

If it refers to the institutional and business community sphere with which we interface regularly, unfortunately not as we would like, and as our work deserves. In our meetings with MEPs from all political families, we were able to experience firsthand how the recognition of the importance of our sector was not matched by a real knowledge of the reality of the sector - of its growing level of professionalism and technological specialization, for example - but rather by the persistence of some outdated and limited conceptions related to our work. Our work in Brussels is therefore all the more necessary.
Among the various initiatives undertaken by EFCI, we would like to mention the successful meeting on daytime cleaning practices in Europe: what are the main directions for change in the sector, which emerged from the discussion in the European context?
I am definitely very pleased with the success of our event, which allowed us - for the first time - to bring to the attention of a wider audience than the usual "insiders" such an important topic for us, and from a business perspective. Unquestionably, day labor represents one of the "dimensions" of which our way of working will be composed tomorrow - and in some countries already ours today; the advantages in terms of environmental, social, and improved working conditions are before everyone's eyes. But it would be counterproductive to conclude that this organizational model, because of the positive aspects it entails, should become the norm and thus be compulsorily "elevated" to the only possible organizational mode. It is our task to make all parties, including our clients, aware of the desirability of switching to the day labor model, assisting them when such a choice is made; but it is essential that this remains precisely a choice, the result of free contractual will.
60 MARCH 2024
EU OBSERVATORY


14-17 MAY 2024 THE WORLD’S MOST ADVANCED CLEANING AND HYGIENE SHOW intercleanshow.com/amsterdam 14 – 17 MAY 2024 AMSTERDAM, THE NETHERLANDS Organised by: Official media partner:
EL ROL DE EFCI EN LAS POLÍTICAS EUROPEAS
Entrevista con Matteo Matarazzo, Director General de EFCI, European Cleaning and Facility Services Industry, que tiene en Bruselas la misión de promover las necesidades y demandas del mundo empresarial de la limpieza y la gestión de instalaciones
Matteo Matarazzo, Director General de EFCI (European Cleaning and Facility Services Industry) desempeña en Bruselas la delicada y exigente tarea de ocuparse de la Dirección General de la Federación, a la que se remiten las principales empresas de la industria de los países del Viejo Continente. Con su autorizada y valiosa aportación, trazamos una panorámica de los principales temas que afectan a un mundo en rápida transición, llamado a abordar cuestiones complejas como la post-pandemia, el "giro" verde, la crisis energética y la innovación, dando voz autorizada a las peticiones de los asociados en las más altas instancias institucionales de la Unión Europea.
En primer lugar, presentemos la "tarjeta de visita" de EFCI. ¿Qué debemos saber sobre esta importante organización al servicio de las empresas de limpieza y servicios? EFCI es la federación europea del sector de
la limpieza y la gestión de instalaciones. Sus miembros son las asociaciones profesionales de 14 países europeos, que en conjunto representan a unas 300.000 empresas (de todos los tamaños) que dan empleo a más de cuatro millones de operarios. Y precisamente por esta representatividad a nivel nacional, EFCI está reconocida por la Comisión Europea como interlocutor social europeo y participa, junto con los sindicatos sectoriales europeos, en el diálogo social. Se trata de un reconocimiento exclusivo, que otorga a EFCI -y a las demás organizaciones patronales y sindicales reconocidas en los demás sectores industriales y económicosuna legitimidad institucional muy especial. Paralelamente, existe en EFCI un mecanismo de representación directa de las empresas individuales, el Círculo.
¿Cuál es su función y qué tareas se le han asignado como Director General de la Fe -
deración?
Me gusta pensar que soy los oídos, los ojos, la voz y el brazo de la industria europea de la limpieza aquí en Bruselas: mediante el seguimiento de la actividad legislativa, intento anticipar la dirección de las futuras opciones normativas europeas y comprender su impacto en las perspectivas de desarrollo de la industria; en el mismo contexto, transmito a los responsables europeos las peticiones y necesidades de nuestro mundo, lo que permite a losresponsables políticos ser más conscientes de los efectos "técnicos" de las decisiones que toman, contribuyendo a mejorar la actividad legislativa (en general) y a proteger los intereses de nuestros miembros. Además, coordino constantemente la red de la que forman parte nuestros miembros, para garantizar que las especificidades locales de cada uno de ellos puedan ser puestas en conocimiento de las instituciones europeas. Por último, soy responsable del buen funciona-
62 MARCH 2024
OBSERVATORIO EUROPEO
QUIÉN ES MATTEO MATARAZZO
Siciliano de origen y europeo por convicción, Matteo Matarazzo fue nombrado Director General de EFCI en diciembre de 2022. Estudió Relaciones Internacionales y Asuntos Europeos en Roma, Alemania y Reino Unido, y
actualmente posee un máster avanzado en Estudios Europeos por la Universidad Saint-Louis de Bruselas. Tras una experiencia inicial en el Departamento de Asuntos Sociales de la Comisión Europea, Matteo Matarazzo trabajó
para una asociación sectorial europea antes de convertirse en Director General de un interlocutor social europeo, desarrollando una sólida experiencia en asuntos sociales, políticas europeas y relaciones industriales.
miento de la "máquina" de la asociación, supervisando las actividades de comunicación, organización y refuerzo estructural continuo para permitir una visibilidad cada vez mayor de la asociación y del papel social fundamental del sector de la limpieza.
Desde hace aproximadamente un año, la presidencia ha sido asumida por Lorenzo Mattioli, que tiene a sus espaldas una prestigiosa experiencia al frente de ANIP Confindustria y de la Federación Confindustria: ¿qué objetivos y compromisos prioritarios se han asumido y llevado adelante, y con qué resultados?
El Presidente Mattioli - cuyo mandato fue prorrogado por unanimidad un año en la última Asamblea General - asumió la Presidencia de EFCI en un momento en el que, a nivel europeo, la emergencia de la crisis sanitaria estaba remitiendo. Sin duda, la pandemia ha aumentado considerablemente la conciencia - al menos por parte de la opinión pública - de la centralidad de nuestro trabajo a la hora de garantizar las condiciones básicas de seguridad indispensables para la vida en comunidad. Nuestro trabajo - el de los trabajadores y el de los empresarios que los emplean - ha salido de la condición de invisibilidad en la que siempre ha vivido; esta mayor conciencia social debe ir ahora acompañada de una consideración por parte de los políticos y las instituciones. El programa del Presidente Mattioli se centra precisamente en este aspecto -dar a nuestro sector la atención y consideración que merece por parte de la política europea - a través de tres ejes principales: mejorar las condiciones de mercado para nuestras empresas mediante una revisión de las disposiciones sobre contratación pública, reforzar el atractivo del sector trabajando, entre otras cosas, en la cuestión de las competencias y, por último, acompañar las transformaciones que se están produciendo en el mundo de la limpieza -en términos tecnológicos y de sostenibilidad medioambiental - facilitando la innovación (como en el caso de la limpieza diurna, por ejemplo) sin descuidar la protección de la competitividad. Y creo que podemos reconocer
el éxito -en términos de mayor visibilidad- de este trabajo, que ha llevado a EFCI a establecer fuertes vínculos con el mundo de la política y a estar presente en muchos contextos institucionales - especialmente en lo que respecta a la cuestión de la contratación pública.
La reforma de la contratación pública o el salario mínimo, un tema muy debatido y controvertido incluso en Italia, son algunos de los principales asuntos y problemas que están sobre la mesa.
La contratación pública es uno de los temas centrales de nuestro programa para los próximos meses, y hasta las elecciones europeas. En primer lugar, esnecesario trabajar seriamente para cambiar la concepción, desgraciadamente extendida también a nivel institucional, de que la contratación pública se refiere únicamente a la compra de bienes o a la realización de obras públicas. En concreto, hay que intervenir en la legislación europea -que es una legislación "marco", es decir, que establece ciertas disposiciones de referencia dentro de las cuales los Estados conservan una considerable autonomía de decisión- para eliminar preliminarmente ciertas disposiciones más perjudiciales, por ejemplo las relativas a la prohibición de revisión de precios. Por último, es imperativo trabajar para aumentar la profesionalidad de los procedimientos de concesión de contratos, creando una nueva "conciencia" entre los empleados de los poderes públicos. La legislación europea actualmente en vigor se resume en las directivas de 2014, que se redactaron en un contexto productivo profundamente diferente del actual de baja inflación; después de 10 años, confiamos en poder tocar los botones adecuados para que la política europea comprenda y comparta nuestras reivindicaciones. La cuestión del salario mínimo ha ocupado la agenda social europea durante los tres últimos años, creando -de un lado y de otro- expectativas y preocupaciones exageradas.
¿Hasta qué punto se percibe en el contexto europeo, tras la pandemia, la necesidad de mantener en el foco de atención el precioso
trabajo que realizan quienes ejercen en el sector de la limpieza?
Si se refiere a la comunidad institucional y empresarial con la que interactuamos habitualmente, lamentablemente no como nos gustaría y como merece nuestro trabajo. En nuestras reuniones con eurodiputados de todas las familias políticas, pudimos comprobar cómo el reconocimiento de la importancia de nuestro sector no iba acompañado de un conocimiento efectivo de la realidad del mismo, de su creciente nivel de profesionalización y especialización tecnológica, por ejemplo, sino más bien de la persistencia de ciertas concepciones anticuadas y limitadas de nuestro trabajo. Por ello, nuestra labor en Bruselas es aún más necesaria.
Entre las diversas iniciativas emprendidas por EFCI, nos gustaría mencionar el éxito de la reunión sobre prácticas de limpieza diurna en Europa: ¿cuáles son las principales orientaciones para el cambio en el sector que surgieron del debate en Europa? Definitivamente, estoy muy satisfecho con el éxito de nuestro evento, que nos permitió - por primera vez- llamar la atención de un público más amplio que el habitual de "iniciados" sobre un tema tan importante para nosotros, y desde una perspectiva empresarial. No cabe duda de que el trabajo diurno representa una de las "dimensiones" de las que se compondrá nuestra forma de trabajar mañana, y en algunos países ya es la nuestra hoy; las ventajas en términos de medio ambiente, sociedad y mejora de las condiciones de trabajo están a la vista de todos. Pero sería contraproducente concluir que este modelo organizativo, en virtud de los aspectos positivos que conlleva, debe convertirse en la norma y, por tanto, ser "elevado" obligatoriamente a único modo organizativo posible. Es nuestra tarea concienciar a todas las partes, incluidos nuestros clientes, de la conveniencia de pasar al modelo de trabajo diurno, y ayudarles cuando se haga tal elección; pero es indispensable que ésta siga siendo precisamente una elección, fruto de la libre voluntad contractual.
63 MARCH 2024
Improving public procurement
Major confrontation in Brussels between European social partner organizations of professional cleaning, private security and contract catering
Maurizio Pedrini
An important meeting was held at the end of 2023 in Brussels, where European organizations from the industrial cleaning, private security and catering sectors gathered to discuss the topic: "How to improve EU public procurement". This proved to be a valuable opportunity to discuss the current state of public procurement provisions within the European Union, their impact on the respective sectors and possible ways forward for future improvement. Indeed, the three sectors considered have significant common characteristics: they provide services that are critical to the safety, welfare and health of both people and businesses, following a labor-intensive model; they are intimately dependent on public customers. The meeting was attended by over sixty participants from different EU countries and sectors, eager to discuss, exchange information on the specific characteristics of their respective fields, and reflect on possible strategies and solutions to be

adopted in order to change a system so relevant to their work.
The role of public procurement
The event was opened by the speech of MEP Marie Pierre Vedrenne (Re-
new Europe), a member of the European Parliament's International and Employment Committees, who emphasized the role of public procurement as an engine for sustainable growth, inspired by the same princi-
64 MARCH 2024
EU OBSERVATORY
ples that underpin European social and economic models. The political representative of the European Union's highest representative institution also highlighted their strategic importance in the context of the EU's international positioning, pointing out the value and specific weight that labor-intensive service contracts assume in the context of the purchase of goods and the construction of works, contributing decisively to the realization of a more equitable and prosperous society. For all these reasons, Vedrenne emphasized the need to quickly address, without fear and procrastination, the main challenges associated with the implementation of the Directive, firstly including, the excessive dependence of public procurement on the lowest price as the main criterion-guide for awarding contracts, as well as the chronic lack of monitoring mechanisms by contracting authorities. This introduction was followed by the speeches of Valentina Caimi and Mathias Maucher, respectively, scientific coordinator of the Giacomo
Brodolini Foundation and coordinator of the Social Services Europe Project, brilliant co-authors of the interesting study-report, presented to the European Parliament, dedicated to the topic of the social impact of public procurement.
Critical issues and challenges
Lorenzo Mattioli, president of the European and Facility Services Industry (EFCI), highlighted the key role played by the cleaning industry in Europe in pulling society out of the pandemic. He then added: "The lowest price criterion is currently the main obstacle preventing companies from continuing to provide the highest standards of service and working conditions". Terje Mikkelsen , UNI Europe's vice president for private security services, presented, in a quick roundup, the main and demanding challenges facing the private security sector, focusing in particular on skills, proximity to sensitive activities, multiple security-related functions, working conditions, and the attractiveness of the same, especially to young people. Rocco Renaldi, sec-

retary general of FoodServiceEurope, reviewed the critical issues with which the foodservice sector has to deal on a daily basis, starting with the sharp increases in food costs; he also stressed the central dimension of the service provided, namely the importance of quality in nutrition.
Build a better future
The second part of the event featured two panel discussions. Representatives of the various sectors discussed how the current provisions in the Directive fail to ensure that quality is preferred over price. They discussed what initiatives have been put in place to date by national social partner organizations and the EU to fill the gaps, precisely to ensure that public procurement can best serve the interests of businesses, workers and end users. The focus of the second roundtable was to reflect on possible ways forward to improve the Directive, in view of the approaching deadline of the European elections scheduled for next year, while also examining possible initiatives that could be concretely taken at the respective national levels. All the speakers agreed on the main drivers for an effective and solid reorientation of the EU public procurement system: investing in the professionalization of agencies and business operators, at all levels; emphasizing the role of social dialogue and social partners, safeguarding their autonomy in the context of collective bargaining, whose involvement should in no way be seen as an obstacle to competition; the introduction of price increase mechanisms for contracts already awarded to allow the recovery of cost increases, also on the basis of indices developed by the sector. These are just some of the conclusions that emerged during the discussion, which are undoubtedly capable of offering an initial basis for considerations and insights that will certainly be developed further in the near future in European discussions.
65 MARCH 2024
MEJORAR LA CONTRATACIÓN PÚBLICA EN LA UE
Importante reunión en Bruselas entre organizaciones europeas de interlocutores sociales de los sectores de la limpieza industrial, la seguridad privada y la restauración colectiva
Afinales de año se celebró en Bruselas una importante reunión en la que las organizaciones europeas de los sectores de la limpieza industrial, la seguridad privada y la restauración colectiva se reunieron para debatir el tema: "Cómo mejorar la contratación pública en la Unión Europea". La reunión constituyó una valiosa oportunidad para debatir el estado actual de las disposiciones sobre contratación pública en la UE, su impacto en los respectivos sectores y las posibles vías de mejora en el futuro. De hecho, los tres sectores considerados presentan importantes características comunes: prestan servicios cruciales para la seguridad, el bienestar y la salud tanto de las personas como de las empresas, siguiendo un modelo intensivo en mano de obra; y dependen íntimamente de los clientes públicos. A el encuentro asistieron más de sesenta participantes, procedentes de distintos países y sectores de la UE, deseosos de debatir, intercambiar información sobre las características específicas de sus respectivos sectores y reflexionar sobre las posibles estrategias y soluciones a adoptar para cambiar un sistema tan relevante para su trabajo.
El papel de la contratación pública
El esperado acto fue inaugurado por la intervención de la eurodiputada Marie Pierre Vedrenne (Renew Europe), miembro de las Comisiones de Internacional y de Empleo del Parlamento Europeo, quien destacó el papel de la contratación pública como motor de crecimiento sostenible, inspirado en los mismos principios que sustentan los modelos sociales y económicos europeos. El representante político de la más alta institución representativa de la Unión Europea destacó también su importancia estratégica en el contexto del posicionamiento internacional de la UE, subrayando el valor y el peso específico que los contratos de servicios con gran intensidad de mano de obra asumen en el contexto de la compra de bienes y la construcción de obras, contribuyendo decisivamente a la realización de una sociedad más justa y próspera. Por todas estas razones, el Sr. Vedrenne insistió en la necesidad de enfrentarse rápidamente, sin miedo y sin demora, a los principales retos relacionados con la aplicación de la Directiva, entre los que se encuentran, en primer lugar, la excesiva dependencia de la contratación pública del precio más bajo como principal criterio de adjudicación, así como la
falta crónica de mecanismos de control por parte de los organismos adjudicadores. A esta oportuna introducción siguieron las intervenciones de Valentina Caimi y Mathias Maucher, respectivamente coordinadora científica de la Fundación Giacomo Brodolini y coordinador del Proyecto Servicios Sociales Europa, brillantes coautores del interesante estudio-informe, presentado al ParlamentoEuropeo, dedicado al tema del impacto social de la contratación pública.
Cuestiones críticas y retos
Lorenzo Mattioli, presidente de EFCI (European and Facility Services Industry), la asociación europea que representa a unas 300.000 empresas y más de 4 millones de trabajadores, destacó el rol fundamental que desarrolla la industria de la limpieza en Europa, para salir de la pandemia. Añadió que "el criterio del precio más bajo es actualmente el principal obstáculo que impide a las empresas seguir ofreciendo los niveles más elevados de servicio y de condiciones de trabajo". Terje Mikkelsen , Vicepresidente de UNI Europa para los servicios de seguridad privada, hizo un rápido repaso de los principales y exigentes retos a los que se enfrenta el sector de la seguridad privada, centrándose en particular en las competencias, la cercanía a actividades sensibles, las múltiples funciones relacionadas con la seguridad, las condiciones de trabajo y el atractivo del sector, especialmente para los jóvenes. Rocco Renaldi, Secretario General de FoodServiceEurope, examinó los problemas críticos a los que debe hacer frente a diario el sector de la restauración, empezando por el fuerte aumento de los costes de los alimentos; también hizo hincapié en la dimensión central del servicio prestado, es decir, la importancia de la calidad en la alimentación.
Construir un futuro mejor
La segunda parte del evento contó con dos mesas redondas. Representantes de los distintos sectores debatieron cómo las disposiciones actuales de la Directiva no garantizan que se dé preferencia a la calidad sobre el precio. Debatieron qué iniciativas han tomado hasta ahora las organizaciones nacionales de interlocutores sociales y la UE para colmar las lagunas y garantizar que la contratación pública pueda servir mejor a los intereses de las empresas, los trabajadores y los usuarios finales. En el centro de la segunda mesa redonda estuvo la reflexión sobre las posibles vías para mejorar la Directiva, en vista de la proximidad de las elecciones europeas previstas para el próximo año, examinando también las posibles iniciativas que podrían adoptarse concretamente en los respectivos niveles nacionales. Todos los oradores coincidieron en los principales motores de una reorientación eficaz y sólida del sistema de contratación pública de la UE: investire sulla professionalizzazione delle agenzie e degli operatori del settore, ai vari livelli; enfatizzare il ruolo del dialogo sociale e delle parti sociali, salvaguardando la loro autonomia nel contesto della contrattazione collettiva, il cui coinvolgimento non deve in alcun modo essere visto come un ostacolo alla concorrenza; l’introduzione di meccanismi di aumento dei prezzi degli appalti già aggiudicati per consentire il recupero degli aumenti dei costi, anche sulla base di indici elaborati dal settore. Queste sono solo alcune delle conclusioni emerse nel corso della discussione, capaci senz’altro di offrire una prima base di considerazioni e spunti che saranno certamente sviluppati ulteriormente in un prossimo futuro in sede di confronto europeo.
66 MARCH 2024
OBSERVATORIO EUROPEO

THE TRADE MAGAZINE DEDICATED TO PROFESSIONAL CLEANING OPERATORS


UPDATED
SUBSCRIBE NOW!
STAY
WITH US
EMPOWERING MINDS uine
On the market today
Hoy En El Mercado
Technology, research, development: the latest news from the cleaning world
Loredana Vitulano
4 CLEANPRO SRL
4cleanpro.com
4CleanPro has twenty years of experience in the world of industrial cleaning. The machines are manufactured with high quality components with spare parts that can be ordered from website: 4cleanpro.com
4CleanPro cuenta con veinte años de experiencia en el mundo de la limpieza industrial. Las máquinas están fabricadas con componentes de alta calidad con repuestos que se pueden pedir desde el sitio web: 4cleanpro.com
ADIATEK SRL
adiatek.com
Adiatek is an italian company which designs and manufactures walkbehind, ride-on and autonomous floor scrubber dryer machines. They are efficient and high-performance machines, with an innovative design. Adiatek es una empresa italiana que produce fregadoras-secadoras de pisos hombre a pie y a bordo (a conducción autónoma también). Son maquinas funcionales, de alto rendimiento, con un deseño novedoso.
MIRA ERGO 40. Small but strong
The MIRA ERGO 40 presents itself in a new handle that offers a greater lever arm and makes it lighter to drive. 5 liter recovery tank with quick release. The lower part remains unchanged.
MIRA ERGO 40. Pequeña pero fuerte
Le MIRA ERGO 40 se presenta con un nuevo mango que ofrece mayor apalancamiento y hace que la conducción sea más ligera. Depósito de recuperación de 5 litros con cierre rápido. La parte inferior se mantiene sin cambios.

R-Quartz autonomous scrubber machine
R-Quartz, safe and with high cleaning performance, is the first autonomous scrubber developed by Adiatek. It has two learning modalities, three safety systems and a simple interface. Thanks to Telematics (telemetry) it is possible to check the machine functions and productivity from your smartphone.
R-Quartz fregadora de pavimentos a guía autónoma
R-Quartz, segura y con alto rendimiento de limpieza, es la primera fregadora a conducción autónoma fabricada por Adiatek. Tiene dos modalidades de aprendizaje y tres sistemas de seguridad. Gracias al Telematics es posible controlar las funciones de la máquina y la productividad desde el móvil.

68 MARCH 2024
PRODUCT REVIEW

COMAC SPA
comac.it
For 50 years Comac has been designing machines for professional floor cleaning including floor scrubbers, sweepers, single disc machines, vacuum cleaners, high pressure washers and sanitizers able to solve cleaning issues in different conditions of use and on any type of surface.
Desde 50 años Comac diseña máquinas para la limpieza profesional de los pavimentos entre las que se incluyen fregadoras, barredoras, monocepillos, aspiradoras, hidrolimpiadoras y equipos para desinfección capaces de resolver los problemas de limpieza en diferentes condiciones de uso y en cualquier tipo de superficie.

C120 new sweeping-scrubbing system
C120 is the new Comac’s ride-on industrial floor scrubber, fully equipped for every cleaning task. Unique in its kind thanks to the new sweeping-scrubbing system, that consists of a pre-sweeping unit with two side brushes and two cylindrical brushes followed by a scrubbing unit with three disc brushes to guarantee optimum performance in every situation.
C120 nuevo sistema de barrido-lavado
C120 es la nueva fregadora de pavimentos industrial hombre a bordo Comac, perfectamente equipada para cualquier operación de limpieza. Única en su génere gracias al nuevo sistema de barrido-lavado, que consta de un grupo de prebarrido equipado con dos cepillos laterales y dos cepillos cilíndricos, seguido de un grupo de lavado dotado de tres cepillos de disco para garantizar prestaciones óptimas en cada actividad de limpieza.
FALPI SRL
falpi.com
Falpi was founded in 1987 and its factory is located in Ponzone, (Piemonte, north of Italy). From the very beginning the company wanted to bring innovation to the world of professional cleaning equipment. Thanks to a young and motivated team, after more than 35 years Falpi continues to improve and has added a precious quality: experience in cleaning problems that we are used to solving quickly and effectively.
Falpi se fundó en 1987 y su fábrica se encuentra en Ponzone, (Piamonte, norte de Italia). Desde el principio, la empresa quiso aportar innovación al mundo de los equipos de limpieza profesional. Gracias a un equipo joven y motivado, después de más de 35 años Falpi sigue mejorando y ha añadido una cualidad preciosa: la experiencia en problemas de limpieza que estamos acostumbrados a resolver con rapidez y eficacia.
SERVICE BAR
High-end hospitality is one of the most important stages in this respect. Falpi, in order to adapt to the most prestigious spaces, has created the range of hotel trolleys in the SOlight Housekeeping line. The Service Bar trolley makes it possible to organise the restoration of the minibar in an impeccable, discreet and orderly manner. All trolleys in Falpi's SOlight Housekeeping line are fully customisable according to the hotel's needs through the new Falpi Configurator (www. falpi.com/it/configurator/ solight).
SERVICE BAR

La hostelería de alto nivel es una de las etapas más importantes en este sentido. Falpi, para adaptarse a los espacios más prestigiosos, ha creado la gama de carros de hotel de la línea SOlight Housekeeping. El carro Service Bar permite organizar la restauración del minibar de forma impecable, discreta y ordenada. Todos los carros de la línea SOlight Housekeeping de Falpi son totalmente personalizables según las necesidades del hotel a través del nuevo Configurador Falpi (www.falpi.com/it/configurator/ solight).
69 MARCH 2024

FIMAP SPA
fimap.com
Fimap designs and manufactures floor cleaning machines in Italy and exports them to 80 countries worldwide. The range includes scrubbing machines, autonomous scrubber dryers, sweeper-scrubbers, sweeping machines, dry and wet&dry vacuum cleaners, spray-extraction cleaners, and single disc machines able to meet any kind of cleaning need, equipped with innovative technological solutions that enable to achieve high hygiene standards respecting the environment.
Fimap diseña y fabrica máquinas para la limpieza de suelos en Italia y las exporta a 80 países de todo el mundo. La gama incluye fregadoras, fregadoras autónomas, barredoras-fregadoras, barredoras, aspiradores en seco y en húmedo y seco, lava-aspiradores y máquinas monocepillo, capaces de satisfacer cualquier tipo de necesidad de limpieza, equipadas con soluciones tecnológicas innovadoras que permiten alcanzar altos estándares de higiene respetando el medio ambiente.

CB-1 autonomous floor scrubber
CB-1 is the autonomous technology that helps professionals improve cleaning productivity. While CB-1 deals with timeconsuming and repetitive activities such as routine cleaning of large, hightraffic floors in warehouses, airports, shopping centres, supermarkets and schools, specialized staff can save valuable time to take care of more demanding tasks. Its ease of programming and use makes the CB-1 the ideal ally for improving cleaning performance.
Fregadora de pavimentos autónoma CB-1
CB-1 es la tecnología autónoma de Fimap que ayuda a los profesionales a mejorar la productividad de las operaciones de limpieza. Mientras que CB-1 se encarga de la limpieza rutinaria de suelos grandes y muy transitados en almacenes, aeropuertos, centros comerciales, supermercados y escuelas, el personal especializado puede ocuparse de tareas más exigentes. La sencillez con la que se programa y utiliza convierte a la CB-1 en el aliado ideal para mejorar el rendimiento de los proyectos de limpieza.
PAPERDI SRL
paperdi.it
Paperdi manufactures and distributes Tissue Paper for hygienic, sanitary, cleaning and industrial application. The company thanks to the integrated cycle, realizes products with high quality of raw materials and offers a range of products made of pure cellulose and recycled paper: Kitchen and Hand towels rolls, Medical rolls, Toilet paper, Interlfolded handtowels.
Paperdi fabrica y distribuye papel tissue para uso higiénico, sanitario e industrial. La empresa gracias al ciclo integrado realiza productos de alta calidad de materias primas y ofrece una gama de productos hechos de pura celulosa y papel reciclado: rollos de cocina, rollos médicos, papel higiénico, secamanos en V, Z, W.

Respect for the environment
Paperdi has done every effort with enthusiasm to grow strongly and healthy with great respect for the environment and of the stakeholders. With the launch of V fold handtowel Paperdi has summarized these two values. A product 100% sustainable and recyclable from the sheets to the paper packaging (no more in plastic ) to the carton. A product that facilitates the dispenser recharge process and helps the operator to do his work in a faster way, using only one garbage to dispose of the waste.
Respeto por el ambiente
Paperdi ha hecho todo su esfuerzo con entusiasmo para crecer fuerte y con gran respeto por el ambiente y todas las partes interesadas. Con el lanzamiento de toalla plegable V Paperdi ha combinado estos dos valores. Un producto 100% sostenible y reciclable desde las toallas, al embalaje de papel (no más en plástico) a la caja. Un producto que facilita el proceso de recarga del dispensador y ayuda al operador a hacer su trabajo de una manera más rápida, utilizando sólo un basurero para deshacerse de los residuos.
70 MARCH 2024
PRODUCT REVIEW

PAREDES
paredes.it
Paredes, inventor of autocut and disposable hand drying, was founded in 1942, expanding to Italy in 1988. Today it has grown to 15 branches, 2 cellulose transformation sites, 1 soap production laboratory, 100,000m² of warehouse space and 650 employees for its more than 25,000 customers.
Paredes, inventor del corte automático y el secado desechable, se fundó en 1942 y dio sus primeros pasos en territorio italiano en 1988. Hoy cuenta con 15 sucursales, 2 centros de procesamiento de guata, 1 laboratorio de producción de jabón, 100.000 m² de almacenes y 650 colaboradores para su más de 25.000 clientes.

RUBINO CHEM SRL
rubinochem.it
Rubino Detergenti was born in 1960 from an idea of Antonio Rubino and evolved with the passion and professionalism of his son Luigi, the current sole director, starting in 2002, when it became Rubino Chem. An important company in the national chemical sector, Rubino Chem has been able to diversify and offer quality products for professional and industrial use.
Rubino Detergenti nació en 1960 de una idea de Antonio Rubino y evolucionó con la pasión y profesionalidad de su hijo Luigi, actual administrador único, a partir de 2002, cuando se convirtió en Rubino Chem. Importante empresa del sector químico nacional, Rubino Chem ha sabido diversificarse y ofrecer productos de calidad para uso profesional e industrial.


Paredis Elite, reliability, comfort and hygiene
The exclusive Paredis Elite, autocut dispenser with a ceramic blade, guarantees reliability, comfort and hygiene.
With its modern design and elegance that facilitates cleaning and maintenance, the champagne collection is synonymous of luxury and elegance; it satisfies the exclusive needs of luxury segments and those that want to elevate the experience of collaborators and users.
Paredes Elite, fiabilidad, comodidad e higiene
El exclusivo cortador automático Paredes Elite con cuchilla cerámica, garantiza fiabilidad, comodidad e higiene. Con un diseño moderno y elegante, que facilita la limpieza y el mantenimiento, la colección champán, sinónimo de lujo y elegancia, satisface las necesidades más exclusivas del sector del lujo y de quienes quieren elevar la experiencia de colaboradores y usuarios.
Olè Ressenza. Polyfunctional formulation
Olè Ressenza is the new brand identifying the highly concentrated polyfunctional formulation with strong sanitizing action and neutral pH used to cleanse, remove germs and bacteria with mechanical action, dust, perfume and deodorize environments and surfaces. The Olè Ressenza formulation was designed to meet the needs of professional users.
Olè Ressenza. Formulación polifuncional
Olè Ressenza es la nueva marca que identifica la formulación polifuncional altamente concentrada con fuerte acción higienizante y pH neutro utilizada para limpiar, eliminar gérmenes y bacterias con acción mecánica, desempolvar, perfumar y desodorizar ambientes y superficies. La formulación Olè Ressenza ha sido diseñada para satisfacer las necesidades de los usuarios profesionales.
71 MARCH 2024

Some practical tips based on emotional intelligence and nonverbal communication to cope with disrespectful customers

Rude customers: what to do?
In any business context, it is inevitable to encounter rude or dissatisfied customers. To deal with such situations, it becomes crucial to develop Relational Intelligence as a fundamental tool. In this article we will explore some practical tips based on the principles of emotional intelligence and NVC (Nonviolent Communication) to deal with disrespectful customers, referring to experts in this field such as Paul Ekman and Marshall Rosenberg. First, let’s try to answer this question: why would a customer behave rudely during a purchase?
There may be several reasons why a customer might behave rudely. Here are some possible explanations:
1. Frustration or disappointment: the customer may be frustrated or disappointed by past experiences with your business or other companies. He or she
may have faced product quality problems, delayed delivery times, or poor customer service. These negative experiences might make him react rudely from the start (this is called prejudice).
2. External pressures: the customer may find himself under pressure due to external factors such as deadlines, limited budgets, or unrealistic expectations. These factors can cause stress and tension, leading the client to behave rudely.
3. Lack of effective communication: customers may become frustrated if they cannot communicate their needs effectively or if they are not understood correctly. This could lead to increased tension and the manifestation of rude behavior as a means of asserting their demands.
4. Personal problems: it is possible that the customer is dealing with personal
problems or stressful situations outside the context of the purchase. These problems may affect his emotional state and cause rude reactions that may be directed toward the sales staff.
5. Unmet Expectations: the customer may have unrealistic expectations about the product or service he wishes to purchase. If these expectations are not met, one may feel disappointed and react rudely.
What to do. Some suggestions
Here are some concrete suggestions that work:
1. Keep calm: remember that emotional reactions could make the situation worse. Breathe deeply and be aware of your feelings before responding.
2. Show empathy: try to understand why the customer might be rude (as an-
72 MARCH 2024
Marco Monti
Fabrizio Pirovano
MARKETING
ticipated above): he might be frustrated or dissatisfied for some reason. Listen carefully to one’s complaints and show that you care about one’s problem.
3. Don’t take things personally: remember that the customer’s rude behavior may not be directed at you personally, but may be a reaction to a situation or a problem. Avoid responding with rudeness or arrogance, blaming the customer in return.
4. Always maintain a professional tone: respond calmly and respectfully, even if the customer becomes increasingly rude (within the limits of your own safety...). Use clear, assertive language to communicate your point of view, perhaps pointing out that you are uncomfortable with that attitude. Avoid falling to his level and responding with rudeness or aggression.
5. Offer solutions: try to solve the cus-
tomer’s problem by offering practical solutions. Offer alternatives or suggestions that can meet his needs. If you are unable to solve the problem directly, make sure to involve a manager or supervisor who can help.
6. Set limits: if the customer continues to be disrespectful or rude despite your efforts to help, it is important to set limits. Make it clear to the customer that you will not tolerate inappropriate behavior and, if necessary, consider breaking off the conversation or ending the transaction.
7. Take note and report: taking notes on the details and circumstances surrounding the interaction that occurred with the rude customer can be helpful in reporting the incident to your supervisor or manager. This can help to resolve the problem and prevent similar situations in the future.
8. Take care of yourself: dealing with customers like this can be stressful. Be sure to take time for yourself, manage stress and find healthy ways to relax after a difficult interaction.
What to do if you become angry with the client?
Managing your anger in the face of provocative and unhinged customer behavior can be a challenge, but it is important to do so to maintain professionalism and ensure an appropriate response to the situation. Here are some brief tips on how to manage anger in these circumstances:
1. Become aware of your emotions: acknowledge and accept the fact that you are experiencing anger. Being aware of your emotions is the first step to manage them effectively.
2. Breathe deeply: before responding to the client, take a moment to breathe deeply. This can help you calm down and restore emotional balance.
3. Focus on solving the problem: focus on solving the customer’s problem rather than the customer’s rude behavior. Keep your focus on the issue at hand and the actions needed to find a solution.
4. Take a break if necessary: if the situation becomes too intense and you feel like you are losing control, consider taking a short break. You can ask the client to wait a moment while you consult with a colleague or supervisor to handle the situation appropriately.
Conclusions
It is essential to understand that the client’s rude behavior does not reflect you as an individual; often, the client’s behavior is related to specific frustrations or dissatisfactions, not referable to you as an individual.
Learning, therefore, not to take things personally and to maintain a detached and professional attitude is the only way to succeed and to respect the saying “The customer is always right” that you often hear in sales.
73 MARCH 2024
CLIENTES MALEDUCADOS: ¿QUÉ HACER?
Algunos consejos prácticos basados en la inteligencia emocional y la comunicación no verbal para tratar con clientes irrespetuosos
En cualquier sector es inevitable encontrarse con clientes maleducados o insatisfechos. Para hacer frente a estas situaciones, resulta crucial desarrollar la Inteligencia Relacional como herramienta fundamental. En este artículo exploraremos algunos consejos prácticos basados en los principios de la inteligencia emocional y la CNV (comunicación no violenta) para tratar con clientes irrespetuosos, haciendo referencia a expertos en este campo como Paul Ekman y Marshall Rosenberg. En primer lugar, tratemos de responder a esta pregunta: ¿por qué debería un cliente comportarse de forma grosera durante una compra, siendo ésta su necesidad? Puede haber varias razones por las que un cliente se comporte de forma grosera. He aquí algunas posibles explicaciones:
1.Frustración o decepción: El cliente puede sentirse frustrado o decepcionado por experiencias anteriores con su sector o con otras empresas. Puede que se haya enfrentado a problemas de calidad del producto, retrasos en los plazos de entrega o un mal servicio de atención al cliente. Estas experiencias negativas pueden hacerle reaccionar de forma grosera desde el principio (lo que se denomina prejuicio).
2. Presiones externas: El cliente puede estar bajo presión debido a factores externos como plazos de entrega, presupuestos limitados o expectativas poco realistas. Estos factores pueden causar estrés y tensión, llevando al cliente a comportarse de forma grosera.
3. Falta de comunicación eficaz: El cliente puede sentirse frustrado si no puede comunicar
sus necesidades de forma eficaz o si no se le entiende correctamente. Esto puede provocar un aumento de la tensión y el despliegue de un comportamiento grosero como medio para hacer valer sus demandas.
4. Problemas personales: Es posible que el cliente se enfrente a problemas personales o situaciones estresantes fuera del contexto de la compra. Estos problemas pueden afectar a su estado emocional y provocar reacciones groseras que pueden dirigirse hacia el personal de ventas.
5. Expectativas insatisfechas: El cliente puede tener expectativas poco realistas sobre el producto o servicio que desea adquirir. Si estas expectativas no se cumplen, puede sentirse decepcionado y reaccionar de forma grosera.¿Qué se puede hacer? Algunas sugerencias.
He aquí algunas sugerencias concretas que funcionan:
1. Mantén la calma : recuerda que las reacciones emocionales pueden empeorar la situación. Respira profundamente y sé consciente de tus sentimientos antes de responder.
2. Muestra empatía : Intenta entender por qué el cliente puede ser grosero (como se ha dicho antes): puede que esté frustrado o insatisfecho por algún motivo. Escucha atentamente sus quejas y demuestra que te importa su problema.
3. No te lo tomes como algo personal: recuerda que el comportamiento grosero del cliente puede que no vaya dirigido a ti personalmente, sino que sea una reacción a una situación o problema. Evita responder con grosería o arrogancia, culpando a su vez al cliente.
4. Mantenga siempre un tono profesional: responda con calma y respeto, incluso si el cliente se vuelve cada vez más grosero (dentro de los límites de su propia seguridad...). Utiliza un lenguaje claro y asertivo para comunicar tu punto de vista, quizá señalando que te sientes incómodo con esa actitud. Evita descender a su nivel y responder con grosería o agresividad.
5. Ofrezca soluciones: Intenta resolver el problema del cliente ofreciéndole soluciones prácticas. Propón alternativas o sugerencias que satisfagan sus necesidades. Si no puedes resolver el problema directamente, asegúrate de involucrar a un gerente o supervisor que pueda ayudarte.
6. Establezca límites: si el cliente sigue siendo irrespetuoso o grosero a pesar de sus esfuerzos por ayudarle, es importante que establezca límites. Deje claro al cliente que no tolerará comportamientos inadecuados y, si es necesa-
rio, considere la posibilidad de poner fin a la conversación o a la transacción.
7. Tome nota e informe: tomar nota de los detalles y circunstancias que rodean la interacción con el cliente maleducado puede ser útil para informar del incidente a su supervisor o jefe. Esto puede ayudar a resolver el problema y evitar situaciones similares en el futuro.
8. Cuídate: Tratar con clientes así puede ser estresante. Asegúrate de dedicarte tiempo a ti mismo, controlar el estrés y encontrar formas saludables de relajarte después de una interacción difícil.
¿Qué hacer si te enfadas con el cliente?
Controlar el enfado ante un comportamiento provocador y antipático de un cliente puede ser un reto, pero es importante hacerlo para mantener laprofesionalidad y garantizar una respuesta adecuada a la situación. He aquí unos breves consejos sobre cómo gestionar la ira en estas circunstancias:
1. Sea consciente de sus emociones: Reconozca y acepte el hecho de que está experimentando ira. Ser consciente de tus emociones es el primer paso para gestionarlas eficazmente.
2. Respire profundamente: Antes de responder al cliente, tómese un momento para respirar profundamente. Esto puede ayudarte a calmarte y restablecer el equilibrio emocional.
3. Céntrate en resolver el problema : Céntrate en resolver el problema del cliente y no en su comportamiento grosero. 4. Mantén la atención en el asunto en cuestión y en las acciones necesarias para encontrar una solución.
4. Tómate un descanso si es necesario: Si la situación se vuelve demasiado intensa y sientes que estás perdiendo el control, considera la posibilidad de tomarte un breve descanso. Puedes pedir al cliente que espere un momento mientras consultas con un colega o supervisor para manejar la situación adecuadamente.
En conclusión
Es esencial darse cuenta de que el comportamiento grosero del cliente no te refleja a ti como individuo; a menudo, el comportamiento del cliente está relacionado con frustraciones o insatisfacciones específicas, no contigo como individuo. Por lo tanto, aprender a no tomarse las cosas como algo personal y a mantener una actitud distante y profesional es la única forma de tener éxito y de respetar el dicho "el cliente siempre tiene razón" que se oye a menudo en las ventas.
74 MARCH 2024
MARKETING


choose to be choose www . falpi . com

 Soluzioni d’igiene e di protezione professionale
Soluzioni d’igiene e di protezione professionale






























 CEO Giubilesi & Associati
CEO Giubilesi & Associati